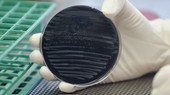
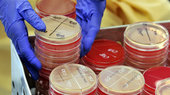
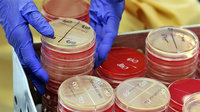

Von Leib und Seele
Gesundheit, der Volksmund sagt es, ist bekanntlich das Wichtigste. Deswegen startet in der „Schwäbischen Zeitung“ die große Gesundheits-Serie „Von Leib und Seele“.
In der 24-teiligen Reihe werden neben Krankheiten, wie Adipositas, Diabetes oder Alzheimer, auch die neuesten wissenschaftlichen Erkenntnisse zu Viren und anderen Infektionskeimen beleuchtet.
Ein Storytelling von Claudia Kling und Ingrid Augustin
In der 24-teiligen Reihe werden neben Krankheiten, wie Adipositas, Diabetes oder Alzheimer, auch die neuesten wissenschaftlichen Erkenntnisse zu Viren und anderen Infektionskeimen beleuchtet.
Ein Storytelling von Claudia Kling und Ingrid Augustin
Inhalt
Impressum
Autoren
Claudia Kling / Dominik Prandl / Daniel Hadrys / Barbara Waldvogel / Katja Waizenegger / Katja Korf / Ingrid Augustin / Karin Geupel / Christin Hartard / Andreas Knoch / Dirk Grupe / Mark Hänsgen / Michael Hescheler
Fotos / Grafiken / Videos: Colourbox, dpa, imago, privat
Grafiken & Karten: Christian Schellenberger, Simon Haas, Ingrid Augustin, Johanna Jani
Video: Simon Haas
Redaktion
Ingrid Augustin
Kontakt
www.schwäbische.de
Karlstraße 16
88212 Ravensburg
Telefon: 0751 / 2955 5555
online@schwaebische.de
Copyright
Schwäbische Zeitung 2017 - alle Rechte vorbehalten
Claudia Kling / Dominik Prandl / Daniel Hadrys / Barbara Waldvogel / Katja Waizenegger / Katja Korf / Ingrid Augustin / Karin Geupel / Christin Hartard / Andreas Knoch / Dirk Grupe / Mark Hänsgen / Michael Hescheler
Fotos / Grafiken / Videos: Colourbox, dpa, imago, privat
Grafiken & Karten: Christian Schellenberger, Simon Haas, Ingrid Augustin, Johanna Jani
Video: Simon Haas
Redaktion
Ingrid Augustin
Kontakt
www.schwäbische.de
Karlstraße 16
88212 Ravensburg
Telefon: 0751 / 2955 5555
online@schwaebische.de
Copyright
Schwäbische Zeitung 2017 - alle Rechte vorbehalten
Wie wird man gesund alt?
„Man muss dem Gehirn immer wieder etwas Neues vorsetzen“Die Gesundheitsexpertin und Ärztin Dr. Marianne Koch zur Frage, wie man Körper und Geist gesund erhält
Von Claudia Kling
Gesundheit bis ins hohe Alter – das wünschen sich die meisten Menschen, aber viele tun zu wenig dafür. Die Gesundheitsexpertin Dr. med. Marianne Koch erklärt, warum körperliche und geistige Fitness, die Ernährung und ein Blick in die eigene Familie so wichtig sind. „Gesundheit ist eine Mischung zwischen Gnade und Wissen, auch Konsequenz“, sagt Marianne Koch im Interview mit Claudia Kling. Und sie empfiehlt, zu einem Arzt zu gehen, der bereit ist, zuzuhören und über die Probleme des Patienten zu sprechen.
Gesundheit bis ins hohe Alter – das wünschen sich die meisten Menschen, aber viele tun zu wenig dafür. Die Gesundheitsexpertin Dr. med. Marianne Koch erklärt, warum körperliche und geistige Fitness, die Ernährung und ein Blick in die eigene Familie so wichtig sind. „Gesundheit ist eine Mischung zwischen Gnade und Wissen, auch Konsequenz“, sagt Marianne Koch im Interview mit Claudia Kling. Und sie empfiehlt, zu einem Arzt zu gehen, der bereit ist, zuzuhören und über die Probleme des Patienten zu sprechen.
Gesundheit ist eine Mischung zwischen Gnade und Wissen
Gesundheit ist eine Mischung zwischen Gnade und Wissen

„Auch mit 80 ist es möglich, etwas Neues zu lernen“, sagt die Ärztin Marianne Koch. Lebenslanges Lernen schütze sogar vor Alzheimer. Foto: Isolde Ohlbaum
Vollbild
Frau Koch, was haben Sie heute schon für Ihre Gesundheit getan?
Ich fürchte, nicht sehr viel. Ich habe mich heiß und kalt geduscht, immerhin, das ist eine Anregung fürs Immunsystem. Und ich habe grünen Tee getrunken. Dazu, was ich sonst täglich mache, nämlich mit meinem Hund spazieren zu gehen und mediterran zu kochen, bin ich heute noch nicht gekommen. Das hole ich heute Abend nach.
Haben Sie sich selbst tägliche Gesundheitspflichten auferlegt?
Nein, überhaupt nicht. Ich halte mich im Prinzip an die Dinge, die ich auch anderen Menschen empfehle und die auch machbar sind. Ich bin ein viel zu chaotischer Mensch, um mich strengen Pflichten zu unterwerfen. Aber ich achte auf gesunde Ernährung: viel Gemüse und Obst, Fleisch und Fisch in Maßen. Süßigkeiten mag ich sowieso nicht, und Industrienahrung kommt bei mir nicht auf den Tisch. Aber ich bin nicht so diszipliniert, wie ich vielleicht aussehe.
Der Traum der meisten Menschen ist es, gesund bis ins hohe Alter zu sein. Ist Gesundheit ein Verdienst oder eine Gnade?
Gesundheit ist eine Mischung zwischen Gnade und Wissen, auch Konsequenz. Das heißt, einerseits sind gute Gene eine wichtige Voraussetzung, um gesund zu bleiben, andererseits müssen aber gerade ältere Menschen berücksichtigen, dass sie meist nicht ohne Mühe oder Bemühung gesund alt werden. Neben einer gesunden Ernährung und Bewegung ist auch Muskeltraining ganz wichtig, weil es vor Gebrechlichkeit schützt. Zudem sollte man seinen Blutdruck und sein Cholesterin auf Normalwerte regulieren und etwas für seine Seele und seinen Geist tun. Es hat sich herausgestellt, dass lebenslanges Lernen sogar vor Alzheimer schützt. Man muss dem Gehirn immer wieder etwas Neues vorsetzen, um diese Hunderte Milliarden Verbindungspunkte zwischen den einzelnen Gehirnzellen aufrechtzuerhalten oder sie vielleicht sogar zu vermehren.
Ich fürchte, nicht sehr viel. Ich habe mich heiß und kalt geduscht, immerhin, das ist eine Anregung fürs Immunsystem. Und ich habe grünen Tee getrunken. Dazu, was ich sonst täglich mache, nämlich mit meinem Hund spazieren zu gehen und mediterran zu kochen, bin ich heute noch nicht gekommen. Das hole ich heute Abend nach.
Haben Sie sich selbst tägliche Gesundheitspflichten auferlegt?
Nein, überhaupt nicht. Ich halte mich im Prinzip an die Dinge, die ich auch anderen Menschen empfehle und die auch machbar sind. Ich bin ein viel zu chaotischer Mensch, um mich strengen Pflichten zu unterwerfen. Aber ich achte auf gesunde Ernährung: viel Gemüse und Obst, Fleisch und Fisch in Maßen. Süßigkeiten mag ich sowieso nicht, und Industrienahrung kommt bei mir nicht auf den Tisch. Aber ich bin nicht so diszipliniert, wie ich vielleicht aussehe.
Der Traum der meisten Menschen ist es, gesund bis ins hohe Alter zu sein. Ist Gesundheit ein Verdienst oder eine Gnade?
Gesundheit ist eine Mischung zwischen Gnade und Wissen, auch Konsequenz. Das heißt, einerseits sind gute Gene eine wichtige Voraussetzung, um gesund zu bleiben, andererseits müssen aber gerade ältere Menschen berücksichtigen, dass sie meist nicht ohne Mühe oder Bemühung gesund alt werden. Neben einer gesunden Ernährung und Bewegung ist auch Muskeltraining ganz wichtig, weil es vor Gebrechlichkeit schützt. Zudem sollte man seinen Blutdruck und sein Cholesterin auf Normalwerte regulieren und etwas für seine Seele und seinen Geist tun. Es hat sich herausgestellt, dass lebenslanges Lernen sogar vor Alzheimer schützt. Man muss dem Gehirn immer wieder etwas Neues vorsetzen, um diese Hunderte Milliarden Verbindungspunkte zwischen den einzelnen Gehirnzellen aufrechtzuerhalten oder sie vielleicht sogar zu vermehren.

„Auch mit 80 ist es möglich, etwas Neues zu lernen“, sagt die Ärztin Marianne Koch. Lebenslanges Lernen schütze sogar vor Alzheimer. Foto: Isolde Ohlbaum
Schließen
Ein Marathonlauf mit 85 muss es sicherlich nicht sein.
Ein Marathonlauf mit 85 muss es sicherlich nicht sein.

Beim Spazierengehen kommt es zu einer Steigerung des gesamten Stoffwechsels. Foto: dpa
Vollbild
In welchem Alter sollte man damit anfangen, an seine Gesundheit zu denken?
Schon relativ junge Menschen sollten sich in ihrer Familie umschauen, an welchen Krankheiten die Verwandten gestorben sind. Wenn beispielsweise der Bruder des Vaters mit 45 Jahren einen Herzinfarkt hatte, dann ist das vielleicht ein Hinweis auf eine Gefäßkrankheit und eine Warnung davor, seinen Blutdruck und den Cholesterinwert zu vernachlässigen. Um den Kopf zu trainieren, ist man nie zu alt. Auch mit 80 ist es möglich, etwas Neues zu lernen – sei es eine Fremdsprache oder ein Musikinstrument, am besten mit Gleichgesinnten. Denn gerade im Alter ist es unheimlich wichtig, Freunde und Familie um sich zu haben. Die schlimmste Alterskrankheit ist Einsamkeit.
Sie sprechen von Einsamkeit als Krankheit. Was meinen Sie damit?
Einsamkeit führt zu Depressionen, Mutlosigkeit und Angst; dadurch steigt auch die Gefahr von Herzkrankheiten und Demenz. In jedem Fall leidet die Lebensqualität enorm.
Körperlich und geistig rege zu sein, ist für Sie also essenziell?
Ja. Und man sollte sich, wenn man 55 oder 60 Jahre alt ist und die Blutdruckwerte bei den meisten Menschen hochgehen, darüber Gedanken machen, was man für seine Gesundheit tun kann. Auf Rauchen zu verzichten beispielsweise. Rauchen schadet dem Körper enorm.
Was raten Sie Menschen, die nicht mehr fit sind, in puncto Bewegung?
Das ist individuell verschieden. Wenn ein Patient nur mit dem Gehen ein Problem hat, dann wäre vielleicht ein Hometrainer eine gute Trainingsmöglichkeit. Ein Rollator an sich ist noch kein Grund, auf Bewegung zu verzichten. Viele Menschen haben ihn ohnehin nur, weil sie sich damit sicherer fühlen, falls ihnen schwindelig wird oder Ähnliches.
Wie viel Bewegung ist sinnvoll? Reicht der Schaufensterbummel, im Garten Unkraut zu jäten – oder muss es ein bisschen mehr sein?
Sich im Garten zu bewegen, ist besser als nichts. Aber es ist nicht das, was der Körper eigentlich haben will: Beim Spazierengehen, beim Tennisspielen oder beim Laufen kommt es zu einer Steigerung des gesamten Stoffwechsels, wodurch der Blutdruck und das Cholesterin runtergehen und die Botenstoffe im Gehirn – Serotonin, Dopamin – angeregt werden. Das hilft auch bei leichten Depressionen. Wieviel der einzelne Patient sich noch zumuten kann, muss der jeweilige Hausarzt oder Internist entscheiden. Ein Marathonlauf mit 85 muss es sicherlich nicht sein.
Schon relativ junge Menschen sollten sich in ihrer Familie umschauen, an welchen Krankheiten die Verwandten gestorben sind. Wenn beispielsweise der Bruder des Vaters mit 45 Jahren einen Herzinfarkt hatte, dann ist das vielleicht ein Hinweis auf eine Gefäßkrankheit und eine Warnung davor, seinen Blutdruck und den Cholesterinwert zu vernachlässigen. Um den Kopf zu trainieren, ist man nie zu alt. Auch mit 80 ist es möglich, etwas Neues zu lernen – sei es eine Fremdsprache oder ein Musikinstrument, am besten mit Gleichgesinnten. Denn gerade im Alter ist es unheimlich wichtig, Freunde und Familie um sich zu haben. Die schlimmste Alterskrankheit ist Einsamkeit.
Sie sprechen von Einsamkeit als Krankheit. Was meinen Sie damit?
Einsamkeit führt zu Depressionen, Mutlosigkeit und Angst; dadurch steigt auch die Gefahr von Herzkrankheiten und Demenz. In jedem Fall leidet die Lebensqualität enorm.
Körperlich und geistig rege zu sein, ist für Sie also essenziell?
Ja. Und man sollte sich, wenn man 55 oder 60 Jahre alt ist und die Blutdruckwerte bei den meisten Menschen hochgehen, darüber Gedanken machen, was man für seine Gesundheit tun kann. Auf Rauchen zu verzichten beispielsweise. Rauchen schadet dem Körper enorm.
Was raten Sie Menschen, die nicht mehr fit sind, in puncto Bewegung?
Das ist individuell verschieden. Wenn ein Patient nur mit dem Gehen ein Problem hat, dann wäre vielleicht ein Hometrainer eine gute Trainingsmöglichkeit. Ein Rollator an sich ist noch kein Grund, auf Bewegung zu verzichten. Viele Menschen haben ihn ohnehin nur, weil sie sich damit sicherer fühlen, falls ihnen schwindelig wird oder Ähnliches.
Wie viel Bewegung ist sinnvoll? Reicht der Schaufensterbummel, im Garten Unkraut zu jäten – oder muss es ein bisschen mehr sein?
Sich im Garten zu bewegen, ist besser als nichts. Aber es ist nicht das, was der Körper eigentlich haben will: Beim Spazierengehen, beim Tennisspielen oder beim Laufen kommt es zu einer Steigerung des gesamten Stoffwechsels, wodurch der Blutdruck und das Cholesterin runtergehen und die Botenstoffe im Gehirn – Serotonin, Dopamin – angeregt werden. Das hilft auch bei leichten Depressionen. Wieviel der einzelne Patient sich noch zumuten kann, muss der jeweilige Hausarzt oder Internist entscheiden. Ein Marathonlauf mit 85 muss es sicherlich nicht sein.

Beim Spazierengehen kommt es zu einer Steigerung des gesamten Stoffwechsels. Foto: dpa
Schließen
Es geht darum, Bewegung in den Alltag einzubauen
Es geht darum, Bewegung in den Alltag einzubauen

Wer sich regelmäßig bewegt, hat ein Bedürfnis nach Bewegung. Foto: dpa
Vollbild
Reicht ein täglicher Spaziergang?
Es gab vor ein paar Jahren eine Studie in England mit 1000 Beteiligten über 75 Jahren, die täglich zwei Meilen, also drei Kilometer, zu Fuß gingen – egal in welchem Tempo. Die anderen 1000 Studienteilnehmer mussten nichts machen. Nach drei Jahren hat man die Gruppen verglichen mit folgendem Ergebnis: Diejenigen, die täglich zwei Meilen gegangen waren, hatten 50 Prozent weniger Schlaganfälle und Herzinfarkte als die anderen. Wer sich im Alter wohlfühlen und gut leben will, kann und muss vielleicht sogar etwas dafür tun.
Wie überwinden Sie Ihren inneren Schweinehund, wenn Sie auf dem Sofa sitzen, draußen schlechtes Wetter ist – und man eigentlich keinen Hund vors Haus jagt?
Bei mir ist es so: Mein Hund schaut mich an – und los geht’s. Aber ich würde auch ohne Hund rausgehen. Wenn es stürmisch ist, ziehe ich mich eben anders an. Ich genieße es auch rauszugehen, weil ich mich hinterher besser fühle. Wer sich regelmäßig bewegt, hat ein Bedürfnis nach Bewegung. Dann sagt einem der Körper oder der Geist, dass es Zeit wird, etwas zu tun. Man muss Bewegung in das tägliche Leben einbauen. Ob mit Freunden oder alleine – es muss ein Teil des Alltags werden.
Wurde der Faktor Bewegung in den vergangenen Jahren unterschätzt – auch im Hinblick auf Zivilisationskrankheiten wie Krebs?
Wenn Sie damit Sport meinen, dann ja. Krebspatienten, die nach Operationen regelmäßig anfingen, Sport zu machen, haben eine viel geringere Rückfallquote als andere. Die Rückfallquote ist zum Teil sogar geringer als bei Patienten, die nach der Operation mit einer Chemotherapie behandelt wurden. Sport hilft unglaublich viel. Man weiß inzwischen auch, dass das Immunsystem von Menschen, die sich viel bewegen, besser ist und deshalb defekte Zellen des Körpers, die sich zu einem Krebs entwickeln könnten, leichter erkennt und vernichtet.
Was raten Sie Menschen, die sich gerne bewegen würden, aber ständig Zeitnot haben?
Sie sollten eine Woche lang einen genauen Stundenplan führen. Dann sehen sie, wann sie am ehesten Zeit für regelmäßigen Sport haben. Wie gesagt, es geht darum, Bewegung in den Alltag einzubauen.
Es gab vor ein paar Jahren eine Studie in England mit 1000 Beteiligten über 75 Jahren, die täglich zwei Meilen, also drei Kilometer, zu Fuß gingen – egal in welchem Tempo. Die anderen 1000 Studienteilnehmer mussten nichts machen. Nach drei Jahren hat man die Gruppen verglichen mit folgendem Ergebnis: Diejenigen, die täglich zwei Meilen gegangen waren, hatten 50 Prozent weniger Schlaganfälle und Herzinfarkte als die anderen. Wer sich im Alter wohlfühlen und gut leben will, kann und muss vielleicht sogar etwas dafür tun.
Wie überwinden Sie Ihren inneren Schweinehund, wenn Sie auf dem Sofa sitzen, draußen schlechtes Wetter ist – und man eigentlich keinen Hund vors Haus jagt?
Bei mir ist es so: Mein Hund schaut mich an – und los geht’s. Aber ich würde auch ohne Hund rausgehen. Wenn es stürmisch ist, ziehe ich mich eben anders an. Ich genieße es auch rauszugehen, weil ich mich hinterher besser fühle. Wer sich regelmäßig bewegt, hat ein Bedürfnis nach Bewegung. Dann sagt einem der Körper oder der Geist, dass es Zeit wird, etwas zu tun. Man muss Bewegung in das tägliche Leben einbauen. Ob mit Freunden oder alleine – es muss ein Teil des Alltags werden.
Wurde der Faktor Bewegung in den vergangenen Jahren unterschätzt – auch im Hinblick auf Zivilisationskrankheiten wie Krebs?
Wenn Sie damit Sport meinen, dann ja. Krebspatienten, die nach Operationen regelmäßig anfingen, Sport zu machen, haben eine viel geringere Rückfallquote als andere. Die Rückfallquote ist zum Teil sogar geringer als bei Patienten, die nach der Operation mit einer Chemotherapie behandelt wurden. Sport hilft unglaublich viel. Man weiß inzwischen auch, dass das Immunsystem von Menschen, die sich viel bewegen, besser ist und deshalb defekte Zellen des Körpers, die sich zu einem Krebs entwickeln könnten, leichter erkennt und vernichtet.
Was raten Sie Menschen, die sich gerne bewegen würden, aber ständig Zeitnot haben?
Sie sollten eine Woche lang einen genauen Stundenplan führen. Dann sehen sie, wann sie am ehesten Zeit für regelmäßigen Sport haben. Wie gesagt, es geht darum, Bewegung in den Alltag einzubauen.

Wer sich regelmäßig bewegt, hat ein Bedürfnis nach Bewegung. Foto: dpa
Schließen
Diäten machen dick, alle
Diäten machen dick, alle

Es gibt relativ neue Erkenntnisse, dass der Körper jedes Kilogramm Übergewicht auf Biegen und Brechen verteidigt. Foto: dpa
Vollbild
Mangelnde Bewegung und falsche Ernährung ziehen meist auch Übergewicht nach sich. Wie gefährlich ist es, zu viel auf den Rippen zu haben?
Vor allem bei den ganz kleinen Kindern wäre es wichtig, ihnen keine Süßigkeiten zu geben und sie gesund zu ernähren, weil sich bei ihnen erst ein Geschmacksarchiv ausbildet, das sie ein Leben lang begleitet. Wenn in ihrem Kopf etabliert ist, dass Gemüse gut und fettmachendes Industriezeug schlecht ist, dann werden sie das auch später beibehalten. Das Essverhalten, auch die Frage, wie groß eine Portion sein sollte, wird sehr früh geprägt. Deshalb müssen Eltern wahnsinnig aufpassen, dass sie ihren Kindern eine vernünftige Vorstellung von gutem Essen vermitteln.
Das heißt, Eltern sind über die Ernährung mitverantwortlich, wie hoch das Risiko ihres Kindes ist, später an einer Herz-Kreislauf-Erkrankung zu leiden.
Ja, aber auch die Bewegung ist entscheidend. Wenn Kinder in der Schule und zu Hause nur rumsitzen, werden sie leichter übergewichtig, so einfach ist das. Und dann kann man darauf warten, dass sie später Herz-Kreislauf-Erkrankungen, Diabetes und Ähnliches bekommen.
Viele Menschen wollen ja abnehmen, bringen es aber allenfalls zu einem Jo-Jo-Effekt. Was raten Sie solchen Diät-Verzweifelten?
Auch wenn das keine Hilfe ist: Am besten wäre es natürlich, überhaupt nicht übergewichtig zu werden. Es gibt relativ neue Erkenntnisse, dass der Körper jedes Kilogramm Übergewicht auf Biegen und Brechen verteidigt. Wenn Sie fasten oder Diät machen, stellt sich der Stoffwechsel um. Die Schilddrüsenhormone werden anders, weil der Körper Angst hat zu verhungern. In der Folge wird dann noch die letzte Kalorie aus der Nahrung in Fett oder Energie umgewandelt. Wenn Sie zu schnell zehn Kilogramm abnehmen, werden Sie merken, dass Ihr Körper mit Hungeranfällen darauf besteht, wieder zuzunehmen. Dann ist der Jo-Jo-Effekt unvermeidlich.
Das sind ja wahrlich trostlose Aussichten.
Nein. Sie müssen einfach langsam weniger essen. Nicht versuchen, auf die Schnelle fünf Kilogramm abzunehmen, das bleibt nicht. Diäten machen dick, alle. Sie müssen langsamer essen, als man das normalerweise macht, und die Portionen um zirka ein Drittel kürzen. Drei Schweinshaxen pro Woche wären aber, auch langsam gegessen, kontraproduktiv.
Vor allem bei den ganz kleinen Kindern wäre es wichtig, ihnen keine Süßigkeiten zu geben und sie gesund zu ernähren, weil sich bei ihnen erst ein Geschmacksarchiv ausbildet, das sie ein Leben lang begleitet. Wenn in ihrem Kopf etabliert ist, dass Gemüse gut und fettmachendes Industriezeug schlecht ist, dann werden sie das auch später beibehalten. Das Essverhalten, auch die Frage, wie groß eine Portion sein sollte, wird sehr früh geprägt. Deshalb müssen Eltern wahnsinnig aufpassen, dass sie ihren Kindern eine vernünftige Vorstellung von gutem Essen vermitteln.
Das heißt, Eltern sind über die Ernährung mitverantwortlich, wie hoch das Risiko ihres Kindes ist, später an einer Herz-Kreislauf-Erkrankung zu leiden.
Ja, aber auch die Bewegung ist entscheidend. Wenn Kinder in der Schule und zu Hause nur rumsitzen, werden sie leichter übergewichtig, so einfach ist das. Und dann kann man darauf warten, dass sie später Herz-Kreislauf-Erkrankungen, Diabetes und Ähnliches bekommen.
Viele Menschen wollen ja abnehmen, bringen es aber allenfalls zu einem Jo-Jo-Effekt. Was raten Sie solchen Diät-Verzweifelten?
Auch wenn das keine Hilfe ist: Am besten wäre es natürlich, überhaupt nicht übergewichtig zu werden. Es gibt relativ neue Erkenntnisse, dass der Körper jedes Kilogramm Übergewicht auf Biegen und Brechen verteidigt. Wenn Sie fasten oder Diät machen, stellt sich der Stoffwechsel um. Die Schilddrüsenhormone werden anders, weil der Körper Angst hat zu verhungern. In der Folge wird dann noch die letzte Kalorie aus der Nahrung in Fett oder Energie umgewandelt. Wenn Sie zu schnell zehn Kilogramm abnehmen, werden Sie merken, dass Ihr Körper mit Hungeranfällen darauf besteht, wieder zuzunehmen. Dann ist der Jo-Jo-Effekt unvermeidlich.
Das sind ja wahrlich trostlose Aussichten.
Nein. Sie müssen einfach langsam weniger essen. Nicht versuchen, auf die Schnelle fünf Kilogramm abzunehmen, das bleibt nicht. Diäten machen dick, alle. Sie müssen langsamer essen, als man das normalerweise macht, und die Portionen um zirka ein Drittel kürzen. Drei Schweinshaxen pro Woche wären aber, auch langsam gegessen, kontraproduktiv.

Es gibt relativ neue Erkenntnisse, dass der Körper jedes Kilogramm Übergewicht auf Biegen und Brechen verteidigt. Foto: dpa
Schließen
Viele Menschen scheuen sich zu kochen.
Viele Menschen scheuen sich zu kochen.

Marianne Koch. Foto: dpa
Vollbild
War es für Sie immer einfach, Ihr Gewicht zu halten?
Ich war als Kind so dürr, dass meine Mutter schon besorgt um mich war. Aber letztlich hat mir das geholfen, nie Gewichtsprobleme zu haben. Mit fortschreitendem Alter habe ich einfach ein bisschen weniger gegessen, weil der Stoffwechsel nach dem 40./45. Lebensjahr nachlässt.
Aber ist es wirklich so gesund, dünn zu sein?
Nein, es gibt Statistiken, die zeigen, dass die leicht Übergewichtigen die höchste Lebenserwartung haben. Ein Body-Mass-Index von 26, 27 ist absolut okay.
Inwiefern sind die Gene am Übergewicht beteiligt? Sie haben als Ärztin wahrscheinlich sehr oft den Satz gehört: „Ich esse ja kaum etwas und nehme trotzdem zu“ oder „ich habe halt feste Knochen“.
Wenn der Vater, die Mutter oder die Großmutter bessere Futterverwerter waren und jede Kalorie angesetzt haben, dann ist das durchaus ein Hinweis auf das Risiko, selbst übergewichtig zu werden. Aber es liegt auch an diesen schrecklichen Essgewohnheiten heutzutage. Viele Menschen scheuen sich zu kochen. Aber wenn man nur Fast Food oder Fertiggerichte isst, nimmt man einfach zu viele Kalorien zu sich. Sie enthalten oft versteckte Fette und schlechte Zutaten – das gilt übrigens auch für das Speisenangebot in vielen Kantinen.
Wenn ein Patient beim Blick in seine Familiengeschichte zu dem Ergebnis kommt, dass in seinen Genen einige Krankheitsrisiken lauern, was kann er dann tun?
Wenn Sie die Vermutung haben, dass Sie erbliche Risiken mit sich herumtragen, müssen Sie zu Ihrem Arzt gehen, der dann die entsprechenden Vorsorgeuntersuchungen machen oder Sie zu einem Facharzt überweisen kann.
Ich war als Kind so dürr, dass meine Mutter schon besorgt um mich war. Aber letztlich hat mir das geholfen, nie Gewichtsprobleme zu haben. Mit fortschreitendem Alter habe ich einfach ein bisschen weniger gegessen, weil der Stoffwechsel nach dem 40./45. Lebensjahr nachlässt.
Aber ist es wirklich so gesund, dünn zu sein?
Nein, es gibt Statistiken, die zeigen, dass die leicht Übergewichtigen die höchste Lebenserwartung haben. Ein Body-Mass-Index von 26, 27 ist absolut okay.
Inwiefern sind die Gene am Übergewicht beteiligt? Sie haben als Ärztin wahrscheinlich sehr oft den Satz gehört: „Ich esse ja kaum etwas und nehme trotzdem zu“ oder „ich habe halt feste Knochen“.
Wenn der Vater, die Mutter oder die Großmutter bessere Futterverwerter waren und jede Kalorie angesetzt haben, dann ist das durchaus ein Hinweis auf das Risiko, selbst übergewichtig zu werden. Aber es liegt auch an diesen schrecklichen Essgewohnheiten heutzutage. Viele Menschen scheuen sich zu kochen. Aber wenn man nur Fast Food oder Fertiggerichte isst, nimmt man einfach zu viele Kalorien zu sich. Sie enthalten oft versteckte Fette und schlechte Zutaten – das gilt übrigens auch für das Speisenangebot in vielen Kantinen.
Wenn ein Patient beim Blick in seine Familiengeschichte zu dem Ergebnis kommt, dass in seinen Genen einige Krankheitsrisiken lauern, was kann er dann tun?
Wenn Sie die Vermutung haben, dass Sie erbliche Risiken mit sich herumtragen, müssen Sie zu Ihrem Arzt gehen, der dann die entsprechenden Vorsorgeuntersuchungen machen oder Sie zu einem Facharzt überweisen kann.

Marianne Koch. Foto: dpa
Schließen
Den Blick nach vorne und gleichzeitig zurück richten
Den Blick nach vorne und gleichzeitig zurück richten

Patienten sollten aufmüpfig sein und ihren Arzt zum Reden aufzufordern. Foto: imago
Vollbild
Und das bezahlen die gesetzlichen Krankenkassen?
Ja sicher. Die Krankenkassen übernehmen die Kosten für die Früherkennung von Gebärmutterhalskrebs, Brustkrebs, Hautkrebs und auch Darmkrebs. Wann Sie Anspruch auf welche Untersuchung haben, hängt von Ihrem Alter, aber auch von der genetischen Vorbelastung ab. Aber Sie können natürlich auch selbst etwas tun – ganz unabhängig von der ärztlichen Diagnose. Wenn Ihre Mutter beispielsweise stark übergewichtig ist und deshalb Diabetes Typ 2 hat, sollten Sie unbedingt darauf achten, schlank zu bleiben.
Wer bis ins hohe Alter gesund bleiben will, sollte den Blick also nach vorne und gleichzeitig zurück richten?
Richtig. Und Sie brauchen einen vernünftigen Arzt. Aber das ist tatsächlich ein großes Problem, weil die Ärzte heutzutage nicht mehr für das bezahlt werden, was ich die „sprechende Medizin“ nenne. Das ist ein Skandal, weil ein guter Arzt, der Patienten als ganzheitliche Menschen in ihrem sozialen Umfeld wahrnimmt, ihnen zuhört und sie ausführlich berät, eine größere Chance hat, Krankheiten erfolgreich zu behandeln oder sogar zu verhindern. Deshalb ermutige ich die Patienten, aufmüpfig zu sein und ihren Arzt zum Reden aufzufordern – auch wenn ihm das nicht honoriert wird. Für die Mediziner ist es frustrierend, dass vieles von dem, was ihren Beruf ausmacht, nicht bezahlt wird.
Und welche Rolle spielt die Psyche bei der Entstehung von Krankheiten?
Die Psyche ist an allen Körperfunktionen beteiligt. Bei Rückenschmerzen beispielsweise wissen wir, dass Menschen, die unter ihrem Chef oder anderen seelischen Schmerzen leiden, häufiger davon betroffen sind. Das lässt sich auch gut erklären: Diese Patienten haben eine erhöhte Muskelspannung im Rücken, die dann Fehlhaltungen begünstigt. Verkürzte und verhärtete Muskeln sind eigentlich die Hauptgründe für Rückenschmerzen, die teilweise sogar zu Frühverrentungen führen.
Aber wie schafft man es, heiter zu sein, wenn vieles auf einem lastet?
Wir sollten uns um Verhältnismäßigkeit in unserem Leben bemühen. Das heißt, wir müssen lernen, uns die positiven Seiten in unserem Leben bewusst vor Augen zu führen und uns nicht auf das Negative zu konzentrieren. Das klingt sehr theoretisch, ich weiß, und es ist nicht einfach umzusetzen, vor allem, wenn es einem dreckig geht. Aber es scheint zu helfen. Wenn Seele und Körper in einem harmonischen Gleichgewicht sind, dann ist das auch Vorsorge.
Ja sicher. Die Krankenkassen übernehmen die Kosten für die Früherkennung von Gebärmutterhalskrebs, Brustkrebs, Hautkrebs und auch Darmkrebs. Wann Sie Anspruch auf welche Untersuchung haben, hängt von Ihrem Alter, aber auch von der genetischen Vorbelastung ab. Aber Sie können natürlich auch selbst etwas tun – ganz unabhängig von der ärztlichen Diagnose. Wenn Ihre Mutter beispielsweise stark übergewichtig ist und deshalb Diabetes Typ 2 hat, sollten Sie unbedingt darauf achten, schlank zu bleiben.
Wer bis ins hohe Alter gesund bleiben will, sollte den Blick also nach vorne und gleichzeitig zurück richten?
Richtig. Und Sie brauchen einen vernünftigen Arzt. Aber das ist tatsächlich ein großes Problem, weil die Ärzte heutzutage nicht mehr für das bezahlt werden, was ich die „sprechende Medizin“ nenne. Das ist ein Skandal, weil ein guter Arzt, der Patienten als ganzheitliche Menschen in ihrem sozialen Umfeld wahrnimmt, ihnen zuhört und sie ausführlich berät, eine größere Chance hat, Krankheiten erfolgreich zu behandeln oder sogar zu verhindern. Deshalb ermutige ich die Patienten, aufmüpfig zu sein und ihren Arzt zum Reden aufzufordern – auch wenn ihm das nicht honoriert wird. Für die Mediziner ist es frustrierend, dass vieles von dem, was ihren Beruf ausmacht, nicht bezahlt wird.
Und welche Rolle spielt die Psyche bei der Entstehung von Krankheiten?
Die Psyche ist an allen Körperfunktionen beteiligt. Bei Rückenschmerzen beispielsweise wissen wir, dass Menschen, die unter ihrem Chef oder anderen seelischen Schmerzen leiden, häufiger davon betroffen sind. Das lässt sich auch gut erklären: Diese Patienten haben eine erhöhte Muskelspannung im Rücken, die dann Fehlhaltungen begünstigt. Verkürzte und verhärtete Muskeln sind eigentlich die Hauptgründe für Rückenschmerzen, die teilweise sogar zu Frühverrentungen führen.
Aber wie schafft man es, heiter zu sein, wenn vieles auf einem lastet?
Wir sollten uns um Verhältnismäßigkeit in unserem Leben bemühen. Das heißt, wir müssen lernen, uns die positiven Seiten in unserem Leben bewusst vor Augen zu führen und uns nicht auf das Negative zu konzentrieren. Das klingt sehr theoretisch, ich weiß, und es ist nicht einfach umzusetzen, vor allem, wenn es einem dreckig geht. Aber es scheint zu helfen. Wenn Seele und Körper in einem harmonischen Gleichgewicht sind, dann ist das auch Vorsorge.

Patienten sollten aufmüpfig sein und ihren Arzt zum Reden aufzufordern. Foto: imago
Schließen
Nach der Filmkarriere als Ärztin erfolgreich
Nach der Filmkarriere als Ärztin erfolgreich

Marianne Koch im Rateteam von Robert Lembke (Mitte) bei „Was bin ich?“. Foto: dpa
Vollbild
Als Marianne Koch Ärztin wurde, lag bereits eine Karriere als Filmschauspielerin hinter ihr. Sie hat mit Hollywood-Größen wie Clint Eastwood und Charakterdarstellern wie Curd Jürgens gedreht. „Aber als Star in diesem Sinne habe ich mich nie gefühlt“, sagte sie im Gespräch mit der „Schwäbischen Zeitung“. „Das war für mich eher ein Hobby, weil ich ja immer wusste, dass ich Ärztin werden wollte.“ Nach dem zweiten medizinischen Staatsexamen arbeitete Marianne Koch als Internistin an Kliniken in Starnberg und München, bevor sie sich mit einer Praxis in München niederließ. Einem großen Fernsehpublikum ist sie auch als gewiefte Fragestellerin in der Sendung „Was bin ich?“ im Gedächtnis geblieben.
Seit vielen Jahren ist Marianne Koch auch als Buchautorin und Medizinjournalistin tätig. Im Bayerischen Rundfunk stellt sie sich seit 16 Jahren einmal wöchentlich im „Gesundheitsgespräch“ auf Bayern 2 den Fragen der Zuhörer. Bei dtv hat sie mehrere Bücher – unter anderem „Das Herz-Buch“, „Körperintelligenz“ und „Das Vorsorge-Buch“ – veröffentlicht. Marianne Koch lebt mit ihrem Mann, dem Schriftsteller Peter Hamm, in Tutzing am Starnberger See. (clak)
Seit vielen Jahren ist Marianne Koch auch als Buchautorin und Medizinjournalistin tätig. Im Bayerischen Rundfunk stellt sie sich seit 16 Jahren einmal wöchentlich im „Gesundheitsgespräch“ auf Bayern 2 den Fragen der Zuhörer. Bei dtv hat sie mehrere Bücher – unter anderem „Das Herz-Buch“, „Körperintelligenz“ und „Das Vorsorge-Buch“ – veröffentlicht. Marianne Koch lebt mit ihrem Mann, dem Schriftsteller Peter Hamm, in Tutzing am Starnberger See. (clak)

Marianne Koch im Rateteam von Robert Lembke (Mitte) bei „Was bin ich?“. Foto: dpa
Schließen
Kampf gegen Adipositas
Kampf gegen AdipositasDie Deutschen werden immer dicker – Auch viele Kinder sind betroffen
Von Dominik Prandl
Wenn Bella nach der Schule nach Hause kommt, ist es, als höre sie eine Stimme in ihrem Kopf, die sagt: „Geh jetzt und hol dir was zu essen.“ Heimlich schleicht sich die 15-Jährige dann in die Küche und stopft sich Essbares in ihre Taschen, um es in ihrem Zimmer zu verschlingen. „Ich habe sogar schon gefrorene Kroketten gegessen. Das ist zwar ekelhaft, aber in dem Moment egal“, sagt sie. Durch ihre Essattacken hat Bella stark zugenommen und gehört mittlerweile zu den sechs Prozent der Kinder in Deutschland, die von Adipositas, also starkem Übergewicht, betroffen sind. Auch Erwachsene werden hierzulande und weltweit immer dicker – meist leiden sie darunter psychisch. Übermäßig viele Kilos ziehen zudem Folgeerkrankungen nach sich.
Wenn Bella nach der Schule nach Hause kommt, ist es, als höre sie eine Stimme in ihrem Kopf, die sagt: „Geh jetzt und hol dir was zu essen.“ Heimlich schleicht sich die 15-Jährige dann in die Küche und stopft sich Essbares in ihre Taschen, um es in ihrem Zimmer zu verschlingen. „Ich habe sogar schon gefrorene Kroketten gegessen. Das ist zwar ekelhaft, aber in dem Moment egal“, sagt sie. Durch ihre Essattacken hat Bella stark zugenommen und gehört mittlerweile zu den sechs Prozent der Kinder in Deutschland, die von Adipositas, also starkem Übergewicht, betroffen sind. Auch Erwachsene werden hierzulande und weltweit immer dicker – meist leiden sie darunter psychisch. Übermäßig viele Kilos ziehen zudem Folgeerkrankungen nach sich.
Meist genetisch veranlagt
Meist genetisch veranlagt

In der Wangener Rehaklinik lernt die 15-jährige Bella, von welchen Lebensmitteln sie mehr, von welchen sie weniger essen sollte. Foto: Dominik Prandl
Vollbild
An der Rehabilitationskinderklinik in Wangen will man der Entwicklung frühzeitig entgegenwirken. Die Klinik ist auf Adipositas spezialisiert. 408 Kinder und Jugendliche aus ganz Deutschland kamen 2016 hierher, um etwas gegen ihre Fettleibigkeit zu tun. Im Schnitt dauert ihre Reha fünf Wochen. Bella, die eigentlich anders heißt, hat ihre Reha selbst in die Wege geleitet. „Ich will das Problem beheben, weil ich mich nicht wohlfühle“, sagt sie. „In der Kabine beim Shoppen raste ich aus, weil ich mich nicht hübsch finde.“ Wie viel sie heute wiegt, will sie lieber nicht sagen. Erzählt aber, dass sie vor einem halben Jahr, als ihr Opa gestorben ist, allein in zwei Monaten 20 Kilo zugenommen hat.
Die Ursachen für Adipositas sind vielfältig. Die meisten adipösen Menschen hätten die genetische Veranlagung zum Übergewicht, sagt Dirk Dammann, Chefarzt der Wangener Rehaklinik. Zudem lebten wir heute in Verhältnissen, in denen körperliche Aktivität weniger notwendig sei, sagt der Wangener Therapieleiter Robert Jaeschke. So arbeiten wir häufig in Büros, nehmen meist eher den Fahrstuhl als die Treppe und in der Freizeit wird gerne ferngesehen. Dass die psychische Situation wie bei Bella Auswirkung auf das Gewicht hat, kommt aber auch vor.
Darüber hinaus seien Menschen besonders gefährdet, wenn sie einen niedrigen Bildungsstand hätten, in Armut lebten oder einen Migrationshintergrund aufweisen würden, sagt Dammann. Weil mittlerweile klar ist, dass starkes Übergewicht nicht nur durch Bewegung und gesunde Ernährung bekämpft werden kann, wird an der Klinik in Wangen auch die psychische Komponente berücksichtigt. Es gehe vor allem darum, dass sich etwas im Kopf ändert, eine Bewusstseinsänderung stattfindet, erklärt Klinikleiter Alwin Baumann.
Die Ursachen für Adipositas sind vielfältig. Die meisten adipösen Menschen hätten die genetische Veranlagung zum Übergewicht, sagt Dirk Dammann, Chefarzt der Wangener Rehaklinik. Zudem lebten wir heute in Verhältnissen, in denen körperliche Aktivität weniger notwendig sei, sagt der Wangener Therapieleiter Robert Jaeschke. So arbeiten wir häufig in Büros, nehmen meist eher den Fahrstuhl als die Treppe und in der Freizeit wird gerne ferngesehen. Dass die psychische Situation wie bei Bella Auswirkung auf das Gewicht hat, kommt aber auch vor.
Darüber hinaus seien Menschen besonders gefährdet, wenn sie einen niedrigen Bildungsstand hätten, in Armut lebten oder einen Migrationshintergrund aufweisen würden, sagt Dammann. Weil mittlerweile klar ist, dass starkes Übergewicht nicht nur durch Bewegung und gesunde Ernährung bekämpft werden kann, wird an der Klinik in Wangen auch die psychische Komponente berücksichtigt. Es gehe vor allem darum, dass sich etwas im Kopf ändert, eine Bewusstseinsänderung stattfindet, erklärt Klinikleiter Alwin Baumann.

In der Wangener Rehaklinik lernt die 15-jährige Bella, von welchen Lebensmitteln sie mehr, von welchen sie weniger essen sollte. Foto: Dominik Prandl
Schließen
Besorgniserregender Anstieg
Besorgniserregender Anstieg
Vollbild
Laut aktuellem Bericht der Deutschen Gesellschaft für Ernährung (DGE) in Bonn sind 59 Prozent der Männer und 37 Prozent der Frauen in Deutschland übergewichtig. Besorgniserregend sei der Anstieg von Adipositas, also starkem Übergewicht: Von 1999 bis 2013 habe der Anteil adipöser Männer um 40 Prozent und der extrem dicker Frauen um 24,2 Prozent zugenommen – laut Robert-Koch-Institut ist mittlerweile ein Viertel der Erwachsenen hierzulande stark übergewichtig. Chefarzt Dammann spricht von einer „Volkskrankheit“, weil Adipositas eine Reihe von Folgeerkrankungen noch Jahrzehnte später nach sich ziehe: etwa Bluthochdruck, Diabetes, Gelenk- und auch Herzprobleme. Mittlerweile würden schon Kinder an Diabetes vom Typ 2 erkranken, früher habe das hingegen nur Ältere betroffen. Adipöse Menschen haben überdies eine geringere Lebenserwartung – zehn Jahre kürzer als normalgewichtige Menschen leben sie, so das Ergebnis eines groß angelegten internationalen Forschungsprojekts um Emanuele Di Angelantonio von der Universität Cambridge.
„Wir haben in der Vergangenheit ganz viel Adipösen unrecht getan, haben gesagt: ,Reiß dich zusammen.’ So einfach ist es aber nicht“, sagt Dammann. Je genetischer die Ursache, desto schwieriger sei es, etwas dagegen zu tun, erklärt Therapieleiter Jaeschke. Den Kindern werde in der Klinik klargemacht, dass sie ihr ganzes Leben lang am Ball bleiben müssten. „Es ist ein harter Kampf.“ Nur die Ernährung umzustellen, führe lediglich zu kurzfristigen Erfolgen. Ohnehin gilt: Nach der Diät ist vor der Diät. Denn durch den Jo-Jo-Effekt sind die Kilos schnell wieder zurück. In der Wangener Klinik gilt deshalb der Grundsatz: Es gibt keine verbotenen Lebensmittel, es kommt vielmehr auf die Essensportionen an.
„Wir haben in der Vergangenheit ganz viel Adipösen unrecht getan, haben gesagt: ,Reiß dich zusammen.’ So einfach ist es aber nicht“, sagt Dammann. Je genetischer die Ursache, desto schwieriger sei es, etwas dagegen zu tun, erklärt Therapieleiter Jaeschke. Den Kindern werde in der Klinik klargemacht, dass sie ihr ganzes Leben lang am Ball bleiben müssten. „Es ist ein harter Kampf.“ Nur die Ernährung umzustellen, führe lediglich zu kurzfristigen Erfolgen. Ohnehin gilt: Nach der Diät ist vor der Diät. Denn durch den Jo-Jo-Effekt sind die Kilos schnell wieder zurück. In der Wangener Klinik gilt deshalb der Grundsatz: Es gibt keine verbotenen Lebensmittel, es kommt vielmehr auf die Essensportionen an.
Schließen
Gesund und lecker
Gesund und lecker

Bella lernt, wie man etwa Döner oder Hamburger zubereiten kann, ohne dass man davon zu stark zunimmt. Foto: Dominik Prandl
Vollbild
In der Lehrküche hat Bella Tränen in den Augen – nicht weil sie sich im Verzicht übt, vielmehr schnippelt sie Zwiebeln für eine Pizza. Hier lernt sie, wie man etwa Döner oder Hamburger zubereiten kann, ohne dass man davon doll zunimmt. „Gesund kochen heißt nicht, dass es nicht schmeckt“, sagt Jaeschke. In Bellas Rücken steht eine große Pyramide. Auf verschiedenen Ebenen enthält diese unterschiedliche Lebensmittel wie im Kaufmannsladen. Sie zeigt den jungen Menschen, von welchen Lebensmitteln sie mehr, von welchen sie weniger essen sollten.
Während die Kinder schnippeln und rühren, schult Frank Hellmond, Leiter der Ernährungstherapie, die Eltern und Großeltern. Schließlich habe die Erziehung einen großen Einfluss auf den körperlichen Zustand der Kinder. An den Eltern liege es, zu sagen: „Das war jetzt eure Süßigkeit.“ Allerdings: „Jemand, der nur gesunde Lebensmittel zu sich nimmt, muss nicht rank und schlank sein“, erklärt Hellmond. „Es geht um die Menge.“ An der Ernährungspyramide lässt sich ablesen, wie viel Getreide, Gemüse, tierische Produkte, fettige Lebensmittel und Süßigkeiten Kinder am Tag essen sollten. Eine Portion Süßes, etwa eine Handvoll, ist pro Tag vertretbar. Auch Bella darf so viel naschen. Durch eine Strichliste stellt sie sicher, dass sie nicht mehr als sieben Portionen Süßes in der Woche zu sich nimmt.
Nicht nur Betroffene müssen etwas tun, auch die Politik gerät zunehmend unter Zugzwang. In 30 Jahren werde uns das Volksleiden Adipositas vor große Probleme stellen, weil nicht klar sei, wie die Behandlungskosten finanziert werden sollen, sagt Chefarzt Dammann. Aus Daten des Statistischen Bundesamtes geht hervor, dass 2015 rund 22000 adipöse Menschen in deutschen Krankenhäusern vollstationär behandelt wurden – zehn Jahre zuvor waren es noch lediglich rund 7000. Laut einer Studie lagen die Kosten für Adipositas in Deutschland im Jahr 2003 bei 13 Milliarden Euro – bedingt besonders durch die Behandlung der Begleiterkrankungen. Seitdem steigt die Zahl stark übergewichtiger Menschen weiter, und damit auch die Kosten.
Die Politik könnte etwas dagegen tun, sagt Dammann. Eine Lebensmittelampel, die auf den ersten Blick anzeigt, wie hoch der Anteil von Zucker, Fett oder Salz im Produkt ist, hätte eine „moderate Wirkung“. Doch als sie in Deutschland im Gespräch gewesen sei, habe die Lebensmittelindustrie „Angst bekommen“, erinnert sich der Wangener Chefarzt. Er ist zudem überzeugt davon, dass eine Fettsteuer, die Lebensmittel mit viel Kalorien teurer mache, funktionieren würde. „Wir könnten so den Konsum steuern. Die Frage ist, ob wir so tief eingreifen wollen.“
Während die Kinder schnippeln und rühren, schult Frank Hellmond, Leiter der Ernährungstherapie, die Eltern und Großeltern. Schließlich habe die Erziehung einen großen Einfluss auf den körperlichen Zustand der Kinder. An den Eltern liege es, zu sagen: „Das war jetzt eure Süßigkeit.“ Allerdings: „Jemand, der nur gesunde Lebensmittel zu sich nimmt, muss nicht rank und schlank sein“, erklärt Hellmond. „Es geht um die Menge.“ An der Ernährungspyramide lässt sich ablesen, wie viel Getreide, Gemüse, tierische Produkte, fettige Lebensmittel und Süßigkeiten Kinder am Tag essen sollten. Eine Portion Süßes, etwa eine Handvoll, ist pro Tag vertretbar. Auch Bella darf so viel naschen. Durch eine Strichliste stellt sie sicher, dass sie nicht mehr als sieben Portionen Süßes in der Woche zu sich nimmt.
Nicht nur Betroffene müssen etwas tun, auch die Politik gerät zunehmend unter Zugzwang. In 30 Jahren werde uns das Volksleiden Adipositas vor große Probleme stellen, weil nicht klar sei, wie die Behandlungskosten finanziert werden sollen, sagt Chefarzt Dammann. Aus Daten des Statistischen Bundesamtes geht hervor, dass 2015 rund 22000 adipöse Menschen in deutschen Krankenhäusern vollstationär behandelt wurden – zehn Jahre zuvor waren es noch lediglich rund 7000. Laut einer Studie lagen die Kosten für Adipositas in Deutschland im Jahr 2003 bei 13 Milliarden Euro – bedingt besonders durch die Behandlung der Begleiterkrankungen. Seitdem steigt die Zahl stark übergewichtiger Menschen weiter, und damit auch die Kosten.
Die Politik könnte etwas dagegen tun, sagt Dammann. Eine Lebensmittelampel, die auf den ersten Blick anzeigt, wie hoch der Anteil von Zucker, Fett oder Salz im Produkt ist, hätte eine „moderate Wirkung“. Doch als sie in Deutschland im Gespräch gewesen sei, habe die Lebensmittelindustrie „Angst bekommen“, erinnert sich der Wangener Chefarzt. Er ist zudem überzeugt davon, dass eine Fettsteuer, die Lebensmittel mit viel Kalorien teurer mache, funktionieren würde. „Wir könnten so den Konsum steuern. Die Frage ist, ob wir so tief eingreifen wollen.“

Bella lernt, wie man etwa Döner oder Hamburger zubereiten kann, ohne dass man davon zu stark zunimmt. Foto: Dominik Prandl
Schließen
Hohes Gewicht, wenig Verdienst
Hohes Gewicht, wenig Verdienst

Bewegung hilft: Die Patientinnen Lilli (rechts) und Bella in der Sporthalle der Fachklinik in Wangen. Foto: dpa
Vollbild
Die Betroffenen selbst unterliegen oft einem Leidensdruck: weil sie keinen Schokoriegel in der Öffentlichkeit essen können, ohne dass sie schräg angeguckt werden, weil sie gehänselt werden oder weil sie ganz einfach mit ihrem Aussehen nicht zufrieden sind und sich bei der Partnersuche nicht trauen, jemanden anzusprechen. Dammann liefert noch eine weitere harte Erkenntnis: „Je mehr Menschen wiegen, desto weniger verdienen sie durchschnittlich.“
Bella ist auf dem besten Weg, ihre Essstörung in den Griff zu bekommen. Ihr hilft schon der strukturierte Alltag in der Klinik mit den vielen Terminen, sagt sie. Auch dass sie hier fast immer unter Menschen sei, halte sie von ihren Essattacken ab. Doch was, wenn sie wieder nach Hause kommt und allein ist? Letztendlich gehe es darum, den Lebensstil nachhaltig zu ändern, sagt Chefarzt Dammann. Leicht sei das nicht, denn „logische Einsicht ist etwas ganz anderes, als das Eingesehene zu leben“. Was Sport betrifft, könnte das bei Bella aber in jedem Fall funktionieren. „Eigentlich fehlt mir die Motivation dazu“, gesteht die Jugendliche. „Aber hier sagen sie: ,Du musst da hin.’“
Für das Ergometer habe man sie auf diese Weise zwar nicht begeistern können. Dafür schwimme sie jetzt gern und Joggen mache ihr mittlerweile auch Spaß – „weil meine Ausdauer schon viel besser geworden ist.“
Bella ist auf dem besten Weg, ihre Essstörung in den Griff zu bekommen. Ihr hilft schon der strukturierte Alltag in der Klinik mit den vielen Terminen, sagt sie. Auch dass sie hier fast immer unter Menschen sei, halte sie von ihren Essattacken ab. Doch was, wenn sie wieder nach Hause kommt und allein ist? Letztendlich gehe es darum, den Lebensstil nachhaltig zu ändern, sagt Chefarzt Dammann. Leicht sei das nicht, denn „logische Einsicht ist etwas ganz anderes, als das Eingesehene zu leben“. Was Sport betrifft, könnte das bei Bella aber in jedem Fall funktionieren. „Eigentlich fehlt mir die Motivation dazu“, gesteht die Jugendliche. „Aber hier sagen sie: ,Du musst da hin.’“
Für das Ergometer habe man sie auf diese Weise zwar nicht begeistern können. Dafür schwimme sie jetzt gern und Joggen mache ihr mittlerweile auch Spaß – „weil meine Ausdauer schon viel besser geworden ist.“

Bewegung hilft: Die Patientinnen Lilli (rechts) und Bella in der Sporthalle der Fachklinik in Wangen. Foto: dpa
Schließen
Adipositas
Adipositas

Vollbild
Starkes Übergewicht wird als Adipositas bezeichnet.
Von Adipositas spricht man ab einem Body Mass Index (BMI) von 30. Den BMI bestimmt man, indem das Körpergewicht durch die Körpergröße in Quadrat geteilt wird (also etwa: 80 Kilo / 1,80 m2).
Für Kinder gelten spezielle Referenzwerte, die eine Einstufung der individuellen BMI-Werte erlauben. Eine Krankheit ist Adipositas insofern, als ab einem bestimmten Ausmaß von Übergewicht ein deutlich erhöhtes Risiko für Folgeerkrankungen besteht.
Ob und welche Therapiemaßnahmen die gesetzliche Krankenkasse bei Adipositas zahlt, werde stets im Einzelfall entschieden, erklärt Pressereferentin Claudia Widmaier vom GKV-Spitzenverband.
Auch für chirurgische Eingriffe gebe es bestimmte Voraussetzungen: Die Implantation eines Magenbandes etwa, wodurch der Magendurchmesser verkleinert wird, wird erst ab einem BMI von mehr als 35, verbunden mit starken Begleiterkrankungen, vorgenommen. Außerdem müssen konservative Behandlungsmöglichkeiten schon ausgeschöpft worden sein. (dtp)
Von Adipositas spricht man ab einem Body Mass Index (BMI) von 30. Den BMI bestimmt man, indem das Körpergewicht durch die Körpergröße in Quadrat geteilt wird (also etwa: 80 Kilo / 1,80 m2).
Für Kinder gelten spezielle Referenzwerte, die eine Einstufung der individuellen BMI-Werte erlauben. Eine Krankheit ist Adipositas insofern, als ab einem bestimmten Ausmaß von Übergewicht ein deutlich erhöhtes Risiko für Folgeerkrankungen besteht.
Ob und welche Therapiemaßnahmen die gesetzliche Krankenkasse bei Adipositas zahlt, werde stets im Einzelfall entschieden, erklärt Pressereferentin Claudia Widmaier vom GKV-Spitzenverband.
Auch für chirurgische Eingriffe gebe es bestimmte Voraussetzungen: Die Implantation eines Magenbandes etwa, wodurch der Magendurchmesser verkleinert wird, wird erst ab einem BMI von mehr als 35, verbunden mit starken Begleiterkrankungen, vorgenommen. Außerdem müssen konservative Behandlungsmöglichkeiten schon ausgeschöpft worden sein. (dtp)

Schließen
Alzheimer: Die Krankheit des Vergessens
Alzheimer: Die Krankheit des VergessensNoch immer gibt es kein Mittel gegen die Alzheimer-Demenz – Große Anforderungen an die Angehörigen
Von Daniel Hadrys
Seitdem sie ihre Tabletten nehme, spreche sie weniger, sagt Manfred Kauschwitz. „Dafür ist sie auch weniger aggressiv“, erzählt der 86-Jährige. „Und wieder fröhlicher.“ Seit einer gefühlten Ewigkeit ist der Rentner aus Ravensburg mit seiner Frau Marianne, jetzt 78 Jahre alt, verheiratet. Die Krankheit Alzheimer bestimmte das vergangene Jahrzehnt. 2006 hatte seine Frau Marianne die Diagnose erhalten.
Seitdem sie ihre Tabletten nehme, spreche sie weniger, sagt Manfred Kauschwitz. „Dafür ist sie auch weniger aggressiv“, erzählt der 86-Jährige. „Und wieder fröhlicher.“ Seit einer gefühlten Ewigkeit ist der Rentner aus Ravensburg mit seiner Frau Marianne, jetzt 78 Jahre alt, verheiratet. Die Krankheit Alzheimer bestimmte das vergangene Jahrzehnt. 2006 hatte seine Frau Marianne die Diagnose erhalten.
Doch an Lieder von früher erinnert sie sich
Doch an Lieder von früher erinnert sie sich

Es gibt Musiktherapien für Demenzkranke. Foto: Archiv
Vollbild
Doch dass etwas nicht stimme, habe Manfred Kauschwitz, wie er hier bei der Ravensburger Selbsthilfegruppe für Angehörige von Menschen mit Demenz erzählt, schon viel früher bemerkt. „2002 waren wir bei einer Familienfeier“, erinnert sich Kauschwitz, der, genau wie seine Frau, eigentlich einen anderen Nachnamen hat. „Meine Frau war in heller Aufregung, sie war besorgt, dass den Kindern der Familie, die in der Nähe einer Baugrube gespielt haben, etwas zustößt“, erzählt er. „Auf der Heimfahrt war die ganze Aufregung weg. Sie hat mich sogar gefragt: 'Wo waren wir?’“
Von da an habe er immer öfter bemerkt, dass ihr Gedächtnis nachlässt, dass seiner Frau Dinge nicht mehr eingefallen seien, wie sie Probleme beim Einkaufen bekam. Irgendwann habe sie den Weg zur Friedhofskapelle in Weißenau, den sie jede Woche mit dem Auto gefahren war, nicht mehr gefunden. „Aber an die Lieder von früher, an die erinnert sie sich“, sagt ihr Mann. Die ersten Jahre haben sie noch im gemeinsamen Haus gewohnt, jetzt leben sie in einer Drei-Zimmer-Wohnung mit Betreuung.
Von da an habe er immer öfter bemerkt, dass ihr Gedächtnis nachlässt, dass seiner Frau Dinge nicht mehr eingefallen seien, wie sie Probleme beim Einkaufen bekam. Irgendwann habe sie den Weg zur Friedhofskapelle in Weißenau, den sie jede Woche mit dem Auto gefahren war, nicht mehr gefunden. „Aber an die Lieder von früher, an die erinnert sie sich“, sagt ihr Mann. Die ersten Jahre haben sie noch im gemeinsamen Haus gewohnt, jetzt leben sie in einer Drei-Zimmer-Wohnung mit Betreuung.

Es gibt Musiktherapien für Demenzkranke. Foto: Archiv
Schließen
Kreuzworträtsel ja, Zaun reparieren nein
Kreuzworträtsel ja, Zaun reparieren nein

An die 1,6 Millionen Menschen sind in Deutschland an einer Demenz erkrankt. Foto: dpa
Vollbild
Marianne Kauschwitz ist eine von rund 190.000 Personen in Baden-Württemberg, die an einer Demenz erkrankt sind. Bundesweit sind es ungefähr 1,6 Millionen. „Demenz“ ist der Oberbegriff für eine Gruppe von Krankheiten des Gehirns, die Alzheimer-Erkrankung macht mit 70 Prozent den größten Teil aus.
Die Häufigkeit der Alzheimer-Demenz zeigt sich auch in der Angehörigengruppe, die sich jeden dritten Mittwoch des Monats im AOK-Gesundheitszentrum an der Ulmer Straße in Ravensburg trifft. Gemeinsam lachen die Teilnehmer über das Gemecker, über die harschen Worte und blöden Sprüche ihrer Liebsten, die früher, vor der Diagnose Alzheimer, für Streit gesorgt hätten. Jetzt sorgen sie für wehmütiges Lächeln, als wären streitbare Charaktereigenschaften zu liebenswerten Marotten geworden. Denn sie erinnern an die Zeit vor der Krankheit, die die Menschen verändert, es sind die Konstanten, die geblieben sind.
So wie die Feststellung des 71-jährigen Alzheimerpatienten, seine Frau müsse „immer ihren Senf dazugeben“. Bei ihrer Schilderung, ihr Mann verbringe anderthalb Stunden im Badezimmer, um sich wieder und wieder zu waschen, entgegnet eine weitere Teilnehmerin: „Wir können Familientausch machen.“ Sie berichtet von ihrem 73-jährigen Gatten, einem gelernten Schreiner, der zwar jeden Morgen Kreuzworträtsel löst, aber sich nicht erinnert, wie man einen Zaun repariert.
Die Häufigkeit der Alzheimer-Demenz zeigt sich auch in der Angehörigengruppe, die sich jeden dritten Mittwoch des Monats im AOK-Gesundheitszentrum an der Ulmer Straße in Ravensburg trifft. Gemeinsam lachen die Teilnehmer über das Gemecker, über die harschen Worte und blöden Sprüche ihrer Liebsten, die früher, vor der Diagnose Alzheimer, für Streit gesorgt hätten. Jetzt sorgen sie für wehmütiges Lächeln, als wären streitbare Charaktereigenschaften zu liebenswerten Marotten geworden. Denn sie erinnern an die Zeit vor der Krankheit, die die Menschen verändert, es sind die Konstanten, die geblieben sind.
So wie die Feststellung des 71-jährigen Alzheimerpatienten, seine Frau müsse „immer ihren Senf dazugeben“. Bei ihrer Schilderung, ihr Mann verbringe anderthalb Stunden im Badezimmer, um sich wieder und wieder zu waschen, entgegnet eine weitere Teilnehmerin: „Wir können Familientausch machen.“ Sie berichtet von ihrem 73-jährigen Gatten, einem gelernten Schreiner, der zwar jeden Morgen Kreuzworträtsel löst, aber sich nicht erinnert, wie man einen Zaun repariert.

An die 1,6 Millionen Menschen sind in Deutschland an einer Demenz erkrankt. Foto: dpa
Schließen
Gestörte Kommunikation
Gestörte Kommunikation

Der Arzt und Psychiater Alois Alzheimer. Foto: dpa
Vollbild
Auch wenn sich eine Demenz in Wesensveränderungen zeigt, „ist sie niemals seelisch bedingt“, sagt Jochen Tenter, Chefarzt der Alterspsychiatrie Ravensburg am Zentrum für Psychiatrie Südwürttemberg. „Es steckt immer eine Gehirnerkrankung dahinter.“ Für eine Demenz gibt es verschiedene Ursachen. Bei der Alzheimer-Erkrankung ist die Kommunikation zwischen den Nervenzellen des Gehirns gestört. Schuld daran sind „zwei Dinge, die relativ gut bekannt und aufgedeckt sind“, erklärt Tenter. Daneben gebe es aber viele Mechanismen, „bei denen es noch nicht so klar ist“.
Die Krankheit entdeckte Alois Alzheimer im Jahre 1906. In Gehirnproben verstorbener Patienten fand er Amyloid-Ablagerungen, die sogenannten „Plaques“. „Das ist Eiweißmüll, der sich zwischen den Zellen ablagert und der in einer Kettenreaktion immer mehr wird“, sagt Tenter. Diese Plaques werden durch eine fehlende „Eiweißschere“ im Gehirn nicht abgebaut. Beim Erlernen oder Merken neuer Dinge verknüpfen sich Nervenzellen im gesunden Gehirn mittels Aussprossungen – bei Alzheimerpatienten steht der Eiweißmüll wie eine Barriere dazwischen. Diese Ablagerungen können bereits bis zu 30 Jahre vor dem Ausbruch einer Demenz auftreten, also im mittleren Lebensalter.
„Der andere Mechanismus nennt sich ,Tau-Pathologie’“, so Tenter. „Die Zellen reden miteinander, indem sie Botenstoffe aussenden. Diese lösen einen elektrischen Impuls aus und dieser wiederum die Aussendung weiterer Botenstoffe.“ Diese werden im Zelllaib hergestellt und durch mikroskopisch kleine Kanäle an das andere Ende der Zelle transportiert. „Die Kanäle zerfallen bei der Alzheimer-Krankheit. Botenstoffe können zwar noch produziert werden, kommen aber nicht mehr an die Überträgerknotenpunkte. Dadurch verarmt das Muster an elektrischer Weitergabe.“
Die Krankheit entdeckte Alois Alzheimer im Jahre 1906. In Gehirnproben verstorbener Patienten fand er Amyloid-Ablagerungen, die sogenannten „Plaques“. „Das ist Eiweißmüll, der sich zwischen den Zellen ablagert und der in einer Kettenreaktion immer mehr wird“, sagt Tenter. Diese Plaques werden durch eine fehlende „Eiweißschere“ im Gehirn nicht abgebaut. Beim Erlernen oder Merken neuer Dinge verknüpfen sich Nervenzellen im gesunden Gehirn mittels Aussprossungen – bei Alzheimerpatienten steht der Eiweißmüll wie eine Barriere dazwischen. Diese Ablagerungen können bereits bis zu 30 Jahre vor dem Ausbruch einer Demenz auftreten, also im mittleren Lebensalter.
„Der andere Mechanismus nennt sich ,Tau-Pathologie’“, so Tenter. „Die Zellen reden miteinander, indem sie Botenstoffe aussenden. Diese lösen einen elektrischen Impuls aus und dieser wiederum die Aussendung weiterer Botenstoffe.“ Diese werden im Zelllaib hergestellt und durch mikroskopisch kleine Kanäle an das andere Ende der Zelle transportiert. „Die Kanäle zerfallen bei der Alzheimer-Krankheit. Botenstoffe können zwar noch produziert werden, kommen aber nicht mehr an die Überträgerknotenpunkte. Dadurch verarmt das Muster an elektrischer Weitergabe.“

Der Arzt und Psychiater Alois Alzheimer. Foto: dpa
Schließen
Fähigkeiten gehen verloren
Fähigkeiten gehen verloren

Im fortgeschrittenen Stadium sind die Betroffenen auf fremde Hilfe angewiesen. Foto: dpa
Vollbild
Beide Vorgänge lassen sich nicht aufhalten, die Alzheimer-Demenz schreitet immer weiter fort. Kognitive Fähigkeiten, Rechnen, Schreiben, Sprechen, Orientierung sowie das Gedächtnis, gehen immer weiter verloren. Im fortgeschrittenen Stadium sind die Betroffenen auf fremde Hilfe angewiesen, benötigen Unterstützung beim Ankleiden und Essen. Und erkennen ihre eigenen Angehörigen irgendwann nicht mehr, werden aggressiv oder apathisch.
Einer Alzheimer-Demenz vorbeugen kann man nicht. „Geistige und körperliche Aktivität können den Ausbruch aber etwas hinauszögern“, erklärt Tenter. Zudem gebe es Krankheiten, die Alzheimer begünstigen. Dazu gehören Bluthochdruck, Herzrhythmusstörungen und Diabetes. Denn oft ist die Gehirnschädigung durch Gefäßleiden nicht so eindeutig zu unterscheiden. Manche Wissenschaftler sagen, dass zumindest im hohen Alter Gefäßschäden und eine Alzheimer-Erkrankung fast immer gemeinsam vorkommen. Andersherum gilt daher: Was gut für das Herz ist, ist auch gut für das Gehirn, also Bewegung, ausgewogene Ernährung und kein Übergewicht.
Als erstes Symptom macht sich häufig die Vergesslichkeit bemerkbar. Dadurch, dass das durchschnittliche Erkrankungsalter bei 78 Jahren liegt, werde diese häufig als Alterserscheinung bagatellisiert, erklärt Tenter. Bis zu einem gewissen Grad sei diese auch normal. Man höre von Angehörigen, dass die betroffenen Verwandten bestimmte Dinge anders machen als vorher, „nicht mehr so ordentlich Kontoauszüge oder Rechnungen ablegen, Sachen sammeln, die man früher für wertlos gehalten hat, anfangen, sich körperlich zu vernachlässigen, ohne dass es selbstkritisch bemerkt wird, oder dass sie nicht mehr planen können und keine Fantasie mehr haben.“
Diese Beobachtungen seien wichtig für die Diagnose, erklärt Tenter. Daneben gibt es psychologische Tests, die Gedächtnis, Denkvermögen, Sprache und Wahrnehmungsfähigkeit der Betroffenen prüfen. Zusätzlich können Laboruntersuchungen des Nervenwassers oder Computer- und Magnetresonanztomografie die Diagnose bestätigen. Wichtig sei laut Tenter, dass die Symptome mindestens ein halbes Jahr bestehen, da auch andere Krankheiten, beispielsweise eine schwere Depression oder eine Schädel-Hirn-Verletzung, einige Symptome hervorrufen können, wie zum Beispiel Aufmerksamkeitsstörungen und einen verminderten Antrieb.
Einer Alzheimer-Demenz vorbeugen kann man nicht. „Geistige und körperliche Aktivität können den Ausbruch aber etwas hinauszögern“, erklärt Tenter. Zudem gebe es Krankheiten, die Alzheimer begünstigen. Dazu gehören Bluthochdruck, Herzrhythmusstörungen und Diabetes. Denn oft ist die Gehirnschädigung durch Gefäßleiden nicht so eindeutig zu unterscheiden. Manche Wissenschaftler sagen, dass zumindest im hohen Alter Gefäßschäden und eine Alzheimer-Erkrankung fast immer gemeinsam vorkommen. Andersherum gilt daher: Was gut für das Herz ist, ist auch gut für das Gehirn, also Bewegung, ausgewogene Ernährung und kein Übergewicht.
Als erstes Symptom macht sich häufig die Vergesslichkeit bemerkbar. Dadurch, dass das durchschnittliche Erkrankungsalter bei 78 Jahren liegt, werde diese häufig als Alterserscheinung bagatellisiert, erklärt Tenter. Bis zu einem gewissen Grad sei diese auch normal. Man höre von Angehörigen, dass die betroffenen Verwandten bestimmte Dinge anders machen als vorher, „nicht mehr so ordentlich Kontoauszüge oder Rechnungen ablegen, Sachen sammeln, die man früher für wertlos gehalten hat, anfangen, sich körperlich zu vernachlässigen, ohne dass es selbstkritisch bemerkt wird, oder dass sie nicht mehr planen können und keine Fantasie mehr haben.“
Diese Beobachtungen seien wichtig für die Diagnose, erklärt Tenter. Daneben gibt es psychologische Tests, die Gedächtnis, Denkvermögen, Sprache und Wahrnehmungsfähigkeit der Betroffenen prüfen. Zusätzlich können Laboruntersuchungen des Nervenwassers oder Computer- und Magnetresonanztomografie die Diagnose bestätigen. Wichtig sei laut Tenter, dass die Symptome mindestens ein halbes Jahr bestehen, da auch andere Krankheiten, beispielsweise eine schwere Depression oder eine Schädel-Hirn-Verletzung, einige Symptome hervorrufen können, wie zum Beispiel Aufmerksamkeitsstörungen und einen verminderten Antrieb.

Im fortgeschrittenen Stadium sind die Betroffenen auf fremde Hilfe angewiesen. Foto: dpa
Schließen
Schwierige Suche nach Heilmittel
Schwierige Suche nach Heilmittel

Derzeit gibt es noch kein Medikament gegen Alzheimer. Foto: dpa
Vollbild
Ist die Diagnose gestellt, beginnt die Behandlung. „Es gibt aber derzeit kein Medikament, das diese Krankheit stoppen kann“, erzählt Lutz Frölich, Professor am Zentralinstitut für seelische Gesundheit in Mannheim und Leiter einer Alzheimer-Studie für das Pharmaunternehmen Boehringer Ingelheim. „Zugelassene Medikamente können den Verlauf abmildern und dafür sorgen, dass die Patienten sich besser fühlen, aber letztlich sind sie nur symptomatisch wirksam.“ Diese Medikamente verbessern die Informationsübertragung der beiden Nervenbotenstoffe Acetylcholin und Glutamat. „Doch die Effekte, die sie hervorbringen, sind irgendwann so gering, dass sie nicht mehr relevant sind“, erklärt Frölich.
Die Forschung nach einem Heilmittel gestaltet sich schwierig. Das Gehirn sei ein sehr komplexes Organ, durch den langen Krankheitsverlauf brauche man lange Beobachtungzeiten bei klinischen Studien. Derzeit halte man an der Hypothese fest, dass die Amyloid-Ablagerungen die zentrale Ursache der Hirnschädigung sind. „Man hat keine bessere Idee bisher“, sagt der Psychiater. Daher versuche man, Angriffspunkte zu entwickeln, um die Fehlverarbeitung dieses Eiweißes zu unterbinden. Zudem untersucht die Forschung weitere „Störungswege“, die zu Nervenzelluntergängen führen. Mediziner versuchen, Nervenwachstumsfaktoren auszumachen, die das Gehirn stärken können.
Doch obwohl „viele 10 000 Wissenschaftler versuchen, etwas Neues zu finden“ und die Alzheimer-Forschung „eines der wichtigsten Felder neurobiologischer Krankheitsforschung“ sei, ist eine Vorhersage, wann es ein Heilmittel geben könnte, schwierig. Selbst zunächst vielversprechende Entwicklungen wie das vom US-Pharmakonzern Eli Lilly erprobte Mittel Solanezumab erwiesen sich als wirkungslos.
Die Forschung nach einem Heilmittel gestaltet sich schwierig. Das Gehirn sei ein sehr komplexes Organ, durch den langen Krankheitsverlauf brauche man lange Beobachtungzeiten bei klinischen Studien. Derzeit halte man an der Hypothese fest, dass die Amyloid-Ablagerungen die zentrale Ursache der Hirnschädigung sind. „Man hat keine bessere Idee bisher“, sagt der Psychiater. Daher versuche man, Angriffspunkte zu entwickeln, um die Fehlverarbeitung dieses Eiweißes zu unterbinden. Zudem untersucht die Forschung weitere „Störungswege“, die zu Nervenzelluntergängen führen. Mediziner versuchen, Nervenwachstumsfaktoren auszumachen, die das Gehirn stärken können.
Doch obwohl „viele 10 000 Wissenschaftler versuchen, etwas Neues zu finden“ und die Alzheimer-Forschung „eines der wichtigsten Felder neurobiologischer Krankheitsforschung“ sei, ist eine Vorhersage, wann es ein Heilmittel geben könnte, schwierig. Selbst zunächst vielversprechende Entwicklungen wie das vom US-Pharmakonzern Eli Lilly erprobte Mittel Solanezumab erwiesen sich als wirkungslos.

Derzeit gibt es noch kein Medikament gegen Alzheimer. Foto: dpa
Schließen
Ein guter Schritt
Ein guter Schritt
Vollbild
Fortschritte mache die Wissenschaft laut Frölich vor allem bei diagnostischen Verfahren. „Die Forschung hat viele Dinge entwickelt, die helfen, die Krankheit mit hoher Sicherheit zu erkennen.“ Das sei „ein guter Schritt“. Bis 2025, wie es der ehemalige US-Präsident Barack Obama einmal als Ziel ausgegeben hatte, werde es jedoch keine Heilung geben.
Die Krankheit Alzheimer wird also aller Voraussicht nach auch bei Marianne Kauschwitz nicht aufzuhalten sein. „Ich habe mich damit abgefunden“, sagt ihr Mann. Er werde jetzt bald Urlaub machen, alleine. Seine Frau wird in einer Kurzzeitpflege-Einrichtung auf ihn warten. Vielleicht wird sie nicht viel sagen, wenn ihr Mann sie nach seinem Urlaub wieder abholt. Dafür wird sie aber vermutlich ein Lied anstimmen.
Die Krankheit Alzheimer wird also aller Voraussicht nach auch bei Marianne Kauschwitz nicht aufzuhalten sein. „Ich habe mich damit abgefunden“, sagt ihr Mann. Er werde jetzt bald Urlaub machen, alleine. Seine Frau wird in einer Kurzzeitpflege-Einrichtung auf ihn warten. Vielleicht wird sie nicht viel sagen, wenn ihr Mann sie nach seinem Urlaub wieder abholt. Dafür wird sie aber vermutlich ein Lied anstimmen.
Schließen
Die Versorgung von Älteren
So werden die älteren und pflegebedürftigen Menschen in unserer Region versorgt
- Tuttlingen:
„Psychisch Kranke sind teilweise Familienterroristen“
- Bermatingen: Wie aus einem Besuchsdienst Freundschaft wird
- Inzigkofen: Nachbarschaftshilfe erspart manchem das Heim
- Bad Waldsee: Gemeinsam für andere
- Leutkirch: Für Senioren gibt es ein vielfältiges Angebot
- Altshausen: Damit auch Menschen mit Einschränkung am Leben teilhaben können
- Lindau: Selbstständiges Leben im Alter ist ausbaubar
- Wangen im Allgäu: Für Hilfe machen die Bürger mobil
- Bermatingen: Wie aus einem Besuchsdienst Freundschaft wird
- Inzigkofen: Nachbarschaftshilfe erspart manchem das Heim
- Bad Waldsee: Gemeinsam für andere
- Leutkirch: Für Senioren gibt es ein vielfältiges Angebot
- Altshausen: Damit auch Menschen mit Einschränkung am Leben teilhaben können
- Lindau: Selbstständiges Leben im Alter ist ausbaubar
- Wangen im Allgäu: Für Hilfe machen die Bürger mobil
Diabetes trifft immer öfter junge Menschen
Diabetes trifft immer öfter junge Menschen
Immer mehr Kinder und Jugendliche erkranken an Diabetes Typ 1 – Reha-Maßnahmen in Fachklinik sind hilfreich
Von Barbara Waldvogel
Von Barbara Waldvogel
Langer Weg bis zur Diagnose
Langer Weg bis zur Diagnose

Bis zu achtmal misst die 16-jährige Lena täglich ihren Blutzucker. Foto: Barbara Waldvogel
Vollbild
Lenas Fahrt nach Scheidegg im Allgäu fühlt sich an wie ein Kurzurlaub. An schönen Tagen begleitet die majestätische Alpenkulisse den Besucher auf dem Weg zu der Fachklinik Prinzregent Luitpold in einem verborgenen Winkel außerhalb des bayerischen Kurorts. Das Haus war vor Jahrzehnten Ziel vieler Lungenkranker, die bei klarer Luft und ungetrübter Sonne in 900 Metern Höhe auf Besserung hofften.
Heute ist dort eine moderne Fachklinik untergebracht, die sich unter anderem auch auf die Rehabilitation von Kindern und Jugendlichen mit Diabetes spezialisiert hat. Derzeit sind 14 Jungen und Mädchen mit Diabetes Typ 1 in der Obhut von Ärzten, Therapeuten, Schwestern und Erziehern. Auch Lena gehört dazu.
Sie ist ein 16 Jahre alter, aufgeweckter Teeny, der gerne lacht und offen über seine Krankheit spricht. Mit sechs Jahren erkrankte das Mädchen an Typ 1 Diabetes, doch bis zur Diagnose war ein weiter Weg. Die Eltern brachten das Kind zu verschiedenen Ärzten. Ohne Erfolg. Lena verlor Gewicht, hatte viel Durst, war häufig müde, und dann machte sich dieser seltsame Aceton-Geruch bemerkbar, ein Zeichen dafür, dass ein Insulinmangel besteht.
Als sich die Eltern nicht mehr zu helfen wussten, fuhren sie mit ihrer kleinen Tochter in die Klinik nach Rosenheim. Lena kam in lebensbedrohlichem Zustand sofort auf die Intensivstation. Dort war dann die Diagnose klar: Das Kind hat Diabetes.
Heute ist dort eine moderne Fachklinik untergebracht, die sich unter anderem auch auf die Rehabilitation von Kindern und Jugendlichen mit Diabetes spezialisiert hat. Derzeit sind 14 Jungen und Mädchen mit Diabetes Typ 1 in der Obhut von Ärzten, Therapeuten, Schwestern und Erziehern. Auch Lena gehört dazu.
Sie ist ein 16 Jahre alter, aufgeweckter Teeny, der gerne lacht und offen über seine Krankheit spricht. Mit sechs Jahren erkrankte das Mädchen an Typ 1 Diabetes, doch bis zur Diagnose war ein weiter Weg. Die Eltern brachten das Kind zu verschiedenen Ärzten. Ohne Erfolg. Lena verlor Gewicht, hatte viel Durst, war häufig müde, und dann machte sich dieser seltsame Aceton-Geruch bemerkbar, ein Zeichen dafür, dass ein Insulinmangel besteht.
Als sich die Eltern nicht mehr zu helfen wussten, fuhren sie mit ihrer kleinen Tochter in die Klinik nach Rosenheim. Lena kam in lebensbedrohlichem Zustand sofort auf die Intensivstation. Dort war dann die Diagnose klar: Das Kind hat Diabetes.

Bis zu achtmal misst die 16-jährige Lena täglich ihren Blutzucker. Foto: Barbara Waldvogel
Schließen
Das Krankheitsbild ist oft sehr verschleiert
Das Krankheitsbild ist oft sehr verschleiert

Blutzuckerwerte messen, Insulin spritzen, Broteinheiten wiegen - das gehört zum Alltag von Diabetes Typ 1. Foto: Archiv
Vollbild
Es folgte ein dreiwöchiger Klinikaufenthalt, in dem Lena und ihre Eltern geschult wurden. Denn Diabetes Typ 1 ist keine vorübergehende Erscheinung, er zählt zu den nicht heilbaren chronischen Erkrankungen. Die ganze Familie lernte Blutzuckerwerte messen, Insulin spritzen, Broteinheiten wiegen und vieles mehr. „Das ist eine Zäsur. Das verändert das Leben über Nacht“, erklärt Uta Faller, Kinderärztin und Kinderdiabetologin am Elisabethenkrankenhaus in Ravensburg.
Sie erlebt diese Situation häufig, denn jedes Jahr zählt sie rund 20 bis 30 Neuerkrankungen bei Kindern aus den Landkreisen Ravensburg, Biberach, Bodenseekreis und Sigmaringen. Dabei ist die Diagnose bei kleinen Kindern nicht einfach. „Das Krankheitsbild ist oft sehr verschleiert. Die Kinder sind kränklich, haben häufig Infekte und nehmen ab. Es bedarf großer Aufmerksamkeit, um den Diabetes festzustellen“, sagt die Ärztin, deren jüngster Patient mit Diabetes Typ 1 im vergangenen Jahr ein zehn Monate altes Baby war.
Während des Aufenthalts in dem von der Deutschen Diabetes Gesellschaft (DDG) zertifizierten Schulungs- und Behandlungszentrum bekommen Patienten und Angehörige eine Komplexschulung innerhalb von zehn bis 14 Tagen, bei der neben der medizinischen Betreuung auch die Diabetes-, Ernährungs- und Sozialberatung eingeschlossen ist. Auch die Kinder- und Jugendpsychiaterin gehört dazu. Alle Bemühungen zielen darauf ab, dass der Patient nach der Diagnose ein möglichst normales Leben führen kann.
Sie erlebt diese Situation häufig, denn jedes Jahr zählt sie rund 20 bis 30 Neuerkrankungen bei Kindern aus den Landkreisen Ravensburg, Biberach, Bodenseekreis und Sigmaringen. Dabei ist die Diagnose bei kleinen Kindern nicht einfach. „Das Krankheitsbild ist oft sehr verschleiert. Die Kinder sind kränklich, haben häufig Infekte und nehmen ab. Es bedarf großer Aufmerksamkeit, um den Diabetes festzustellen“, sagt die Ärztin, deren jüngster Patient mit Diabetes Typ 1 im vergangenen Jahr ein zehn Monate altes Baby war.
Während des Aufenthalts in dem von der Deutschen Diabetes Gesellschaft (DDG) zertifizierten Schulungs- und Behandlungszentrum bekommen Patienten und Angehörige eine Komplexschulung innerhalb von zehn bis 14 Tagen, bei der neben der medizinischen Betreuung auch die Diabetes-, Ernährungs- und Sozialberatung eingeschlossen ist. Auch die Kinder- und Jugendpsychiaterin gehört dazu. Alle Bemühungen zielen darauf ab, dass der Patient nach der Diagnose ein möglichst normales Leben führen kann.

Blutzuckerwerte messen, Insulin spritzen, Broteinheiten wiegen - das gehört zum Alltag von Diabetes Typ 1. Foto: Archiv
Schließen
Spontanität ausgeschlossen
Spontanität ausgeschlossen

Insulinpumpe machen den Patienten flexibler. Foto: dpa
Vollbild
Doch was Diabetes im Alltag tatsächlich bedeutet, ist Nichtbetroffenen kaum bewusst: „Ein Diabetiker kann nichts spontan machen“, sagt Thomas Hermann, Chefarzt der Fachklinik in Scheidegg. „Er muss immer vorher überlegen, was und wie viel er zum Beispiel essen will, um dann entsprechend Insulin zu spritzen.“ Auch wenn er Sport treiben will, geht das nicht ohne Vorbereitung.
Lena spielt begeistert Fußball. Vor dem Training misst sie ihren Blutzucker – ist er zu hoch, dann heißt es, erst einmal spritzen und abwarten. „Sport ist für den Stoffwechsel gut, doch gerade bei Diabetes Typ 1 muss man sehr aufpassen“ sagt der Kinder- und Jugendmediziner, Psychotherapeut und Diabetologe.
Als selbstbewusstes Kind wollte Lena schon sehr früh ihre Krankheit eigenständig managen: So entschied sie sich schließlich auch für das Tragen einer Insulinpumpe. Sie gewährt eine Grundversorgung des Körpers mit Insulin. Uta Faller: „Man ist flexibler, weil man auch während oder nach dem Essen Insulin zugeben kann, wenn die Mahlzeit größer ausfällt als geplant. Außerdem erspart man sich rund 1000 Nadelstiche im Jahr.“
Vor dem Essen drückt man einen Knopf, sodass zusätzlich Insulin zugegeben wird. Es gelangt über einen kleinen Schlauch und eine Kanüle, die im Unterhautfettgewebe platziert ist, in den Körper. „Die Pumpe hat mein Leben vereinfacht“, sagt Lena, die sich aber trotzdem noch täglich bis zu achtmal in den Finger piksen muss, um einen Tropfen Blut für die nach wie vor notwendige Zuckermessung zu haben. Ein Reha-Aufenthalt war bei Lena angezeigt, weil sie mit der Pumpe nicht so gut klarkam wie früher mit der Spritze. So vergaß sie schon mal den Knopf vor dem Essen zu drücken, was ihr Körper nicht verzieh. Der Insulinbedarf stieg mächtig an, worauf sie wiederum das Gefühl hatte, stark aufgebläht zu sein.
Lena spielt begeistert Fußball. Vor dem Training misst sie ihren Blutzucker – ist er zu hoch, dann heißt es, erst einmal spritzen und abwarten. „Sport ist für den Stoffwechsel gut, doch gerade bei Diabetes Typ 1 muss man sehr aufpassen“ sagt der Kinder- und Jugendmediziner, Psychotherapeut und Diabetologe.
Als selbstbewusstes Kind wollte Lena schon sehr früh ihre Krankheit eigenständig managen: So entschied sie sich schließlich auch für das Tragen einer Insulinpumpe. Sie gewährt eine Grundversorgung des Körpers mit Insulin. Uta Faller: „Man ist flexibler, weil man auch während oder nach dem Essen Insulin zugeben kann, wenn die Mahlzeit größer ausfällt als geplant. Außerdem erspart man sich rund 1000 Nadelstiche im Jahr.“
Vor dem Essen drückt man einen Knopf, sodass zusätzlich Insulin zugegeben wird. Es gelangt über einen kleinen Schlauch und eine Kanüle, die im Unterhautfettgewebe platziert ist, in den Körper. „Die Pumpe hat mein Leben vereinfacht“, sagt Lena, die sich aber trotzdem noch täglich bis zu achtmal in den Finger piksen muss, um einen Tropfen Blut für die nach wie vor notwendige Zuckermessung zu haben. Ein Reha-Aufenthalt war bei Lena angezeigt, weil sie mit der Pumpe nicht so gut klarkam wie früher mit der Spritze. So vergaß sie schon mal den Knopf vor dem Essen zu drücken, was ihr Körper nicht verzieh. Der Insulinbedarf stieg mächtig an, worauf sie wiederum das Gefühl hatte, stark aufgebläht zu sein.

Insulinpumpe machen den Patienten flexibler. Foto: dpa
Schließen
Disziplin ist wichtig
Disziplin ist wichtig

Ziel jeder Therapie ist, dass der Patient lernt, konsequent zu spritzen und sich an die Regeln zu halten. Foto: dpa
Vollbild
Teenager mit Diabetes haben oft Angst, dick zu werden. „Insulin richtig dosiert, macht nicht dick“, sagt dagegen Kinderärztin Faller. Insulin braucht jeder Mensch, denn es ist der Schlüssel, damit der Blutzucker von den Zellen aufgenommen und in Energie umgewandelt werden kann. Eine Gewichtszunahme erfolgt zum Beispiel bei zu hohen Insulinmengen oder bei zu vielen Kalorien.
Deshalb ist das Ziel jeder Therapie, dass der Patient lernt, konsequent zu spritzen und sich an die Regeln zu halten. Das erfordert viel Disziplin, was vor allem dem Lebensgefühl Pubertierender ziemlich zuwiderläuft. Manche wollen in dieser Zeit ihre Krankheit nicht mehr akzeptieren und vernachlässigen ihre Therapie. „Diese Zeit muss man gemeinsam aushalten“, sagt Faller, die bei Bedarf noch einmal Nachschulungen anbietet.
Hilfreich sind in diesen Situationen dann eben auch Reha-Aufenthalte. „Einige unserer Kinder waren schon in Reha, für andere wurden bereits die Anträge gestellt“, erklärt Faller. Mal geht es darum, dass jemand über mehrere Wochen geschult werden muss. Mal braucht auch die Familie eine Entlastung. Für viele Jugendliche ist es auch einfach der Kontakt zu anderen jungen Diabetikern, der ihnen über schwierige Zeiten hinweghilft. „Der Prozentsatz an depressiven Erkrankungen ist bei Diabetikern deutlich höher“, sagt Thomas Hermann. Deshalb gehört die psychologische Betreuung zum Standardprogramm der Fachklinik.
Für Lena hat sich der Aufenthalt allemal gelohnt. Ihr Insulinbedarf ist zurückgegangen. Sie ist gut eingestellt, und zu Hause wird sie nach dem vierwöchigen Aufenthalt in der Schule wieder schnell Anschluss finden. Denn in Scheidegg ging sie auch in die Klinikschule. „Wenige Schüler – gute Lehrer. Das war toll“, sagt sie. Reha hat für sie jedenfalls einen guten Klang. Vielleicht führt sie ihr Weg wieder einmal nach Scheidegg. Sie wäre nicht die Einzige. Hermann: „Wir haben viele Kinder, die regelmäßig zu uns kommen.“ Und der Kontakt der jungen Leute untereinander ist auch gesichert – Whats-App sei Dank.
Deshalb ist das Ziel jeder Therapie, dass der Patient lernt, konsequent zu spritzen und sich an die Regeln zu halten. Das erfordert viel Disziplin, was vor allem dem Lebensgefühl Pubertierender ziemlich zuwiderläuft. Manche wollen in dieser Zeit ihre Krankheit nicht mehr akzeptieren und vernachlässigen ihre Therapie. „Diese Zeit muss man gemeinsam aushalten“, sagt Faller, die bei Bedarf noch einmal Nachschulungen anbietet.
Hilfreich sind in diesen Situationen dann eben auch Reha-Aufenthalte. „Einige unserer Kinder waren schon in Reha, für andere wurden bereits die Anträge gestellt“, erklärt Faller. Mal geht es darum, dass jemand über mehrere Wochen geschult werden muss. Mal braucht auch die Familie eine Entlastung. Für viele Jugendliche ist es auch einfach der Kontakt zu anderen jungen Diabetikern, der ihnen über schwierige Zeiten hinweghilft. „Der Prozentsatz an depressiven Erkrankungen ist bei Diabetikern deutlich höher“, sagt Thomas Hermann. Deshalb gehört die psychologische Betreuung zum Standardprogramm der Fachklinik.
Für Lena hat sich der Aufenthalt allemal gelohnt. Ihr Insulinbedarf ist zurückgegangen. Sie ist gut eingestellt, und zu Hause wird sie nach dem vierwöchigen Aufenthalt in der Schule wieder schnell Anschluss finden. Denn in Scheidegg ging sie auch in die Klinikschule. „Wenige Schüler – gute Lehrer. Das war toll“, sagt sie. Reha hat für sie jedenfalls einen guten Klang. Vielleicht führt sie ihr Weg wieder einmal nach Scheidegg. Sie wäre nicht die Einzige. Hermann: „Wir haben viele Kinder, die regelmäßig zu uns kommen.“ Und der Kontakt der jungen Leute untereinander ist auch gesichert – Whats-App sei Dank.

Ziel jeder Therapie ist, dass der Patient lernt, konsequent zu spritzen und sich an die Regeln zu halten. Foto: dpa
Schließen
Forscher arbeiten an einer Insulin-Impfung
Forscher arbeiten an einer Insulin-Impfung
Forscher arbeiten an einer Insulin-Impfung

Inzwischen leidet rund jeder zehnte Bundesbürger mit einer gesetzlichen Krankenversicherung an der chronischen Stoffwechselerkrankung. Grafik: Johanna Jani / dpa / Ingrid Augustin
Vollbild
In Deutschland leben weit mehr Menschen mit Diabetes als bisher geschätzt: Inzwischen leidet rund jeder zehnte Bundesbürger mit einer gesetzlichen Krankenversicherung an der chronischen Stoffwechselerkrankung, heißt es in einer neuen Analyse für den Versorgungsatlas. Danach ist der Anteil der Diabetiker zwischen 2009 und 2015 von 8,9 auf 9,8 Prozent gestiegen. Die überwiegende Mehrheit der Patienten ist an einem Diabetes Typ 2 erkrankt. Aber auch die Autoimmunkrankheit Diabetes Typ 1 nimmt zu, und besonders stark betroffen sind die ganz kleinen Kinder. Uta Faller, Kinderärztin und Kinderdiabetologin am Elisabethenkrankenhaus in Ravensburg, stellt bei Kindern eine Steigerung von vier Prozent jährlich fest. Bei Kleinkindern sogar von fünf bis sieben Prozent. Immerhin haben Kinder und Jugendliche jetzt durch das neue Flexirentengesetz einen gesetzlichen Anspruch auf eine Reha-Maßnahme in einer Fachklinik.
Zur interaktiven Grafik
Bei der Autoimmunkrankheit Diabetes Typ 1 zerstört das körpereigene Immunsystem in der Regel bereits im Kindesalter die Insulin produzierenden Betazellen in der Bauchspeicheldrüse. Ausgelöst wird die Autoimmunreaktion durch Antigene, wie zum Beispiel das Insulin selbst, die der Organismus fälschlicherweise als „Fremdkörper“ einstuft und bekämpft. Im Normalfall baut das Immunsystem dagegen in den ersten Lebensjahren eine Immuntoleranz gegen die körpereigenen Proteine auf, sodass es nicht zu einer Autoimmunreaktion kommt. Diese positive Immunantwort soll mithilfe der Insulin-Impfung „antrainiert“ werden, wie das Helmholtz-Zentrum München mitteilt.
Erste Erfolge auf dem Weg zu einer präventiven Insulin-Impfung gegen Typ-1-Diabetes verzeichnen Forschungen von Wissenschaftlern der TU Dresden, sowie des Helmholtz Zentrums in Zusammenarbeit mit Experten aus Wien, Bristol und Denver (USA). Auswertungen ihrer Pre-Point-Studie deuten auf eine positive Immunreaktion bei Risikopersonen hin. Für die Studie wurden Kinder mit einem hohen Erkrankungsrisiko für Typ-1-Diabetes durchschnittlich ein halbes Jahr einmal täglich mit oralem Insulin behandelt. Die Gruppe nahm das Insulin in ansteigender Dosis als Pulver zusammen mit der Nahrung ein. In der höchsten Dosis (67,5 mg) rief das Insulinpulver schließlich die gewünschte Immunantwort hervor. (bawa)
Weitere Infos unter
www.klinikprinzregentluitpold.de u
www.oberschwabenklinik.de
Zur interaktiven Grafik
Bei der Autoimmunkrankheit Diabetes Typ 1 zerstört das körpereigene Immunsystem in der Regel bereits im Kindesalter die Insulin produzierenden Betazellen in der Bauchspeicheldrüse. Ausgelöst wird die Autoimmunreaktion durch Antigene, wie zum Beispiel das Insulin selbst, die der Organismus fälschlicherweise als „Fremdkörper“ einstuft und bekämpft. Im Normalfall baut das Immunsystem dagegen in den ersten Lebensjahren eine Immuntoleranz gegen die körpereigenen Proteine auf, sodass es nicht zu einer Autoimmunreaktion kommt. Diese positive Immunantwort soll mithilfe der Insulin-Impfung „antrainiert“ werden, wie das Helmholtz-Zentrum München mitteilt.
Erste Erfolge auf dem Weg zu einer präventiven Insulin-Impfung gegen Typ-1-Diabetes verzeichnen Forschungen von Wissenschaftlern der TU Dresden, sowie des Helmholtz Zentrums in Zusammenarbeit mit Experten aus Wien, Bristol und Denver (USA). Auswertungen ihrer Pre-Point-Studie deuten auf eine positive Immunreaktion bei Risikopersonen hin. Für die Studie wurden Kinder mit einem hohen Erkrankungsrisiko für Typ-1-Diabetes durchschnittlich ein halbes Jahr einmal täglich mit oralem Insulin behandelt. Die Gruppe nahm das Insulin in ansteigender Dosis als Pulver zusammen mit der Nahrung ein. In der höchsten Dosis (67,5 mg) rief das Insulinpulver schließlich die gewünschte Immunantwort hervor. (bawa)
Weitere Infos unter
www.klinikprinzregentluitpold.de u
www.oberschwabenklinik.de

Inzwischen leidet rund jeder zehnte Bundesbürger mit einer gesetzlichen Krankenversicherung an der chronischen Stoffwechselerkrankung. Grafik: Johanna Jani / dpa / Ingrid Augustin
Schließen
Glutenfrei ernähren - Notwendigkeit oder Trend?
Glutenfrei ernähren – Notwendigkeit oder Trend?
Von Katja Waizenegger
Lady Gaga tut es, Gwyneth Paltrow – und Hannelore Kraft: Sie ernähren sich glutenfrei, verzichten also auf Getreide. Die Gründe für diesen Verzicht sind allerdings unterschiedlich. Während die nordrhein-westfälische Ministerpräsidentin Kraft an Zöliakie leidet, einer Glutenunverträglichkeit, werben die amerikanischen Ladys für glutenfreie Ernährung, weil sie ihrer Meinung nach gesünder ist. Doch ist sie das tatsächlich? Oder liegt glutenfreie Ernährung lediglich im Trend? Wie so oft gibt es nicht die eine gültige Antwort. Denn tatsächlich hat sich in den vergangenen Jahren unter Medizinern die Erkenntnis durchgesetzt, dass auch Menschen, die keine Zöliakie haben, unter einer Unverträglichkeit von Weizen leiden können.
Lady Gaga tut es, Gwyneth Paltrow – und Hannelore Kraft: Sie ernähren sich glutenfrei, verzichten also auf Getreide. Die Gründe für diesen Verzicht sind allerdings unterschiedlich. Während die nordrhein-westfälische Ministerpräsidentin Kraft an Zöliakie leidet, einer Glutenunverträglichkeit, werben die amerikanischen Ladys für glutenfreie Ernährung, weil sie ihrer Meinung nach gesünder ist. Doch ist sie das tatsächlich? Oder liegt glutenfreie Ernährung lediglich im Trend? Wie so oft gibt es nicht die eine gültige Antwort. Denn tatsächlich hat sich in den vergangenen Jahren unter Medizinern die Erkenntnis durchgesetzt, dass auch Menschen, die keine Zöliakie haben, unter einer Unverträglichkeit von Weizen leiden können.
Einer von 100 leidet an der Autoimmunerkrankung leidet
Einer von 100 leidet an der Autoimmunerkrankung leidet

Zöliakie-Patienten müssen sich streng glutenfrei ernähren. Foto: dpa
Vollbild
„Wir finden in unserer Praxis alle zwei bis drei Wochen einen Zöliakie-Patienten“, bestätigt der Leutkircher Internist und Gastroenterologe Roland Graf die Zunahme von Diagnosen dieser Autoimmunerkrankung in den letzten zehn Jahren. Internisten und die Pathologen hätten in diesem Bereich viel dazugelernt. Tatsächlich ist es so, dass es bei Beschwerden wie Blähungen und Durchfall nicht mehr so lange dauert wie noch vor Jahren, bis eine Diagnose gestellt wird. Bereits eine Blutabnahme gefolgt von einer Dünndarmbiopsie kann eindeutig Auskunft geben, ob eine Zöliakie vorliegt oder nicht.
Schwieriger wird es, wenn die Beschwerden nicht eindeutig dem Magen-Darm-Trakt zuzuordnen sind. Wie Bianca Maurer, Ernährungsmanagerin bei der Deutschen Zöliakie Gesellschaft (DZG) in Stuttgart, sagt: Auch unklare Beschwerden wie Depressionen, Muskelschwäche, Osteoporose und vieles mehr können durch eine Zöliakie ausgelöst werden. Die DZG geht heute davon aus, dass einer von Hundert an der Autoimmunerkrankung leidet, welche die Zotten des Dünndarms schädigt. „Zöliakie-Patienten müssen sich auf jeden Fall streng glutenfrei ernähren. Denn durch eine permanente Entzündung im Dünndarm steigt die Gefahr von bösartigen Lymphomen, also einem Tumor“, so Roland Graf.
Schwieriger wird es, wenn die Beschwerden nicht eindeutig dem Magen-Darm-Trakt zuzuordnen sind. Wie Bianca Maurer, Ernährungsmanagerin bei der Deutschen Zöliakie Gesellschaft (DZG) in Stuttgart, sagt: Auch unklare Beschwerden wie Depressionen, Muskelschwäche, Osteoporose und vieles mehr können durch eine Zöliakie ausgelöst werden. Die DZG geht heute davon aus, dass einer von Hundert an der Autoimmunerkrankung leidet, welche die Zotten des Dünndarms schädigt. „Zöliakie-Patienten müssen sich auf jeden Fall streng glutenfrei ernähren. Denn durch eine permanente Entzündung im Dünndarm steigt die Gefahr von bösartigen Lymphomen, also einem Tumor“, so Roland Graf.

Zöliakie-Patienten müssen sich streng glutenfrei ernähren. Foto: dpa
Schließen
Nachweis über Haut- und Bluttests
Nachweis über Haut- und Bluttests

Nachweisen lässt sich eine Weizenallergie mit Haut- und Bluttests. Foto: dpa
Vollbild
Aber wie sieht es bei den Patienten aus, bei denen keine Zöliakie festgestellt wird, die aber Beschwerden haben, wenn sie Getreide essen? Was ein Arzt heute auch relativ zweifelsfrei belegen kann, ist eine Weizenallergie. Die Symptome reichen von Quaddeln, Atemnot bis zu Magen-Darm-Beschwerden. Nachweisen lässt sich eine Weizenallergie mit Haut- und Bluttests, jedoch nicht bei einer Magenspiegelung, wie Graf betont. Wichtig ist für die Ernährungswissenschaftlerin Maurer die klare Abgrenzung zur Zöliakie: „Viele Weizenallergiker vertragen Roggen oder Gerste, welche wegen des enthaltenen Glutens bei Zöliakie tabu sind. Auf der anderen Seite können sie Produkte mit glutenfreier Weizenstärke nicht essen.“ Aus dem Grund sei die Bezeichnung „glutenfrei“ auf Lebensmitteln für Weizenallergiker kein ausreichendes Kriterium.
Bislang am umstrittensten und oft als eingebildete Krankheit belächelt, ist die sogenannte Weizensensitivität. „Wenn ein Patient Beschwerden hat und es ihm spontan bessergeht, sobald er auf Weizen verzichtet, kann man von einer Weizensensitivität ausgehen“, bestätigt Graf. Allerdings lässt sich die Weizensensitivität derzeit im Labor noch nicht nachweisen. Die einzige Möglichkeit der Diagnose ist eine Ausschlussdiät, also: den Weizen weglassen und genau beobachten, was passiert. Bianca Maurer von der DZG betont allerdings, dass man diese Ausschlussdiät nur machen sollte, wenn die oben beschriebenen Krankheiten von einem Arzt ausgeschlossen wurden. Und auch dann sollte ein Arzt den Verlauf begleiten.
Bislang am umstrittensten und oft als eingebildete Krankheit belächelt, ist die sogenannte Weizensensitivität. „Wenn ein Patient Beschwerden hat und es ihm spontan bessergeht, sobald er auf Weizen verzichtet, kann man von einer Weizensensitivität ausgehen“, bestätigt Graf. Allerdings lässt sich die Weizensensitivität derzeit im Labor noch nicht nachweisen. Die einzige Möglichkeit der Diagnose ist eine Ausschlussdiät, also: den Weizen weglassen und genau beobachten, was passiert. Bianca Maurer von der DZG betont allerdings, dass man diese Ausschlussdiät nur machen sollte, wenn die oben beschriebenen Krankheiten von einem Arzt ausgeschlossen wurden. Und auch dann sollte ein Arzt den Verlauf begleiten.

Nachweisen lässt sich eine Weizenallergie mit Haut- und Bluttests. Foto: dpa
Schließen
Völliger Verzicht nicht notwendig
Völliger Verzicht nicht notwendig

Auch in der Region gibt es zahlreiche Bäckereien mit glutenfreiem Sortiment.
Vollbild
Einen völligen Glutenverzicht hält Detlef Schuppan von der Uni Mainz, einer der führenden deutschen Forscher auf dem Gebiet der Weizensensitivität, nicht für notwendig. Schuppan hat die für die Sensitivität verantwortlichen ATIs (Amylase-Trypsin-Inhibitoren), bestimmte Eiweiße im Getreide, 2014 in seinen Forschungen erstmals benannt. Und herausgefunden, dass ältere Getreidesorten wie Dinkel und Roggen grundsätzlich weniger ATIs enthalten und somit bei Weizensensitivität auf ihre Verträglichkeit getestet werden können.
„Es gibt mittlerweile allerdings eine große Gruppe in der Bevölkerung, die dem Irrglauben unterliegt, sich glutenfrei zu ernähren sei grundsätzlich gesünder“, sagt Bianca Maurer. Sie würden sich davon eine Gewichtsabnahme oder sonstige gesundheitliche Vorteile versprechen. Dabei, betont sie, seien vor allem glutenfreie Fertigprodukte oft mit viel Zucker und einfachen Kohlenhydraten hergestellt. Wer also mit keiner der drei Krankheiten beziehungsweise Unverträglichkeiten zu kämpfen habe, solle nicht auf Gluten verzichten, so die klare Linie der DZG. Zu einer grundsätzlichen Reduzierung der Kohlenhydrate rät Roland Graf allerdings ohnehin: Gemüse, Fleisch, Fisch, Obst, Milchprodukte, Eier sollten seiner Meinung nach die wesentlichen Bestandteile der Ernährung bilden, ob in einer glutenfreien oder glutenhaltigen Ernährung.
Zur interaktiven Karte
„Es gibt mittlerweile allerdings eine große Gruppe in der Bevölkerung, die dem Irrglauben unterliegt, sich glutenfrei zu ernähren sei grundsätzlich gesünder“, sagt Bianca Maurer. Sie würden sich davon eine Gewichtsabnahme oder sonstige gesundheitliche Vorteile versprechen. Dabei, betont sie, seien vor allem glutenfreie Fertigprodukte oft mit viel Zucker und einfachen Kohlenhydraten hergestellt. Wer also mit keiner der drei Krankheiten beziehungsweise Unverträglichkeiten zu kämpfen habe, solle nicht auf Gluten verzichten, so die klare Linie der DZG. Zu einer grundsätzlichen Reduzierung der Kohlenhydrate rät Roland Graf allerdings ohnehin: Gemüse, Fleisch, Fisch, Obst, Milchprodukte, Eier sollten seiner Meinung nach die wesentlichen Bestandteile der Ernährung bilden, ob in einer glutenfreien oder glutenhaltigen Ernährung.
Zur interaktiven Karte

Auch in der Region gibt es zahlreiche Bäckereien mit glutenfreiem Sortiment.
Schließen
Unterschiedliche Krankheitsbilder
Unterschiedliche Krankheitsbilder
Vollbild
Die Medizin unterscheidet derzeit drei Krankheitsbilder, bei denen ein Verzicht auf Getreide ganz oder zum Teil empfohlen wird:
- Eine Zöliakie diagnostiziert man mit einem Bluttest und einer Dünndarmspiegelung. Bei einer eindeutigen Diagnose muss lebenslang eine glutenfreie Diät eingehalten werden. Die Häufigkeit in der Bevölkerung liegt bei 1:100.
- Ob jemand an einer Weizenallergie leidet, kann der Arzt an Antigenen im Blut feststellen. Dinkel wird oft auch nicht vertragen, da es dem Weizen zu ähnlich ist. Auch die Bezeichnung „glutenfrei“ ist für Weizenallergiker nicht ausschlaggebend, da diese Produkte glutenfreie Weizenstärke enthalten können.
- Die erst in jüngerer Zeit in den Fokus geratene Weizensensitivität lässt sich derzeit noch nicht nachweisen. Die Diagnose erfolgt über eine Ausschluss-Diät, bei der man auf Weizen verzichtet. Die oben genannten Krankheiten sollten allerdings zuvor ausgeschlossen werden. Die Toleranz gegenüber Weizen kann variieren, das heißt, es ist nicht immer ein kompletter Verzicht notwendig. (kawa)
- Eine Zöliakie diagnostiziert man mit einem Bluttest und einer Dünndarmspiegelung. Bei einer eindeutigen Diagnose muss lebenslang eine glutenfreie Diät eingehalten werden. Die Häufigkeit in der Bevölkerung liegt bei 1:100.
- Ob jemand an einer Weizenallergie leidet, kann der Arzt an Antigenen im Blut feststellen. Dinkel wird oft auch nicht vertragen, da es dem Weizen zu ähnlich ist. Auch die Bezeichnung „glutenfrei“ ist für Weizenallergiker nicht ausschlaggebend, da diese Produkte glutenfreie Weizenstärke enthalten können.
- Die erst in jüngerer Zeit in den Fokus geratene Weizensensitivität lässt sich derzeit noch nicht nachweisen. Die Diagnose erfolgt über eine Ausschluss-Diät, bei der man auf Weizen verzichtet. Die oben genannten Krankheiten sollten allerdings zuvor ausgeschlossen werden. Die Toleranz gegenüber Weizen kann variieren, das heißt, es ist nicht immer ein kompletter Verzicht notwendig. (kawa)
Schließen
Infektionskrankheiten
Professor Thomas Mertens: „Impfpflicht ist politisch nicht durchsetzbar“
Der Ulmer Professor Thomas Mertens, Vorsitzender der Ständigen Impfkommission (STIKO) in Deutschland, geht davon aus, dass hierzulande einige Tausend Menschen pro Jahr an einer Grippeinfektion sterben – sehr viel mehr als die offiziell registrierten. Dass Impfen in Deutschland zur Pflicht wird, erwartet der Arzt und Virologe nicht. Eine Impfpflicht würde „alle Impfgegner zu Märtyrern machen“, sagte er.
Von Claudia Kling
Von Claudia Kling
Globalisierung verändert Ausbreitung und Häufigkeit von Viren
Globalisierung verändert Ausbreitung und Häufigkeit von Viren

„Das Phänomen, dass ein Virus tötet, ist sozusagen die Folge mangelnder Anpassung“, sagt Professor Thomas Mertens, Ärztlicher Direktor der Abteilung Virologie am Universitätsklinikum Ulm. Der Experte für Herpesviren ist seit vergangener Woche auch Vorsitzender der Ständigen Impfkommission (STIKO) am Robert-Koch-Institut. Foto: Simon Haas
Vollbild
Herr Professor Mertens, wie würden Sie Ihr Verhältnis zu Viren beschreiben?
Viren sind ein sehr interessantes Arbeitsgebiet, weil sie relativ einfache Strukturen haben und man an ihnen wesentliche grundlegende Mechanismen untersuchen kann, die an komplexen Lebewesen schwerer zu untersuchen wären. Viren sind aber natürlich auch Krankheitserreger – vom Schnupfen bis zur Ebola-Epidemie – und daher von größter medizinischer Bedeutung.
Haben Viren auch Vorteile für den Menschen? Oder anders gefragt: Gibt es auch etwas Gutes, was man über sie sagen könnte?
Es gibt ernst zu nehmende Wissenschaftler, die davon ausgehen, dass die Entwicklung des Menschen und der Arten, durchaus von Viren beeinflusst wurde. Manche Viren haben die Möglichkeit, genetisches Material von einer Stelle zu einer anderen zu transportieren, bei den Retroviren ist dies beispielsweise der Fall. Insofern ist es absolut möglich, dass Viren in der Evolution eine positive Rolle gespielt haben.
Viren sind aufgrund der Globalisierung ja sehr reiselustig geworden. Führt das zu neuen Gefahren für uns?
Natürlich hat die Globalisierung die Folge, dass sich die Ausbreitung und Häufigkeit von Viren verändern. Nehmen Sie das SARS-Virus, das in China von Schleichkatzen auf den Menschen übertragen wurde und innerhalb weniger Wochen zu einer weltweiten Epidemie geführt hat. Das wäre in der Zeit, als man mit Pferd und Wagen oder lange mit Schiffen unterwegs war, nicht möglich gewesen.
Viren sind ein sehr interessantes Arbeitsgebiet, weil sie relativ einfache Strukturen haben und man an ihnen wesentliche grundlegende Mechanismen untersuchen kann, die an komplexen Lebewesen schwerer zu untersuchen wären. Viren sind aber natürlich auch Krankheitserreger – vom Schnupfen bis zur Ebola-Epidemie – und daher von größter medizinischer Bedeutung.
Haben Viren auch Vorteile für den Menschen? Oder anders gefragt: Gibt es auch etwas Gutes, was man über sie sagen könnte?
Es gibt ernst zu nehmende Wissenschaftler, die davon ausgehen, dass die Entwicklung des Menschen und der Arten, durchaus von Viren beeinflusst wurde. Manche Viren haben die Möglichkeit, genetisches Material von einer Stelle zu einer anderen zu transportieren, bei den Retroviren ist dies beispielsweise der Fall. Insofern ist es absolut möglich, dass Viren in der Evolution eine positive Rolle gespielt haben.
Viren sind aufgrund der Globalisierung ja sehr reiselustig geworden. Führt das zu neuen Gefahren für uns?
Natürlich hat die Globalisierung die Folge, dass sich die Ausbreitung und Häufigkeit von Viren verändern. Nehmen Sie das SARS-Virus, das in China von Schleichkatzen auf den Menschen übertragen wurde und innerhalb weniger Wochen zu einer weltweiten Epidemie geführt hat. Das wäre in der Zeit, als man mit Pferd und Wagen oder lange mit Schiffen unterwegs war, nicht möglich gewesen.

„Das Phänomen, dass ein Virus tötet, ist sozusagen die Folge mangelnder Anpassung“, sagt Professor Thomas Mertens, Ärztlicher Direktor der Abteilung Virologie am Universitätsklinikum Ulm. Der Experte für Herpesviren ist seit vergangener Woche auch Vorsitzender der Ständigen Impfkommission (STIKO) am Robert-Koch-Institut. Foto: Simon Haas
Schließen
Die meisten Viren leben in Koexistenz mit uns
Die meisten Viren leben in Koexistenz mit uns

Der Vogelgrippevirus hat vor allem die Situation für die Geflügelzuchtbetriebe verändert. Foto: dpa
Vollbild
Hier im Südwesten von Baden-Württemberg beschäftigt uns auch die Vogelgrippe. Wie riskant ist dieses Virus für uns?
Durch das aktuelle Vogelgrippevirus hat sich vor allem die Situation für die Geflügelzuchtbetriebe verändert. Sie wurden durch die Stallpflicht gezwungen, ihre Tiere so zu halten, dass sie nicht mit dem Kot vorbeifliegender Zugvögel in Berührung kommen konnten. Denn wenn ein Influenza-Virus in einen Zuchtbetrieb eindringt, müssen mitunter Tausende Tiere getötet werden, das gab es ja bereits mehrfach.
Und wie hoch ist das Risiko, dass das Vogelgrippevirus, wie in Asien bereits geschehen, auf den Menschen überspringt?
Diese Fälle in Asien resultierten mit Sicherheit aus dem sehr engen Zusammenleben von Vögeln und Menschen. Dann kann es zu Infektionen kommen. Aber es gibt auch die Möglichkeit, dass sich Viren verändern – und zwar so, dass sie sowohl vom Tier auf den Menschen als auch von Mensch zu Mensch übertragen werden können. Eine solche Mutation kann zu einem großen Problem werden, da es gegen diese veränderten Viren keine Basisimmunität in der Bevölkerung gibt. 1918 beim Ausbruch der Spanischen Grippe, die mindestens 25 Millionen Menschen das Leben gekostet hat, war das der Fall.
Wieso sind manche Viren ansteckender als andere?
Dies hängt von vielen Faktoren ab. Wenn infizierte Menschen sofort Symptome zeigen, ist es einfacher, die Infektionskette zu unterbrechen. Sie schicken den Infizierten in ein Einzelzimmer – und schützen so die Gesunden. Schwieriger ist die Lage, wenn der Infizierte bereits Viren ausscheidet, aber keine Symptome zeigt – beispielsweise bei HIV, Influenza, und vielen Hepatitis-Infektionen ist das so. In diesen Fällen hat das Virus bessere Möglichkeiten, sich auszubreiten.
Auch die Sterblichkeitsrate ist bei Viruserkrankungen sehr unterschiedlich. Den Infizierten zu töten kann doch aber nicht im Interesse des Virus sein?
Ist es auch nicht. Die meisten Viren, beispielsweise die Herpesviren, bringen uns nicht um, sondern leben in Koexistenz mit uns. Das Virus will sich eigentlich nur vermehren und übertragen werden. Und je länger ein Virus in seiner Wirtspopulation zu Hause ist, umso weniger macht es krank. Es könnte sein, dass HIV die Menschen in ein paar Hunderttausend Jahren auch nicht mehr krank macht – so wie es seiner ursprünglichen Affenpopulation nicht mehr schadet. Das Phänomen, dass ein Virus tötet, ist sozusagen die Folge mangelnder Anpassung.
Durch das aktuelle Vogelgrippevirus hat sich vor allem die Situation für die Geflügelzuchtbetriebe verändert. Sie wurden durch die Stallpflicht gezwungen, ihre Tiere so zu halten, dass sie nicht mit dem Kot vorbeifliegender Zugvögel in Berührung kommen konnten. Denn wenn ein Influenza-Virus in einen Zuchtbetrieb eindringt, müssen mitunter Tausende Tiere getötet werden, das gab es ja bereits mehrfach.
Und wie hoch ist das Risiko, dass das Vogelgrippevirus, wie in Asien bereits geschehen, auf den Menschen überspringt?
Diese Fälle in Asien resultierten mit Sicherheit aus dem sehr engen Zusammenleben von Vögeln und Menschen. Dann kann es zu Infektionen kommen. Aber es gibt auch die Möglichkeit, dass sich Viren verändern – und zwar so, dass sie sowohl vom Tier auf den Menschen als auch von Mensch zu Mensch übertragen werden können. Eine solche Mutation kann zu einem großen Problem werden, da es gegen diese veränderten Viren keine Basisimmunität in der Bevölkerung gibt. 1918 beim Ausbruch der Spanischen Grippe, die mindestens 25 Millionen Menschen das Leben gekostet hat, war das der Fall.
Wieso sind manche Viren ansteckender als andere?
Dies hängt von vielen Faktoren ab. Wenn infizierte Menschen sofort Symptome zeigen, ist es einfacher, die Infektionskette zu unterbrechen. Sie schicken den Infizierten in ein Einzelzimmer – und schützen so die Gesunden. Schwieriger ist die Lage, wenn der Infizierte bereits Viren ausscheidet, aber keine Symptome zeigt – beispielsweise bei HIV, Influenza, und vielen Hepatitis-Infektionen ist das so. In diesen Fällen hat das Virus bessere Möglichkeiten, sich auszubreiten.
Auch die Sterblichkeitsrate ist bei Viruserkrankungen sehr unterschiedlich. Den Infizierten zu töten kann doch aber nicht im Interesse des Virus sein?
Ist es auch nicht. Die meisten Viren, beispielsweise die Herpesviren, bringen uns nicht um, sondern leben in Koexistenz mit uns. Das Virus will sich eigentlich nur vermehren und übertragen werden. Und je länger ein Virus in seiner Wirtspopulation zu Hause ist, umso weniger macht es krank. Es könnte sein, dass HIV die Menschen in ein paar Hunderttausend Jahren auch nicht mehr krank macht – so wie es seiner ursprünglichen Affenpopulation nicht mehr schadet. Das Phänomen, dass ein Virus tötet, ist sozusagen die Folge mangelnder Anpassung.

Der Vogelgrippevirus hat vor allem die Situation für die Geflügelzuchtbetriebe verändert. Foto: dpa
Schließen
Impfpflicht ist politisch nicht durchsetzbar
Impfpflicht ist politisch nicht durchsetzbar

Ampullen mit Grippe-Impfstoff. Foto: dpa
Vollbild
Allein durch das Grippevirus sind in diesem Jahr Hunderte Menschen gestorben …
Wahrscheinlich sind noch viel mehr Menschen an der Grippe gestorben, die wurden aber nicht registriert, weil sie vielleicht ohnehin schon alt und gebrechlich waren. Man geht von einigen Tausend Influenza-Toten pro Jahr aus – selbst bei Epidemien mit vergleichsweise harmlosen Influenza-Viren.
Sind die Impfvorschriften in Deutschland zu lasch?
Impfen ist zwar die sinnvollste medizinische Methode überhaupt, die wir ergreifen können, aber eine Impfpflicht ist in Deutschland politisch nicht durchsetzbar. Sie würde alle Impfgegner zu Märtyrern machen. Selbst eine indirekte Impfpflicht, wie es sie in den USA gibt, wäre bei uns nicht zu vermitteln. Dort kann Kindern und Jugendlichen beispielsweise die Aufnahme in einen Kindergarten oder in eine Schule verwehrt werden, wenn sie nicht geimpft sind. Die Politiker in Deutschland werden sich nicht an eine Impfpflicht wagen – trotz der gelegentlichen abweichenden Äußerungen eines Ministers.
Aber müsste man Kinder nicht besser vor ihren Eltern schützen, wenn sie unverbesserliche Impfverweigerer sind?
Sie müssen bedenken: Es gibt bei jeder medizinischen Maßnahme auch Nebenwirkungen. Die sind zwar bei Impfungen extrem selten, dennoch wäre es schwierig, Impfungen gegen den Willen der Eltern durchzusetzen. Dazu kommt: Krankheiten wie Polio und Diphtherie treten bei uns nicht mehr auf. Auch das beeinflusst das Bewusstsein und damit die Akzeptanz von Impfungen. Wenn Kinder plötzlich wieder an Diphtherie sterben würden, wäre die Impfbereitschaft sehr viel höher. Aber so nehmen Eltern einseitig das Risiko von Nebenwirkungen wahr.
Wahrscheinlich sind noch viel mehr Menschen an der Grippe gestorben, die wurden aber nicht registriert, weil sie vielleicht ohnehin schon alt und gebrechlich waren. Man geht von einigen Tausend Influenza-Toten pro Jahr aus – selbst bei Epidemien mit vergleichsweise harmlosen Influenza-Viren.
Sind die Impfvorschriften in Deutschland zu lasch?
Impfen ist zwar die sinnvollste medizinische Methode überhaupt, die wir ergreifen können, aber eine Impfpflicht ist in Deutschland politisch nicht durchsetzbar. Sie würde alle Impfgegner zu Märtyrern machen. Selbst eine indirekte Impfpflicht, wie es sie in den USA gibt, wäre bei uns nicht zu vermitteln. Dort kann Kindern und Jugendlichen beispielsweise die Aufnahme in einen Kindergarten oder in eine Schule verwehrt werden, wenn sie nicht geimpft sind. Die Politiker in Deutschland werden sich nicht an eine Impfpflicht wagen – trotz der gelegentlichen abweichenden Äußerungen eines Ministers.
Aber müsste man Kinder nicht besser vor ihren Eltern schützen, wenn sie unverbesserliche Impfverweigerer sind?
Sie müssen bedenken: Es gibt bei jeder medizinischen Maßnahme auch Nebenwirkungen. Die sind zwar bei Impfungen extrem selten, dennoch wäre es schwierig, Impfungen gegen den Willen der Eltern durchzusetzen. Dazu kommt: Krankheiten wie Polio und Diphtherie treten bei uns nicht mehr auf. Auch das beeinflusst das Bewusstsein und damit die Akzeptanz von Impfungen. Wenn Kinder plötzlich wieder an Diphtherie sterben würden, wäre die Impfbereitschaft sehr viel höher. Aber so nehmen Eltern einseitig das Risiko von Nebenwirkungen wahr.

Ampullen mit Grippe-Impfstoff. Foto: dpa
Schließen
Risikoeinschätzung der Menschen ist meist völlig irrational
Risikoeinschätzung der Menschen ist meist völlig irrational

An der SSPE, die vor allem dann auftritt, wenn Kinder sehr früh mit Masern infiziert wurden, sterben mit Sicherheit mehr Menschen in Deutschland als durch terroristische Anschläge. Foto: dpa
Vollbild
Woran liegt es, dass im süddeutschen Raum die Impfquote gerade bei Masern im bundesweiten Vergleich eher niedrig ist?
Das ist ein komplexes Problem. Es hängt auch damit zusammen, dass alle Gesundheitsmaßnahmen im Grunde genommen Ländersache sind. Bayern beispielsweise hat das Impfen auf die Hausärzteschaft verlegt und den öffentlichen Gesundheitsdienst stark aus diesem Bereich herausgenommen. Und es ist vielleicht auch eine Mentalitätssache, wie stark sich der Staat in die Gesundheitsvorsorge des jeweiligen Bundeslandes einmischt.
Das Problem bei Masern sind ja nicht nur die tödlich verlaufenden Krankheitsfälle und dass Babys in den ersten Lebensmonaten nicht geimpft werden können. Das Problem sind ja auch Spätfolgen wie die chronische Gehirnentzündung (SSPE). Wird das unterschätzt?
An der SSPE, die vor allem dann auftritt, wenn Kinder sehr früh mit Masern infiziert wurden, sterben mit Sicherheit mehr Menschen in Deutschland als durch terroristische Anschläge. Aber die Risikoeinschätzung der Menschen ist meist völlig irrational.
Inzwischen weiß man, dass Viren auch Krebs verursachen können. Hat dies die Forschung bislang unterschätzt?
Das bekannteste Beispiel für die Entstehung von Krebs durch Viren ist der Gebärmutterhalskrebs nach der Infektion mit Papillomviren. Die Weltgesundheitsorganisation geht inzwischen davon aus, dass 20 bis 25 Prozent der menschlichen Tumore in einem Zusammenhang mit Virusinfektionen stehen. Und ich bin davon überzeugt, dass wir weitere Erkrankungen finden werden, bei denen Infektionen mit Viren eine Rolle spielen.
Werden diese Erkenntnisse dazu beitragen, Krebserkrankungen künftig verhindern zu können?
Bei den Papillomviren, die der deutsche Nobelpreisträger Harald zur Hausen als Krebsursache erkannt hat, könnte das ja bereits funktionieren. Es gibt einen Impfstoff, der diese Erkrankung verhindert. Das Problem ist nur, dass er in Deutschland viel zu wenig akzeptiert ist. Die Durchimpfungsrate liegt bei 40 Prozent.
Das ist ein komplexes Problem. Es hängt auch damit zusammen, dass alle Gesundheitsmaßnahmen im Grunde genommen Ländersache sind. Bayern beispielsweise hat das Impfen auf die Hausärzteschaft verlegt und den öffentlichen Gesundheitsdienst stark aus diesem Bereich herausgenommen. Und es ist vielleicht auch eine Mentalitätssache, wie stark sich der Staat in die Gesundheitsvorsorge des jeweiligen Bundeslandes einmischt.
Das Problem bei Masern sind ja nicht nur die tödlich verlaufenden Krankheitsfälle und dass Babys in den ersten Lebensmonaten nicht geimpft werden können. Das Problem sind ja auch Spätfolgen wie die chronische Gehirnentzündung (SSPE). Wird das unterschätzt?
An der SSPE, die vor allem dann auftritt, wenn Kinder sehr früh mit Masern infiziert wurden, sterben mit Sicherheit mehr Menschen in Deutschland als durch terroristische Anschläge. Aber die Risikoeinschätzung der Menschen ist meist völlig irrational.
Inzwischen weiß man, dass Viren auch Krebs verursachen können. Hat dies die Forschung bislang unterschätzt?
Das bekannteste Beispiel für die Entstehung von Krebs durch Viren ist der Gebärmutterhalskrebs nach der Infektion mit Papillomviren. Die Weltgesundheitsorganisation geht inzwischen davon aus, dass 20 bis 25 Prozent der menschlichen Tumore in einem Zusammenhang mit Virusinfektionen stehen. Und ich bin davon überzeugt, dass wir weitere Erkrankungen finden werden, bei denen Infektionen mit Viren eine Rolle spielen.
Werden diese Erkenntnisse dazu beitragen, Krebserkrankungen künftig verhindern zu können?
Bei den Papillomviren, die der deutsche Nobelpreisträger Harald zur Hausen als Krebsursache erkannt hat, könnte das ja bereits funktionieren. Es gibt einen Impfstoff, der diese Erkrankung verhindert. Das Problem ist nur, dass er in Deutschland viel zu wenig akzeptiert ist. Die Durchimpfungsrate liegt bei 40 Prozent.

An der SSPE, die vor allem dann auftritt, wenn Kinder sehr früh mit Masern infiziert wurden, sterben mit Sicherheit mehr Menschen in Deutschland als durch terroristische Anschläge. Foto: dpa
Schließen
Impfungen: Sinnvoll oder schädlich?
Warum kommt es in Deutschland immer wieder zu Masern-Epidemien? Welche Rolle spielen dabei Migranten? Und ist Impfen gefährlich?
Wir haben mit Prof. Dr. Thomas Mertens, Vorsitzender der Ständigen Impfkommission (STIKO) und Virologe am Uni-Klinikum Ulm, über die umstrittene Sechsfachimpfung bei Kindern und mögliche Impfschäden gesprochen.
Wir haben mit Prof. Dr. Thomas Mertens, Vorsitzender der Ständigen Impfkommission (STIKO) und Virologe am Uni-Klinikum Ulm, über die umstrittene Sechsfachimpfung bei Kindern und mögliche Impfschäden gesprochen.
Krankenhauskeime
Heike von Baum: „Wir alle tragen häufiger solche Keime im Körper als früher“
In Deutschland sterben pro Jahr 15.000 Menschen, weil sie sich im Krankenhaus mit einem multiresistenten Keim infiziert haben. Das zeigen Hochrechnungen des Nationalen Referenzzentrums zur Überwachung von Krankenhausinfektionen.
Im Gespräch erläutert Professorin Heike von Baum, wie gefährlich die Keime sind und was Patienten tun können, um sich zu schützen. Die Medizinerin leitet die Sektion für Klinikhygiene an der Uniklinik Ulm. Dort steckten sich 2016 zwei Patienten bei einem Dritten mit den Erregern an.
Von Katja Korf
Im Gespräch erläutert Professorin Heike von Baum, wie gefährlich die Keime sind und was Patienten tun können, um sich zu schützen. Die Medizinerin leitet die Sektion für Klinikhygiene an der Uniklinik Ulm. Dort steckten sich 2016 zwei Patienten bei einem Dritten mit den Erregern an.
Von Katja Korf
Keime lassen sich nicht mit herkömmlichen Antibiotika behandeln
Keime lassen sich nicht mit herkömmlichen Antibiotika behandeln

Heike von Baum. Foto: privat
Vollbild
Was ist das Gefährliche an multiresistenten Keimen (MRE)?
Bei dem Thema muss man etwas Wichtiges unterscheiden: Mit bestimmten Erregern infiziert man sich und wird direkt akut krank – also beispielsweise bei Masern oder Grippe. Bei multiresistenten Keimen ist das anders. Sie besiedeln viele Menschen, leben dort auf der Haut, den Schleimhäuten oder im Darm. Aber sie machen uns nicht unbedingt krank, sondern nur in bestimmten Situationen, etwa wenn unser Immunsystem ohnehin geschwächt ist. Viele Menschen leben jahrelang damit, ohne zu erkranken. Außerdem bedeutet multiresistent: Solche Keime lassen sich nicht mit herkömmlichen Antibiotika behandeln. Deshalb sind von ihnen ausgelöste Infektionen mitunter schlechter zu therapieren.
Was passiert, wenn eine solche Infektion ausbricht?
Grundsätzlich gibt es in vielen Fällen auf den Patienten zugeschnittene Therapien. Dennoch sollte man das Problem auch nicht verharmlosen. Im Einzelfall kann eine Infektion mit resistenten Keimen zu einer sehr komplexen Behandlung mit einem gewissen Risiko führen, daran zu sterben.
Muss ich als Patient in jedem Krankenhaus damit rechnen?
Was wir leider bedenken müssen: Wir alle tragen häufiger solche Keime im Körper als früher, vor allem in der Darmflora, obwohl wir vielleicht nie im Krankenhaus waren. Das ist kein alleiniges Problem der Krankenhäuser wie noch vor einigen Jahren. Sondern man bringt den Keim zum Beispiel von einer Fernreise mit. Inzwischen gibt es sehr viele unterschiedliche resistente Erreger. Darunter sind wenige, die man sich nur im Krankenhaus einfängt. Das Risiko, sich damit zu infizieren, ist in bestimmten Regionen der Erde sehr viel höher als in Deutschland – etwa auf der arabischen Halbinsel oder in Griechenland. Wenn man sehr oft im Krankenhaus ist oder sehr häufig Antibiotika nimmt, ist man gefährdeter.
Bei dem Thema muss man etwas Wichtiges unterscheiden: Mit bestimmten Erregern infiziert man sich und wird direkt akut krank – also beispielsweise bei Masern oder Grippe. Bei multiresistenten Keimen ist das anders. Sie besiedeln viele Menschen, leben dort auf der Haut, den Schleimhäuten oder im Darm. Aber sie machen uns nicht unbedingt krank, sondern nur in bestimmten Situationen, etwa wenn unser Immunsystem ohnehin geschwächt ist. Viele Menschen leben jahrelang damit, ohne zu erkranken. Außerdem bedeutet multiresistent: Solche Keime lassen sich nicht mit herkömmlichen Antibiotika behandeln. Deshalb sind von ihnen ausgelöste Infektionen mitunter schlechter zu therapieren.
Was passiert, wenn eine solche Infektion ausbricht?
Grundsätzlich gibt es in vielen Fällen auf den Patienten zugeschnittene Therapien. Dennoch sollte man das Problem auch nicht verharmlosen. Im Einzelfall kann eine Infektion mit resistenten Keimen zu einer sehr komplexen Behandlung mit einem gewissen Risiko führen, daran zu sterben.
Muss ich als Patient in jedem Krankenhaus damit rechnen?
Was wir leider bedenken müssen: Wir alle tragen häufiger solche Keime im Körper als früher, vor allem in der Darmflora, obwohl wir vielleicht nie im Krankenhaus waren. Das ist kein alleiniges Problem der Krankenhäuser wie noch vor einigen Jahren. Sondern man bringt den Keim zum Beispiel von einer Fernreise mit. Inzwischen gibt es sehr viele unterschiedliche resistente Erreger. Darunter sind wenige, die man sich nur im Krankenhaus einfängt. Das Risiko, sich damit zu infizieren, ist in bestimmten Regionen der Erde sehr viel höher als in Deutschland – etwa auf der arabischen Halbinsel oder in Griechenland. Wenn man sehr oft im Krankenhaus ist oder sehr häufig Antibiotika nimmt, ist man gefährdeter.

Heike von Baum. Foto: privat
Schließen
Handdesinfektion ist ganz wichtig
Handdesinfektion ist ganz wichtig

Viele Patienten bringen den Keim mit ins Krankenhaus. Foto: dpa
Vollbild
Viele Patienten bringen den Keim also mit ins Krankenhaus. Was kann man dagegen tun?
Wir testen Risikopatienten bei ihrer Aufnahme ins Krankenhaus. Dabei werden mit einem Wattetupfer Abstriche aus Mund und Nase genommen. So erkennen wir die MRSA-Erreger, die seit mehr als 50 Jahren auftreten. Außerdem bitten wir seit einiger Zeit auch um einen Abstrich aus der Analregion. So wollen wir erkennen, ob jemand mit multiresistenten Darmbakterien (MRGN) besiedelt ist. Diese kommen erst seit einigen Jahren vor. Abhängig von Erregern und Patient ergreifen wir dann Schutzmaßnahmen.
Welche sind das?
Je nach Keim legen wir betroffene Patienten zum Beispiel in ein Einzelzimmer. Ärzte und Schwestern tragen Schutzkleidung. Auch Besucher werden dazu aufgefordert. Außerdem ist die Handdesinfektion ganz wichtig: Egal welcher Keim, keiner überlebt dieses Desinfektionsmittel.
Kann ein mit solchen Keimen besiedelter Patient diese loswerden?
Bei den MRSA, die sich in Mund und Nase ansiedeln, geht das. Man kann durch Körperwaschungen oder mit Nasensalben die Keime abtöten. Erreger, die im Darm sitzen, verschwinden oft, wenn sich die Gesundheit eines Patienten wieder stabilisiert. Ansonsten kann man sie zunächst nicht loswerden. Würde man sie mit Antibiotika bekämpfen, verschlimmert man ja das Problem.
Sind diese Erreger auf dem Vormarsch und warum?
Es ist noch nicht ganz geklärt, wie man solche Keime erwirbt. Es gibt Berichte, dass sie in bestimmten Ländern in der Nahrung und im Trinkwasser sind. Außerdem können Erreger, die häufig mit Antibiotika behandelt werden, selbstständig Resistenzen entwickeln. Es gibt auch starke Hinweise darauf, dass die verstärkte Behandlung von Tieren mit Antibiotika eine Rolle spielt.
Wir testen Risikopatienten bei ihrer Aufnahme ins Krankenhaus. Dabei werden mit einem Wattetupfer Abstriche aus Mund und Nase genommen. So erkennen wir die MRSA-Erreger, die seit mehr als 50 Jahren auftreten. Außerdem bitten wir seit einiger Zeit auch um einen Abstrich aus der Analregion. So wollen wir erkennen, ob jemand mit multiresistenten Darmbakterien (MRGN) besiedelt ist. Diese kommen erst seit einigen Jahren vor. Abhängig von Erregern und Patient ergreifen wir dann Schutzmaßnahmen.
Welche sind das?
Je nach Keim legen wir betroffene Patienten zum Beispiel in ein Einzelzimmer. Ärzte und Schwestern tragen Schutzkleidung. Auch Besucher werden dazu aufgefordert. Außerdem ist die Handdesinfektion ganz wichtig: Egal welcher Keim, keiner überlebt dieses Desinfektionsmittel.
Kann ein mit solchen Keimen besiedelter Patient diese loswerden?
Bei den MRSA, die sich in Mund und Nase ansiedeln, geht das. Man kann durch Körperwaschungen oder mit Nasensalben die Keime abtöten. Erreger, die im Darm sitzen, verschwinden oft, wenn sich die Gesundheit eines Patienten wieder stabilisiert. Ansonsten kann man sie zunächst nicht loswerden. Würde man sie mit Antibiotika bekämpfen, verschlimmert man ja das Problem.
Sind diese Erreger auf dem Vormarsch und warum?
Es ist noch nicht ganz geklärt, wie man solche Keime erwirbt. Es gibt Berichte, dass sie in bestimmten Ländern in der Nahrung und im Trinkwasser sind. Außerdem können Erreger, die häufig mit Antibiotika behandelt werden, selbstständig Resistenzen entwickeln. Es gibt auch starke Hinweise darauf, dass die verstärkte Behandlung von Tieren mit Antibiotika eine Rolle spielt.

Viele Patienten bringen den Keim mit ins Krankenhaus. Foto: dpa
Schließen
Luft nach oben beim Screening der Patienten
Luft nach oben beim Screening der Patienten

In solchen Regionen kommen bestimmte Erreger häufiger vor als in Deutschland. Foto: dpa
Vollbild
Einige wenige Keime kommen aber weiter nur in Krankenhäusern vor?
Ja. Patienten, die sehr lange bei uns sind und beatmet werden, erhalten auch lange Antibiotika. Sie können als Konsequenz Resistenzen entwickeln. Außerdem gibt es bestimmte Patientengruppen, bei denen sich multiresistente Keime länger im Körper halten. Das sind beispielsweise Patienten mit chronischen Erkrankungen, die häufig Antibiotika erhalten.
Hat es Einfluss auf die Verbreitung multiresistenter Keime, dass derzeit viele Menschen aus anderen Ländern nach Deutschland kommen?
Viele Flüchtlinge sind besiedelt, weil sie aus Hochrisikogebieten kommen – aber nicht, weil sie flüchten. In solchen Regionen kommen bestimmte Erreger häufiger vor als bei uns. Deshalb sind in diesen Gruppen mehr Menschen mit MRE besiedelt als in der Durchschnittsbevölkerung in Deutschland. Wir würden aber nie empfehlen, jeden zu screenen, der aus einem solchen Gebiet nach Deutschland kommt. Denn die Wahrscheinlichkeit, solche Keime zu haben, ist nur dann sehr hoch, wenn man dort etwa im Krankenhaus war.
Gibt es Probleme im System, die Ausbrüche begünstigen?
Es ist gut, dass mittlerweile Dinge wie etwa ein Hygienebeauftragter in allen Kliniken gesetzlich vorgeschrieben sind. Allerdings gibt es Luft nach oben beim Screening der Patienten. Das könnten selbstverständlich auch die Hausärzte tun. Aber dafür müssten wie beim MRSA auch andere MRE-Screenings erstattungsfähig sein. Das ist derzeit noch nicht optimal geregelt. Es wäre gut, wenn Hausärzte dann Patienten bereits auf MRE testen könnten, bevor sie diese etwa zu geplanten Operationen in ein Krankenhaus überweisen. Es geht auch nicht darum, die Betroffenen dann abzuweisen, sondern sich einfach optimal auf diese Patienten vorzubereiten.
Was kann ich als Patient tun?
Sehr viel. Vor geplanten Eingriffen sollte man mehr auf sich achten: weniger Rauchen, weniger Alkohol trinken, sich ein bisschen gesünder ernähren. Das hilft dem Immunsystem und stärkt etwa die Lunge, die bei einer Beatmung während einer Operation stärker beansprucht wird als im Alltag. Außerdem sollte man – wenn man dazu nicht zu krank ist – auf seine Körperhygiene achten: regelmäßig duschen, genug Leibwäsche mitnehmen ins Krankenhaus. Die Hände desinfizieren. Und man sollte Besuchern sagen: Wenn du krank bist, komm bitte nicht.
Ja. Patienten, die sehr lange bei uns sind und beatmet werden, erhalten auch lange Antibiotika. Sie können als Konsequenz Resistenzen entwickeln. Außerdem gibt es bestimmte Patientengruppen, bei denen sich multiresistente Keime länger im Körper halten. Das sind beispielsweise Patienten mit chronischen Erkrankungen, die häufig Antibiotika erhalten.
Hat es Einfluss auf die Verbreitung multiresistenter Keime, dass derzeit viele Menschen aus anderen Ländern nach Deutschland kommen?
Viele Flüchtlinge sind besiedelt, weil sie aus Hochrisikogebieten kommen – aber nicht, weil sie flüchten. In solchen Regionen kommen bestimmte Erreger häufiger vor als bei uns. Deshalb sind in diesen Gruppen mehr Menschen mit MRE besiedelt als in der Durchschnittsbevölkerung in Deutschland. Wir würden aber nie empfehlen, jeden zu screenen, der aus einem solchen Gebiet nach Deutschland kommt. Denn die Wahrscheinlichkeit, solche Keime zu haben, ist nur dann sehr hoch, wenn man dort etwa im Krankenhaus war.
Gibt es Probleme im System, die Ausbrüche begünstigen?
Es ist gut, dass mittlerweile Dinge wie etwa ein Hygienebeauftragter in allen Kliniken gesetzlich vorgeschrieben sind. Allerdings gibt es Luft nach oben beim Screening der Patienten. Das könnten selbstverständlich auch die Hausärzte tun. Aber dafür müssten wie beim MRSA auch andere MRE-Screenings erstattungsfähig sein. Das ist derzeit noch nicht optimal geregelt. Es wäre gut, wenn Hausärzte dann Patienten bereits auf MRE testen könnten, bevor sie diese etwa zu geplanten Operationen in ein Krankenhaus überweisen. Es geht auch nicht darum, die Betroffenen dann abzuweisen, sondern sich einfach optimal auf diese Patienten vorzubereiten.
Was kann ich als Patient tun?
Sehr viel. Vor geplanten Eingriffen sollte man mehr auf sich achten: weniger Rauchen, weniger Alkohol trinken, sich ein bisschen gesünder ernähren. Das hilft dem Immunsystem und stärkt etwa die Lunge, die bei einer Beatmung während einer Operation stärker beansprucht wird als im Alltag. Außerdem sollte man – wenn man dazu nicht zu krank ist – auf seine Körperhygiene achten: regelmäßig duschen, genug Leibwäsche mitnehmen ins Krankenhaus. Die Hände desinfizieren. Und man sollte Besuchern sagen: Wenn du krank bist, komm bitte nicht.

In solchen Regionen kommen bestimmte Erreger häufiger vor als in Deutschland. Foto: dpa
Schließen
Krankenhäuser in der Region
Krankenhäuser in der Region

Vollbild
Wer soll das bezahlen? Die Krankenhausfinanzierung ist immer wieder ein Politikum. An manchen Kliniken sollen die Betten reduziert werden, andere Standorte sogar dicht gemacht werden.
Diese Karte bietet einen Überblick über die Krankenhäuser der Region, die die allgemeine Gesundheitsversorgung übernehmen - samt der jeweiligen Bettenzahl und einen Link zur Bewertung der Weißen Liste.
Nicht abgebildet sind die oft privat betriebenen Spezialkliniken, die sich nur auf eines oder wenige Behandlungsfelder konzentrieren.
Zur interaktiven Karte
Diese Karte bietet einen Überblick über die Krankenhäuser der Region, die die allgemeine Gesundheitsversorgung übernehmen - samt der jeweiligen Bettenzahl und einen Link zur Bewertung der Weißen Liste.
Nicht abgebildet sind die oft privat betriebenen Spezialkliniken, die sich nur auf eines oder wenige Behandlungsfelder konzentrieren.
Zur interaktiven Karte

Schließen
Salmonellen durch Reptilien
Küssen verboten
Übelkeit, Kopfschmerzen und schlimmer Durchfall – wer damit zum Arzt geht und gefragt wird, ob er vielleicht eine Schlange im Haushalt habe, macht wohl auf dem Absatz wieder kehrt. Doch die Frage ist begründet: Viele Reptilien tragen exotische Salmonellenstämme in ihrem Verdauungstrakt. Rutschen oder laufen die Tiere dann aber über ihren eigenen Kot, gelangen die Bakterien auf deren Haut – und damit schnell zum Menschen. Besonders für kleine Kinder kann das gefährlich werden.
Von Karin Geupel
Von Karin Geupel
Gefährliches Kuscheln
Gefährliches Kuscheln

Salmonellen in einer Petrischale. Foto: dpa
Vollbild
Den Reptilien selbst macht ihre Salmonelleninfektion in der Regel nichts aus. Daher können Reptilienhalter ohne spezielle Untersuchung nicht feststellen, ob ihr Tier betroffen ist oder nicht. Oft sind ganze Züchtungen von den gleichen Salmonellen befallen. Die Tiere geben die Bakterien auch auf Reptilienmessen oder im Handel an andere weiter. Sogar andere Haustiere wie Katzen oder Hunde können sich bei den Reptilien anstecken – und die Erreger dann beim Kuscheln an die Halter weitergeben.
Während gesunde Erwachsene sich nur mit den sehr unangenehmen Folgen einer Salmonellenerkrankung herumschlagen müssen, kann die Infektion für Kinder unter zwei Jahren und alte Menschen lebensbedrohlich sein. Weil das Immunsystem in diesen Altersgruppen schwächer ist, erkranken sie besonders schnell. In seltenen Fällen kann das auch zum Tod führen. In Österreich starb beispielsweise ein einjähriges Kind an einer Salmonelleninfektion. In der Familie lebten auch ein Waran und ein Blauzungenskink. „Das Kind hatte zwei Salmonellen. Im Herzblut wurden andere Salmonellen festgestellt als im Darm. Und beide hat man auch bei den Reptilien gefunden“, erzählt Wolfgang Rabsch, Experte für Salmonellen am Robert-Koch-Institut (RKI) in Wernigerode (Sachsen-Anhalt). Dorthin werden die exotischen Salmonellenstämme, von den Experten auch Serovare genannt, geschickt, wenn andere Labore sie zuvor nicht bestimmen konnten. Die Stämme tragen Namen wie Salmonella Johannisbourg oder Salmonella Minnesota, je nach dem Ort ihrer Entdeckung. Durch die genaue Bestimmung und ihre exotische Herkunft können die Experten des RKI zuordnen, ob die Salmonellenerkrankung von einem Lebensmittel stammt oder von einem Reptil.
Die allermeisten Salmonelleninfektionen werden immer noch durch verseuchte Lebensmittel ausgelöst. Doch die Anzahl der Infektionen durch Reptilien steigt, sagt Rabsch. Laut den neuesten Zahlen aus dem Jahr 2015 wurden insgesamt rund 900 Fälle von Salmonellenerkrankungen bei unter Zweijährigen in Deutschland gemeldet. 210 davon wurden zur näheren Bestimmung zum RKI geschickt. 84 Fälle waren schließlich Salmonellenstämmen zuzuordnen, die wohl von Reptilien übertragen wurden. Immerhin fast zehn Prozent aller Erkrankungen bei unter Zweijährigen also. 2012 lag diese Quote noch bei rund acht Prozent. Die Fälle verteilen sich über ganz Deutschland. Auch in Staig bei Laupheim wurde ein neun Monate altes Kind von einer Bartagame mit den Bakterien angesteckt.
Während gesunde Erwachsene sich nur mit den sehr unangenehmen Folgen einer Salmonellenerkrankung herumschlagen müssen, kann die Infektion für Kinder unter zwei Jahren und alte Menschen lebensbedrohlich sein. Weil das Immunsystem in diesen Altersgruppen schwächer ist, erkranken sie besonders schnell. In seltenen Fällen kann das auch zum Tod führen. In Österreich starb beispielsweise ein einjähriges Kind an einer Salmonelleninfektion. In der Familie lebten auch ein Waran und ein Blauzungenskink. „Das Kind hatte zwei Salmonellen. Im Herzblut wurden andere Salmonellen festgestellt als im Darm. Und beide hat man auch bei den Reptilien gefunden“, erzählt Wolfgang Rabsch, Experte für Salmonellen am Robert-Koch-Institut (RKI) in Wernigerode (Sachsen-Anhalt). Dorthin werden die exotischen Salmonellenstämme, von den Experten auch Serovare genannt, geschickt, wenn andere Labore sie zuvor nicht bestimmen konnten. Die Stämme tragen Namen wie Salmonella Johannisbourg oder Salmonella Minnesota, je nach dem Ort ihrer Entdeckung. Durch die genaue Bestimmung und ihre exotische Herkunft können die Experten des RKI zuordnen, ob die Salmonellenerkrankung von einem Lebensmittel stammt oder von einem Reptil.
Die allermeisten Salmonelleninfektionen werden immer noch durch verseuchte Lebensmittel ausgelöst. Doch die Anzahl der Infektionen durch Reptilien steigt, sagt Rabsch. Laut den neuesten Zahlen aus dem Jahr 2015 wurden insgesamt rund 900 Fälle von Salmonellenerkrankungen bei unter Zweijährigen in Deutschland gemeldet. 210 davon wurden zur näheren Bestimmung zum RKI geschickt. 84 Fälle waren schließlich Salmonellenstämmen zuzuordnen, die wohl von Reptilien übertragen wurden. Immerhin fast zehn Prozent aller Erkrankungen bei unter Zweijährigen also. 2012 lag diese Quote noch bei rund acht Prozent. Die Fälle verteilen sich über ganz Deutschland. Auch in Staig bei Laupheim wurde ein neun Monate altes Kind von einer Bartagame mit den Bakterien angesteckt.

Salmonellen in einer Petrischale. Foto: dpa
Schließen
Artgerechter Umgang mit den Tieren
Artgerechter Umgang mit den Tieren

Die Kinder sollten Reptilien anschauen, aber nicht anfassen. Foto: dpa
Vollbild
Dass sich ein Kind bei einem Reptil ansteckt, liege vor allem an unsachgemäßer Haltung, sind sich Rabsch und Nicolá Lutzmann, Vizepräsident der Deutschen Gesellschaft für Herpetologie und Terrarienkunde (DGHT) einig. „Reptilien in das Kinderbettchen zu legen, nur weil das auf dem Foto so gut aussieht, ist nicht artgerecht“, sagt Lutzmann. Er glaubt aber, dass die meisten Reptilienhalter sich der Salmonellengefahr bewusst seien. „Bevor man sich so ein Tier anschafft, informiert man sich und liest zumindest mal ein Buch.“ Zudem weise die DGHT in einer Infobroschüre und in ihrer Mitgliederzeitschrift regelmäßig auf die Thematik hin.
Während der Forscher Rabsch empfiehlt, in Haushalten mit Kindern unter fünf Jahren gar keine Reptilien zu halten, vertraut Lutzmann auf artgerechten Umgang mit den Tieren. „Reptilien sind nicht die klassischen Haustiere mit denen man kuscheln oder denen man ein Küsschen geben sollte“, sagt er. Händewaschen sei nach dem Umgang mit Reptilien selbstverständlich. Auch sollten Pinzetten oder Lappen, die zur Pflege und Fütterung benutzt werden, streng getrennt von anderen Haushaltsgegenständen aufbewahrt werden. Und das Wichtigste: „Die Kinder können die Reptilien anschauen, aber nicht anfassen“, sagt Lutzmann. Würden diese Sicherheitsvorkehrungen eingehalten, wäre nicht nur das Ansteckungsrisiko sehr gering, auch die Tiere würden dann nicht unter der unsachgemäßen Haltung leiden.
Während der Forscher Rabsch empfiehlt, in Haushalten mit Kindern unter fünf Jahren gar keine Reptilien zu halten, vertraut Lutzmann auf artgerechten Umgang mit den Tieren. „Reptilien sind nicht die klassischen Haustiere mit denen man kuscheln oder denen man ein Küsschen geben sollte“, sagt er. Händewaschen sei nach dem Umgang mit Reptilien selbstverständlich. Auch sollten Pinzetten oder Lappen, die zur Pflege und Fütterung benutzt werden, streng getrennt von anderen Haushaltsgegenständen aufbewahrt werden. Und das Wichtigste: „Die Kinder können die Reptilien anschauen, aber nicht anfassen“, sagt Lutzmann. Würden diese Sicherheitsvorkehrungen eingehalten, wäre nicht nur das Ansteckungsrisiko sehr gering, auch die Tiere würden dann nicht unter der unsachgemäßen Haltung leiden.

Die Kinder sollten Reptilien anschauen, aber nicht anfassen. Foto: dpa
Schließen
Tod durch Sepsis
Bei einer Blutvergiftung zählt jede Minute
Der 83-Jährige hatte letztlich Glück, er konnte das Krankenhaus nach wenigen Tagen wieder verlassen. Doch seine eitrige Entzündung an einem Zahn, die hohes Fieber und leichte Bewusstseinsstörungen verursachte, hätte auch anders enden können: tödlich. Der Mann kam rechtzeitig ins Krankenhaus, wo er mit Infusionen und einem Antibiotikum behandelt wurde. Das hat ihn womöglich davor bewahrt, dass aus seiner Infektion eine Sepsis wurde.
Von Claudia Kling
Von Claudia Kling
Blutvergiftung ist eine Untergruppe der Sepsis
Blutvergiftung ist eine Untergruppe der Sepsis

Das geschieht bei einer Sepsis. Grafik: Johanna Jani / Apotheken Umschau / dpa
Vollbild
„Das Risiko, an einer Sepsis zu sterben, steigt innerhalb von Stunden, wenn sie nicht erkannt wird“, sagt Professor Michael Bauer vom Universitätsklinikum Jena, der zudem Sprecher des „Centers for Sepsis Control and Care“ (CSCC) ist. Deshalb sei es so wichtig, ein schärferes Bewusstsein für die Symptome einer Sepsis zu entwickeln – bei Herzinfarkt und Schlaganfall sei dies in den vergangenen Jahren geglückt. „Inzwischen weiß jeder Laie, dass Schmerzen im linken Arm mit dem Herzen zusammenhängen können“, sagt Bauer.
Auch bei Sepsis-Patienten gibt es typische Symptome, die ein Hausarzt, vielleicht sogar ein Angehöriger des Patienten, erkennen könnte: Bewusstseinsstörungen, eine beschleunigte Atmung und der Abfall des Blutdrucks sind die deutlichsten frühzeitigen Symptome – das haben Studien mit mehreren Hunderttausend Patienten in den USA und in Deutschland ergeben. Und natürlich das Gefühl des Patienten, schwer erkrankt zu sein. Auch Schüttelfrost und Rötungen gehörten zu den Symptomen.
Obwohl die Erkrankung so gefährlich ist, können viele Menschen nicht einmal mit dem Namen Sepsis etwas anfangen. Gebräuchlicher ist hierzulande der Begriff Blutvergiftung, auch weil die Sepsis mit Bakterien in der Blutbahn assoziiert wird. „Das kann so sein, das muss aber nicht sein“, sagt der Intensivmediziner Michael Bauer. „Die Blutvergiftung ist eine Untergruppe der Sepsis.“
Auch bei Sepsis-Patienten gibt es typische Symptome, die ein Hausarzt, vielleicht sogar ein Angehöriger des Patienten, erkennen könnte: Bewusstseinsstörungen, eine beschleunigte Atmung und der Abfall des Blutdrucks sind die deutlichsten frühzeitigen Symptome – das haben Studien mit mehreren Hunderttausend Patienten in den USA und in Deutschland ergeben. Und natürlich das Gefühl des Patienten, schwer erkrankt zu sein. Auch Schüttelfrost und Rötungen gehörten zu den Symptomen.
Obwohl die Erkrankung so gefährlich ist, können viele Menschen nicht einmal mit dem Namen Sepsis etwas anfangen. Gebräuchlicher ist hierzulande der Begriff Blutvergiftung, auch weil die Sepsis mit Bakterien in der Blutbahn assoziiert wird. „Das kann so sein, das muss aber nicht sein“, sagt der Intensivmediziner Michael Bauer. „Die Blutvergiftung ist eine Untergruppe der Sepsis.“

Das geschieht bei einer Sepsis. Grafik: Johanna Jani / Apotheken Umschau / dpa
Schließen
Infektion steht am Anfang
Infektion steht am Anfang

Weltweit ist die Sepsis die häufigste infektionsbedingte Todesursache. Foto: dpa
Vollbild
Aber wie entsteht eine Sepsis überhaupt? Am Anfang jeder Erkrankung steht eine Infektion. Bei älteren Menschen sind es oftmals Lungenentzündungen, die dann schnell tödliche Folgen haben können, oder Harnwegsinfekte. Aber auch eine Mandelentzündung, ein Kratzer auf der Haut oder ein eitriger Zahn können eine Sepsis in Gang setzen. „Es kann sich aus jeder Infektion eine Sepsis entwickeln“, sagt Bauer. Und natürlich spielen auch Krankenhauskeime dabei eine ungute Rolle, vor allem die multiresistenten. „Wenn ich eine Infektion nicht behandeln kann, weil ich nicht weiß, dass der Keim resistent ist, dann ist die Wahrscheinlichkeit höher, dass diese Infektion septisch verläuft“, so Bauer. Aber letztlich stirbt der Patient nicht, wie von vielen vermutet, an den Bakterien, Pilzen oder sonstigen Eindringlingen. Er wird zum Opfer seiner eigenen Immunabwehr.
„Die Sepsis ist ein Organversagen auf dem Boden einer unangemessenen Antwort des Patienten auf eine Infektion“, sagt Bauer. Das heißt: Wenn der Körper auf eine Infektion so reagiert, dass er dabei das eigene Gewebe und die Organe schädigt, spricht man von einer Sepsis, die in verschiedenen Stadien verläuft. Wenn der Blutdruck massiv abfällt und gleichzeitig mehrere Organe ausfallen, ist dies ein „septischer Schock“.
Weltweit ist die Sepsis die häufigste infektionsbedingte Todesursache, in Deutschland erkranken nach Zahlen der Deutschen Sepsis-Hilfe mehr Menschen daran als an Dickdarmkrebs oder Brustkrebs. Pro Jahr werden 154.000 neue Fälle gezählt, täglich sterben im Schnitt 150 Patienten. Zum Vergleich: An den Folgen einer Aids-Erkrankung sterben hierzulande durchschnittlich zwei Menschen am Tag.
„Die Sepsis ist ein Organversagen auf dem Boden einer unangemessenen Antwort des Patienten auf eine Infektion“, sagt Bauer. Das heißt: Wenn der Körper auf eine Infektion so reagiert, dass er dabei das eigene Gewebe und die Organe schädigt, spricht man von einer Sepsis, die in verschiedenen Stadien verläuft. Wenn der Blutdruck massiv abfällt und gleichzeitig mehrere Organe ausfallen, ist dies ein „septischer Schock“.
Weltweit ist die Sepsis die häufigste infektionsbedingte Todesursache, in Deutschland erkranken nach Zahlen der Deutschen Sepsis-Hilfe mehr Menschen daran als an Dickdarmkrebs oder Brustkrebs. Pro Jahr werden 154.000 neue Fälle gezählt, täglich sterben im Schnitt 150 Patienten. Zum Vergleich: An den Folgen einer Aids-Erkrankung sterben hierzulande durchschnittlich zwei Menschen am Tag.

Weltweit ist die Sepsis die häufigste infektionsbedingte Todesursache. Foto: dpa
Schließen
Ein Drittel der Patienten stirbt
Ein Drittel der Patienten stirbt

Mehr als ein Drittel der Patienten überlebt die Diagnose Sepsis nicht. Foto: dpa
Vollbild
„Wir sehen hier im Jenaer Universitätsklinikum etwa 400 Patienten im Jahr mit einer schweren Sepsis“, sagt Michael Bauer. Etwa zehn Prozent der Intensiv-Patienten seien Sepsis-Patienten. Neben all dem persönlichen Leid und den Problemen in der Behandlung sind sie für die Klinik auch ein finanzieller Faktor. 30 Prozent der gesamten Ausgaben für die Intensivmedizin fließen in Jena in die Behandlung der Sepsis-Kranken – und das ist in anderen Intensivabteilungen nicht anders. Und trotz der Bemühungen um Leib und Seele der Patienten überlebt in Deutschland mehr als ein Drittel die Diagnose Sepsis nicht. Die Sterberate liegt hierzulande vergleichsweise hoch bei 36,4 Prozent, im europäischen Durchschnitt sind es nur 26,5 Prozent.
„Wir versuchen, dem Patienten Zeit zu kaufen“, sagt Michael Bauer zur Therapie der Sepsis-Kranken. „Aber letztlich muss jeder selbst aus der Misere wieder herauskommen.“ Anders als bei einer normalen Infektion, bei der Antibiotika gegen die Erreger eingesetzt werden – und somit die Ursache der Erkrankung bekämpft werden kann – versucht man bei einer schweren Sepsis, die Infektion einzudämmen sowie den Patienten mit Flüssigkeit zu versorgen und den Blutkreislauf zu stabilisieren. Aber ein Medikament, das die gestörte Antwort des Immunsystems auf die Infektion verhindern könnte, ist nicht in Sicht. Hoffnungen setzen Bauer und andere Sepsis-Spezialisten in die Individualisierung der Therapien, die in der Krebsmedizin große Fortschritte gebracht habe.
Tückisch, tödlich, unterschätzt – und sie kann jeden treffen: Es gibt zwar Hinweise, dass Krankheiten wie Diabetes, Leberzirrhose und Immundefekte, die chronisch behandelt werden müssen, überproportional häufig zu Sepsis führen. Aber auch alte Menschen, Frühgeborene und Patienten ohne Milz haben ein höheres Risiko. Die deutsche Sepsis-Hilfe empfiehlt deshalb immungeschwächten Menschen, sich gegen Pneumokokken, die häufigsten Erreger der bakteriellen Lungenentzündung, impfen zu lassen.
„Wir versuchen, dem Patienten Zeit zu kaufen“, sagt Michael Bauer zur Therapie der Sepsis-Kranken. „Aber letztlich muss jeder selbst aus der Misere wieder herauskommen.“ Anders als bei einer normalen Infektion, bei der Antibiotika gegen die Erreger eingesetzt werden – und somit die Ursache der Erkrankung bekämpft werden kann – versucht man bei einer schweren Sepsis, die Infektion einzudämmen sowie den Patienten mit Flüssigkeit zu versorgen und den Blutkreislauf zu stabilisieren. Aber ein Medikament, das die gestörte Antwort des Immunsystems auf die Infektion verhindern könnte, ist nicht in Sicht. Hoffnungen setzen Bauer und andere Sepsis-Spezialisten in die Individualisierung der Therapien, die in der Krebsmedizin große Fortschritte gebracht habe.
Tückisch, tödlich, unterschätzt – und sie kann jeden treffen: Es gibt zwar Hinweise, dass Krankheiten wie Diabetes, Leberzirrhose und Immundefekte, die chronisch behandelt werden müssen, überproportional häufig zu Sepsis führen. Aber auch alte Menschen, Frühgeborene und Patienten ohne Milz haben ein höheres Risiko. Die deutsche Sepsis-Hilfe empfiehlt deshalb immungeschwächten Menschen, sich gegen Pneumokokken, die häufigsten Erreger der bakteriellen Lungenentzündung, impfen zu lassen.

Mehr als ein Drittel der Patienten überlebt die Diagnose Sepsis nicht. Foto: dpa
Schließen
Legionellen
Wenn Wasser krank macht
Leitungswasser ist das in Deutschland am besten untersuchte Lebensmittel überhaupt. Wir trinken es und brauchen keine Erkrankung zu fürchten. Normalerweise. Aber Wasser kann auch krank machen.
Von Barbara Waldvogel
Von Barbara Waldvogel
Zehntausende Erkrankte pro Jahr
Zehntausende Erkrankte pro Jahr

Jährlich erkranken 20.000 bis 32.000 Menschen an einer Lungenentzündung, die durch Legionellen hervorgerufen wird. Foto: Colourbox
Vollbild
Vor allem, wenn wir mit Legionellen verseuchte Aerosole einatmen. Dieses sehr feine Gemisch aus Luft und Wasser bildet sich in Klimaanlagen, Raumbefeuchtern, Kühltürmen, Whirlpools, aber auch in Duschköpfen, die lange nicht benutzt wurden. Und dort nisten sich die heimtückischen Bakterien namens Legionellen mit Vorliebe ein. Die Annehmlichkeiten des modernen Lebens bergen eben auch Gefahren.
So steckten sich im Februar 1999 bei einer Blumenschau in Nordholland mehr als 200 Besucher mit dem Erreger an. 22 der Infizierten starben. Verursacher waren Whirlpools, so das Urteil von Amsterdamer Richtern. Das zur Demonstration auf der Schau genutzte Wasser war demnach nicht gechlort worden. 2009 geriet Ulm in die Schlagzeilen. Der Kühlturm eines neu installierten Blockheizkraftwerkes lief noch im Probebetrieb und wurde immer wieder abgeschaltet, sodass sich im lauwarmen Wasser die Legionellen stark vermehren konnten: Fünf Menschen erlagen der Infektion aus der Luft. 2014 wurde Villa Franca de Xira, ein Vorort von Lissabon, von einer Legionellen-Epidemie heimgesucht, weil ein Industriekühlturm die Erreger verschleuderte. Elf Menschen starben.
Nach Schätzung des Umweltbundesamtes erkranken in Deutschland jedes Jahr 20.000 bis 32.000 Menschen an einer Lungenentzündung, die durch Legionellen hervorgerufen wird. Bis zu 15 Prozent der Fälle enden tödlich. Erstmals identifiziert wurden die Krankheitserreger 1977 – als Ergebnis einer intensiven Forschungsarbeit US-amerikanischer Wissenschaftler. Sie hatten nach einer Erklärung gesucht, warum es 1976 zu massenhaften lebensgefährlichen Lungenentzündungen bei einem Treffen von Legionären in Philadelphia gekommen war. Rund 200 Personen wurden krank, 34 Patienten starben – und die Erreger hatten ihren Namen.
So steckten sich im Februar 1999 bei einer Blumenschau in Nordholland mehr als 200 Besucher mit dem Erreger an. 22 der Infizierten starben. Verursacher waren Whirlpools, so das Urteil von Amsterdamer Richtern. Das zur Demonstration auf der Schau genutzte Wasser war demnach nicht gechlort worden. 2009 geriet Ulm in die Schlagzeilen. Der Kühlturm eines neu installierten Blockheizkraftwerkes lief noch im Probebetrieb und wurde immer wieder abgeschaltet, sodass sich im lauwarmen Wasser die Legionellen stark vermehren konnten: Fünf Menschen erlagen der Infektion aus der Luft. 2014 wurde Villa Franca de Xira, ein Vorort von Lissabon, von einer Legionellen-Epidemie heimgesucht, weil ein Industriekühlturm die Erreger verschleuderte. Elf Menschen starben.
Nach Schätzung des Umweltbundesamtes erkranken in Deutschland jedes Jahr 20.000 bis 32.000 Menschen an einer Lungenentzündung, die durch Legionellen hervorgerufen wird. Bis zu 15 Prozent der Fälle enden tödlich. Erstmals identifiziert wurden die Krankheitserreger 1977 – als Ergebnis einer intensiven Forschungsarbeit US-amerikanischer Wissenschaftler. Sie hatten nach einer Erklärung gesucht, warum es 1976 zu massenhaften lebensgefährlichen Lungenentzündungen bei einem Treffen von Legionären in Philadelphia gekommen war. Rund 200 Personen wurden krank, 34 Patienten starben – und die Erreger hatten ihren Namen.

Jährlich erkranken 20.000 bis 32.000 Menschen an einer Lungenentzündung, die durch Legionellen hervorgerufen wird. Foto: Colourbox
Schließen
Durch Zufall Krankheitserreger
Durch Zufall Krankheitserreger

Carmen Buchrieser. Foto: privat
Vollbild
Für Carmen Buchrieser, österreichische Biologin und Professorin am Pasteur-Institut in Paris, ist diese Massenerkrankung auch ein deutlicher Beleg dafür, wer besonders gefährdet ist: „Das war eine Ansammlung von Risikopersonen in einem Hotel, in dessen Klimaanlage das Bakterium vorkam.“ Ein hohes Risiko, dem Krankheitserreger zum Opfer zu fallen, haben eben ältere und durch eine Krankheit geschwächte Menschen. Auch Raucher sind stärker gefährdet als Nichtraucher.
„Beim Ausbruch der Krankheitswelle in Philadelphia war das Bakterium noch gar nicht bekannt, schon gar nicht als Krankheitserreger. Die Wissenschaftler brauchten ein Jahr, um den Krankheitsverursacher zu identifizieren“, erklärt die Biologin, deren Forschungsschwerpunkt die Pathogenese von Infektionen mit intrazellulären Bakterien ist. Etwas einfacher ausgedrückt: die Entstehung von Infektionen durch Stoffwechselparasiten. Um solche intrazellulären Bakterien handelt es sich auch bei den Legionellen. Das heißt, sie brauchen andere Zellen, damit sie sich vermehren können. Buchrieser: „Alle Versuche, die Bakterien zu kultivieren, scheiterten zunächst, weil sie nicht gewachsen sind.“ Legionellen können im Wasser in einer Art Schlafstadium überleben, bis sie von Einzellern wie Amöben gefressen werden. Dann aber „wachen sie auf“ und beginnen sich zu vermehren. Erst als die Forscher vom Center for Disease Control in Atlanta diese Kulturmethode auch für die Anzucht der Erreger der Legionärskrankheit in Philadelphia anwendeten, konnten sie das Bakterium vermehren und schließlich 1977 Legionella pneumophila isolieren.
Inzwischen sind über 60 verschiedene Legionellen-Spezies bekannt, und vermutlich gibt es noch mehr, die man noch gar nicht entdeckt hat. Aber Legionella pneumophila zusammen mit Legionella longbeachae ist für mehr als 90 Prozent der entsprechenden Erkrankungen verantwortlich. Es sind Umweltkeime, die den Menschen für ihre Existenz nicht brauchen, im Gegensatz zu Mykobakterien, die zum Beispiel Tuberkulose verursachen und von Mensch zu Mensch übertragen werden. Finden sie kein menschliches Opfer, sterben sie. Bislang ist auch nur ein Fall bekannt, wonach Legionellen von Mensch zu Mensch übertragen wurden. „Legionellen sterben ohne uns überhaupt nicht. Legionellen sind durch Zufall Krankheitserreger“, sagt die Wissenschaftlerin.
„Beim Ausbruch der Krankheitswelle in Philadelphia war das Bakterium noch gar nicht bekannt, schon gar nicht als Krankheitserreger. Die Wissenschaftler brauchten ein Jahr, um den Krankheitsverursacher zu identifizieren“, erklärt die Biologin, deren Forschungsschwerpunkt die Pathogenese von Infektionen mit intrazellulären Bakterien ist. Etwas einfacher ausgedrückt: die Entstehung von Infektionen durch Stoffwechselparasiten. Um solche intrazellulären Bakterien handelt es sich auch bei den Legionellen. Das heißt, sie brauchen andere Zellen, damit sie sich vermehren können. Buchrieser: „Alle Versuche, die Bakterien zu kultivieren, scheiterten zunächst, weil sie nicht gewachsen sind.“ Legionellen können im Wasser in einer Art Schlafstadium überleben, bis sie von Einzellern wie Amöben gefressen werden. Dann aber „wachen sie auf“ und beginnen sich zu vermehren. Erst als die Forscher vom Center for Disease Control in Atlanta diese Kulturmethode auch für die Anzucht der Erreger der Legionärskrankheit in Philadelphia anwendeten, konnten sie das Bakterium vermehren und schließlich 1977 Legionella pneumophila isolieren.
Inzwischen sind über 60 verschiedene Legionellen-Spezies bekannt, und vermutlich gibt es noch mehr, die man noch gar nicht entdeckt hat. Aber Legionella pneumophila zusammen mit Legionella longbeachae ist für mehr als 90 Prozent der entsprechenden Erkrankungen verantwortlich. Es sind Umweltkeime, die den Menschen für ihre Existenz nicht brauchen, im Gegensatz zu Mykobakterien, die zum Beispiel Tuberkulose verursachen und von Mensch zu Mensch übertragen werden. Finden sie kein menschliches Opfer, sterben sie. Bislang ist auch nur ein Fall bekannt, wonach Legionellen von Mensch zu Mensch übertragen wurden. „Legionellen sterben ohne uns überhaupt nicht. Legionellen sind durch Zufall Krankheitserreger“, sagt die Wissenschaftlerin.

Carmen Buchrieser. Foto: privat
Schließen
Das Prinzip entschlüsseln
Das Prinzip entschlüsseln

Legionellen sind uralte Bakterien. Foto: Archiv
Vollbild
Sie geht auch davon aus, dass es die Krankheit schon früher gegeben hat, aber eben nicht in diesem Ausmaß. Denn im Grunde sind Legionellen uralte Bakterien. Interessanterweise haben Genom-Analysen der jetzt identifizierten Krankheitserreger gezeigt, dass diese „hoch klonal“ sind, da sie fast keine genetischen Unterschiede zeigen. Das bedeutet, sie entstanden vor relativ kurzer Zeit (20-100 Jahren). „Möglicherweise haben menschliche Veränderungen der Umwelt neue Nischen geschaffen, die es bestimmten Legionellen-Isolaten nun erlauben, sich zu vermehren, auszubreiten und die Krankheit zu verursachen“, erklärt Buchrieser.
Legionellen kommen im Wasser vor, werden aber bei über 60 Grad abgetötet. Keimherde können sich also nur dort bilden, wo Restwasser lange in der Leitung steht. Daher müssen Trinkwasserleitungen in Mehrfamilienhäusern laut Gesetz alle drei Jahre auf einen möglichen Bakterienbefall hin kontrolliert werden, in öffentlichen Einrichtungen wie Kindergärten, Schulen, Kliniken und in Hotels sogar jährlich.
Fazit der Wissenschaftlerin: „Das sind alles Vorsichtsmaßnahmen. Ausrotten kann man Legionellen aber nicht.“ Das Ziel der Forschung ist es deshalb, die Strategie dieser Bakterien zu entschlüsseln. „Wenn wir verstehen, wie es Legionellen schaffen, sich im menschlichen Körper zu vermehren, dann können wir auch Mittel finden, dieses zu verhindern.“ Fest steht, vermehren können sich die Bakterien fast ausschließlich in Wirtszellen, wie der Amöbe. Amöben sind „Fresszellen“, ähnlich den Makrophagen. Diese Zellen gehören zum Immunsystem des Menschen und haben die wichtige Aufgabe, jeden Eindringling aufzufressen und zu zerstören.
Nun haben es aber Legionellen als „intelligente“ Bakterien gelernt, sich nicht von Fresszellen vernichten zu lassen, sondern sich in ihnen einzunisten und zu vermehren. In der Forschungsgruppe von Carmen Buchrieser wurde entdeckt, wie diese Pathogene ihr Ziel erreichen. Legionellen können demnach DNA ihrer Wirtszelle aufnehmen, sie in ihr eigenes Genom einbauen und dann die darauf kodierten Proteine in die Wirtszelle absondern. Dadurch sind sie in der Lage, die Funktionen der Wirtszelle so umzuprogrammieren, dass die Vermehrung der Legionellen möglich ist. Das geschieht auch in den Makrophagenzellen, die dadurch ihre Funktion als „Polizei im Körper“ verlieren. „Wenn wir erforschen können, welche verschiedenen Signalwege Legionellen umpolen, um sich zu vermehren, dann lernen wir im Umkehrschluss auch, welche Signalwege ein Mensch braucht, um eine Krankheit zu bekämpfen“, umreißt Buchrieser das Aufgabengebiet. Was die zeitliche Umsetzung angeht, hält sie sich allerdings zurück.
Legionellen kommen im Wasser vor, werden aber bei über 60 Grad abgetötet. Keimherde können sich also nur dort bilden, wo Restwasser lange in der Leitung steht. Daher müssen Trinkwasserleitungen in Mehrfamilienhäusern laut Gesetz alle drei Jahre auf einen möglichen Bakterienbefall hin kontrolliert werden, in öffentlichen Einrichtungen wie Kindergärten, Schulen, Kliniken und in Hotels sogar jährlich.
Fazit der Wissenschaftlerin: „Das sind alles Vorsichtsmaßnahmen. Ausrotten kann man Legionellen aber nicht.“ Das Ziel der Forschung ist es deshalb, die Strategie dieser Bakterien zu entschlüsseln. „Wenn wir verstehen, wie es Legionellen schaffen, sich im menschlichen Körper zu vermehren, dann können wir auch Mittel finden, dieses zu verhindern.“ Fest steht, vermehren können sich die Bakterien fast ausschließlich in Wirtszellen, wie der Amöbe. Amöben sind „Fresszellen“, ähnlich den Makrophagen. Diese Zellen gehören zum Immunsystem des Menschen und haben die wichtige Aufgabe, jeden Eindringling aufzufressen und zu zerstören.
Nun haben es aber Legionellen als „intelligente“ Bakterien gelernt, sich nicht von Fresszellen vernichten zu lassen, sondern sich in ihnen einzunisten und zu vermehren. In der Forschungsgruppe von Carmen Buchrieser wurde entdeckt, wie diese Pathogene ihr Ziel erreichen. Legionellen können demnach DNA ihrer Wirtszelle aufnehmen, sie in ihr eigenes Genom einbauen und dann die darauf kodierten Proteine in die Wirtszelle absondern. Dadurch sind sie in der Lage, die Funktionen der Wirtszelle so umzuprogrammieren, dass die Vermehrung der Legionellen möglich ist. Das geschieht auch in den Makrophagenzellen, die dadurch ihre Funktion als „Polizei im Körper“ verlieren. „Wenn wir erforschen können, welche verschiedenen Signalwege Legionellen umpolen, um sich zu vermehren, dann lernen wir im Umkehrschluss auch, welche Signalwege ein Mensch braucht, um eine Krankheit zu bekämpfen“, umreißt Buchrieser das Aufgabengebiet. Was die zeitliche Umsetzung angeht, hält sie sich allerdings zurück.

Legionellen sind uralte Bakterien. Foto: Archiv
Schließen
Mikroben und Immunsystem
Mikroben – die fleißigen Untermieter im Darm
Es könnte so einfach sein: Wer ein paar Pfunde zu viel auf der Waage hat, ordert im Internet einen Bakteriencocktail, und schwuppdiwupp schmelzen die Fettringe dahin wie Butter in der Sonne. Genau so anders herum – das soll es ja auch geben. Wer ständig essen muss, um sein Gewicht zu halten, schluckt Dickmach-Bakterien, und schon legt er zu. Darüber, dass es sich in beiden Fälle um Bakterien aus dem Gedärm anderer Menschen handeln würde, muss man eben großzügig hinwegsehen.
Von Claudia Kling
Von Claudia Kling
Jeder Mensch hat sein eigenes Mikrobiom
Jeder Mensch hat sein eigenes Mikrobiom

Caspar Ohnmacht. Foto: Helmholtz Zentrum München
Vollbild
Der Darm – Menschen, die sich intensiv mit ihm beschäftigen, zeigen inzwischen durchweg Hochachtung vor seinem Können. Geradezu emphatisch feierte ihn die junge Biologin Giulia Enders in ihrem Bestseller „Darm mit Charme“. Aber auch Wissenschaftler wie Ohnmacht und Eberl sehen in der Erforschung des meterlangen Schlauchs, der sich durch den Bauch zieht, großes Potenzial. Ihnen geht es in erster Linie darum, das Zusammenspiel zwischen Darmmikroben und dem Immunsystem verstehen zu können. Wenn sie dies durchdrungen haben, könnten ihre Erkenntnisse zu neuen Behandlungsmethoden führen. Die richtige Bakterienmischung geschluckt – und schon würden sich Millionen Heuschnupfengeplagte künftig tiefenentspannt auf den Frühling freuen. Hausstauballergiker könnten sich in Milben baden. Aber all das ist noch sehr weit hergeholt. „Bislang gibt es keine Behandlung in dem Sinne, dass man etwas einfach zuführen könnte, und die Allergie verschwindet dadurch“, erklärt Ohnmacht. Laut Eberl gibt es aber bereits die Möglichkeit, die überaktiven Zellen durch Antikörper zu bremsen oder die allergische Reaktion durch Cortisol zu verringern.
Der Beziehungsstatus zwischen Mensch und Mikrobiom ist durchaus kompliziert. Erst einmal hat jeder Mensch sein eigenes Mikrobiom, das er wie einen genetischen Fingerabdruck mit sich herumträgt. Die Milliarden Untermieter wohnen auf der Haut, im Mund, Genitalbereich – und ganz besonders gern im Darm, weil dort deren Versorgung glänzend ist. Die Bakterien tun aber auch etwas für ihr Dasein: Sie wandeln Essen um, versorgen den Körpereigentümer mit Vitaminen, lebenswichtigen Nährstoffen und nicht zuletzt verhindern sie die Ansiedlung von krankmachenden Keimen. Zweitens ist es ganz wichtig für das gute Zusammenleben von Mensch und Bakterien, dass sich die beiden schon sehr lange kennen. „Während der Evolution des Menschen hat sich eine Menge Feinregulierung mit den Darmbewohnern abgespielt“, sagt Ohnmacht. Gerät dieses Gleichgewicht aus der Balance, beispielsweise durch falsche Ernährung oder die längere Einnahme von Antibiotika, kann das die Ursache für eine ganze Reihe von Erkrankungen sein. Auch genetische Ursachen können dieses Gleichgewicht entscheidend beeinflussen.
Der Beziehungsstatus zwischen Mensch und Mikrobiom ist durchaus kompliziert. Erst einmal hat jeder Mensch sein eigenes Mikrobiom, das er wie einen genetischen Fingerabdruck mit sich herumträgt. Die Milliarden Untermieter wohnen auf der Haut, im Mund, Genitalbereich – und ganz besonders gern im Darm, weil dort deren Versorgung glänzend ist. Die Bakterien tun aber auch etwas für ihr Dasein: Sie wandeln Essen um, versorgen den Körpereigentümer mit Vitaminen, lebenswichtigen Nährstoffen und nicht zuletzt verhindern sie die Ansiedlung von krankmachenden Keimen. Zweitens ist es ganz wichtig für das gute Zusammenleben von Mensch und Bakterien, dass sich die beiden schon sehr lange kennen. „Während der Evolution des Menschen hat sich eine Menge Feinregulierung mit den Darmbewohnern abgespielt“, sagt Ohnmacht. Gerät dieses Gleichgewicht aus der Balance, beispielsweise durch falsche Ernährung oder die längere Einnahme von Antibiotika, kann das die Ursache für eine ganze Reihe von Erkrankungen sein. Auch genetische Ursachen können dieses Gleichgewicht entscheidend beeinflussen.

Caspar Ohnmacht. Foto: Helmholtz Zentrum München
Schließen
Wissenschaft entdeckt den Darm
Wissenschaft entdeckt den Darm

Mikroben bevölkern besonders gern den Darm, weil dort die Versorgung glänzend ist. Foto: Colourbox
Vollbild
Aber so einfach ist es nicht, vielleicht noch nicht, und zwar aus folgenden Gründen: Bislang hat der Darmbakterienaustausch nur im Labor bei dicken und dünnen Mäusen funktioniert, und die Mechanismen, die dabei eine Rolle spielen, sind noch lange nicht hinreichend erforscht. „Zudem kann es sein, dass die Bakterien, die Sie zu sich nehmen, einfach durch ihren Darm hindurchrauschen, weil ihnen die etablierten Mikroben verwehren, sich anzusiedeln“, sagt Dr. Caspar Ohnmacht vom Zentrum Allergie und Umwelt (ZAUM) der Technischen Universität und des Helmholtz Zentrums in München.
Der Immunologe hat wie andere Wissenschaftler in den vergangenen Jahren den Darm für sich entdeckt. Die für ihn bislang wichtigste Erkenntnis: Dass es Bakterien im Darm gibt, die auf bestimmte Zellen wohl so einwirken können, dass unser Immunsystem nicht über das Ziel hinausschießt. Oder etwas wissenschaftlicher formuliert: Die Mikroben im Darm regulieren sogenannte immunsuppressive T-Zellen mit dem Ergebnis, dass eine zu starke Immunantwort auf Fremdstoffe wie Bakterien und Allergene vermieden wird – und es deshalb nicht zu überschießenden Reaktionen wie bei chronisch-entzündlichen Darmerkrankungen oder Allergien kommt. Das ist zwar noch nicht mit letzter Sicherheit bewiesen, aber die Wissenschaftler arbeiten daran.
„Für uns war es überraschend, dass Bakterien an der Entwicklung des Immunsystems beteiligt sind“, sagt der Immunologe Gerard Eberl vom Pasteur-Institut in Paris. „Das Immunsystem bekämpft diese Mikroben nicht, sondern arbeitet mit ihnen.“
Der Immunologe hat wie andere Wissenschaftler in den vergangenen Jahren den Darm für sich entdeckt. Die für ihn bislang wichtigste Erkenntnis: Dass es Bakterien im Darm gibt, die auf bestimmte Zellen wohl so einwirken können, dass unser Immunsystem nicht über das Ziel hinausschießt. Oder etwas wissenschaftlicher formuliert: Die Mikroben im Darm regulieren sogenannte immunsuppressive T-Zellen mit dem Ergebnis, dass eine zu starke Immunantwort auf Fremdstoffe wie Bakterien und Allergene vermieden wird – und es deshalb nicht zu überschießenden Reaktionen wie bei chronisch-entzündlichen Darmerkrankungen oder Allergien kommt. Das ist zwar noch nicht mit letzter Sicherheit bewiesen, aber die Wissenschaftler arbeiten daran.
„Für uns war es überraschend, dass Bakterien an der Entwicklung des Immunsystems beteiligt sind“, sagt der Immunologe Gerard Eberl vom Pasteur-Institut in Paris. „Das Immunsystem bekämpft diese Mikroben nicht, sondern arbeitet mit ihnen.“

Mikroben bevölkern besonders gern den Darm, weil dort die Versorgung glänzend ist. Foto: Colourbox
Schließen
Immunsystem im Großangriff
Immunsystem im Großangriff

Möglicherweise hat der Darm auch bei Allergien einen großen Einfluss. Foto: Archiv
Vollbild
Werden die körpereigenen Bakterien mit fremden Mikroben konfrontiert, die aggressiv und zahlreich genug sind, um alles durcheinanderzuwirbeln, setzt das Immunsystem zum Großangriff an und bekämpft, was da ist. Was dann passiert, weiß jeder, der sich schon mal in exotischen Ländern mit anderen Hygienestandards oder in abgelegenen Berghütten mit kuhdungdurchdrungenem Trinkwasser aufgehalten hat. Ist der Angriff überstanden, kommen die früheren Bakterien danach in aller Regel wieder zurück.
Vor Gesundheit strotzender Naturbursch oder die ewige Triefnase – auch die Antwort auf die Frage, warum an dem einen der schlimmste Grippevirus abperlt, den anderen hingegen jeder Erreger umhaut, suchen Wissenschaftler inzwischen im Darm. Bei den Allergien glauben sie einen Ansatz gefunden zu haben, zumindest deuten zahlreiche epidemiologische Studien, wie zum Beispiel die sogenannte Bauernhofstudie, darauf hin: Es ist wohl tatsächlich so, wie die Großmutter, die selbst Bäuerin war, immer vermutet hat. A bissle Dreck hat noch keinem Kind geschadet – im Gegenteil.
Der Wissenschaftler Ohnmacht formuliert das so: „Wenn man einen relativ ländlichen Lebensstil und Kontakt zu Tieren wie Kühen hat, deren Mikroben dann auch mit ins Haus genommen werden, hat man ein sehr viel geringeres Risiko, eine Allergie zu entwickeln.“ Durch den beständigen Austausch mit anderen Mikroben, in diesem Fall der Tiere, scheint das menschliche Immunsystem toleranter zu reagieren auf Eindringlinge und schießt nicht gleich mit Kanonen – in diesem Fall Typ-2 T-Zellen – mit voller Wucht auf Spatzen – in diesem Fall Bakterien oder Allergene. Andere Zellen, sogenannte Typ-3 regulatorische T-Zellen, die durch den Kontakt mit Mikroben überhaupt erst entstehen, halten sie zurück.
Fleißiger Untermieter, lange verkannter Darm – bleibt die Frage, wie dieses Organ bei Laune gehalten werden kann, damit es weiter für uns sorgt. Fast banal klingt da die Antwort des Forschers Ohnmacht: „Treiben Sie draußen Sport und lassen Sie ihre Kinder draußen spielen – so kommen sie mit Bakterien aus der Umwelt in Kontakt. Ernähren Sie sich gesund. Gemüse, Vollkornprodukte und Milch, die nicht zu Tode erhitzt wurde. Wenn man viel Vollwertkost isst, produzieren die Bakterien einen höheren Anteil kurzkettiger Fettsäuren, das kann ihr Immunsystem stärken.“
Vor Gesundheit strotzender Naturbursch oder die ewige Triefnase – auch die Antwort auf die Frage, warum an dem einen der schlimmste Grippevirus abperlt, den anderen hingegen jeder Erreger umhaut, suchen Wissenschaftler inzwischen im Darm. Bei den Allergien glauben sie einen Ansatz gefunden zu haben, zumindest deuten zahlreiche epidemiologische Studien, wie zum Beispiel die sogenannte Bauernhofstudie, darauf hin: Es ist wohl tatsächlich so, wie die Großmutter, die selbst Bäuerin war, immer vermutet hat. A bissle Dreck hat noch keinem Kind geschadet – im Gegenteil.
Der Wissenschaftler Ohnmacht formuliert das so: „Wenn man einen relativ ländlichen Lebensstil und Kontakt zu Tieren wie Kühen hat, deren Mikroben dann auch mit ins Haus genommen werden, hat man ein sehr viel geringeres Risiko, eine Allergie zu entwickeln.“ Durch den beständigen Austausch mit anderen Mikroben, in diesem Fall der Tiere, scheint das menschliche Immunsystem toleranter zu reagieren auf Eindringlinge und schießt nicht gleich mit Kanonen – in diesem Fall Typ-2 T-Zellen – mit voller Wucht auf Spatzen – in diesem Fall Bakterien oder Allergene. Andere Zellen, sogenannte Typ-3 regulatorische T-Zellen, die durch den Kontakt mit Mikroben überhaupt erst entstehen, halten sie zurück.
Fleißiger Untermieter, lange verkannter Darm – bleibt die Frage, wie dieses Organ bei Laune gehalten werden kann, damit es weiter für uns sorgt. Fast banal klingt da die Antwort des Forschers Ohnmacht: „Treiben Sie draußen Sport und lassen Sie ihre Kinder draußen spielen – so kommen sie mit Bakterien aus der Umwelt in Kontakt. Ernähren Sie sich gesund. Gemüse, Vollkornprodukte und Milch, die nicht zu Tode erhitzt wurde. Wenn man viel Vollwertkost isst, produzieren die Bakterien einen höheren Anteil kurzkettiger Fettsäuren, das kann ihr Immunsystem stärken.“

Möglicherweise hat der Darm auch bei Allergien einen großen Einfluss. Foto: Archiv
Schließen
Krebs durch Infektionen
Impfungen können Krebserkankungen verhindern
Impfen gegen Krebs? Dass Rauchen, Alkohol, ungesunde Ernährung und Bewegungsmangel das Risiko erhöhen, an Krebs zu erkranken, ist nicht neu. Weniger bekannt ist jedoch, dass man durch Vorbeugung und Vermeidung von chronischen Infektionen, die durch bestimmte Viren oder Bakterien ausgelöst werden, sein Krebsrisikosenken kann.
Von Ingrid Augustin
Von Ingrid Augustin
Jede sechste Krebserkrankung durch eine chronische Infektion ausgelöst
Jede sechste Krebserkrankung durch eine chronische Infektion ausgelöst

Nobelpreisträger Harald zur Hausen. Foto: dpa
Vollbild
Nur für einen kurzen Moment blitzte Verärgerung in den Augen von Harald zur Hausen auf, doch sofort hatte sich der Nobelpreisträger wieder im Griff: „Es ist ein Skandal“, antwortete er während der Nobelpreisträgertagung 2014 in Lindau auf die Frage, was er von Impfgegnern halte. Deren Verhalten sei seiner Meinung nach „völlig unverantwortlich“, schließlich lägen genügend Statistiken vor, die die Wirksamkeit von Impfungen im Allgemeinen belegen würden. Der deutsche Wissenschaftler hatte 2008 den Nobelpreis für Medizin erhalten, weil er den Zusammenhang von Viren und Gebärmutterhalskrebs entdeckt hatte und seine Forschung zu der Entwicklung eines Impfstoffes geführt hatte.
Impfen gegen Krebs? Dass Rauchen, Alkohol, ungesunde Ernährung und Bewegungsmangel das Risiko erhöhen, an Krebs zu erkranken, ist nicht neu. Weniger bekannt ist jedoch, dass man durch Vorbeugung und Vermeidung von chronischen Infektionen, die durch bestimmte Viren oder Bakterien ausgelöst werden, sein Krebsrisiko senken kann. Weltweit wurde 2012 jede sechste Krebserkrankung durch eine chronische Infektion ausgelöst, so eine Auswertung der Internationalen Krebsforschungsagentur (IARC). Dabei kann jeder diese Infektionen – beispielsweise durch Impfungen – verhindern oder effektiv behandeln lassen.
Impfen gegen Krebs? Dass Rauchen, Alkohol, ungesunde Ernährung und Bewegungsmangel das Risiko erhöhen, an Krebs zu erkranken, ist nicht neu. Weniger bekannt ist jedoch, dass man durch Vorbeugung und Vermeidung von chronischen Infektionen, die durch bestimmte Viren oder Bakterien ausgelöst werden, sein Krebsrisiko senken kann. Weltweit wurde 2012 jede sechste Krebserkrankung durch eine chronische Infektion ausgelöst, so eine Auswertung der Internationalen Krebsforschungsagentur (IARC). Dabei kann jeder diese Infektionen – beispielsweise durch Impfungen – verhindern oder effektiv behandeln lassen.

Nobelpreisträger Harald zur Hausen. Foto: dpa
Schließen
Zahlreiche Erreger bekannt als Krebsrisiko
Zahlreiche Erreger bekannt als Krebsrisiko

Tumorsuppressoren verhindern Veränderungen im Erbgut. Foto: Archiv
Vollbild
Helicobacter pylori, humane Papillomviren (HPV), humane Hepatitis-B- (HBV) und Hepatitis-C-Viren (HCV) – das sind die vier hauptsächlichen Erreger, die nicht nur chronische Infektionen verursachen können, sondern auch Tumorerkrankungen, wie Magen-, Gebärmutterhalskrebs und Leberzellkarzinome. Daneben werden aber auch noch weitere Erreger mit Krebs in Verbindung gebracht, wie das Epstein-Barr-Virus (Lymphome), das humane Herpesvirus (Kaposi-Sarkom), das humane T-lymphotrope Virus 1 (Leukämien und Lymphome) sowie das Bakterium Chlamydia trachomatis (Unterleibskrebs).
Allein eine Virusinfektion genügt jedoch nicht, um eine Krebserkrankung auszulösen, so das Deutsche Krebsforschungszentrum. Dazu müssten noch andere Faktoren hinzukommen wie eine chronische Entzündung, in deren Folge das Immunsystem die Erreger nicht wirksam bekämpfen kann. Das kann zu genetischen Veränderungen der Wirtszelle und schließlich zur bösartigen Entartung des Gewebes führen. Noch sind nicht alle Mechanismen bekannt, doch zahlreiche Forschungen unter anderem beim Max-Planck-Institut haben ergeben, dass diese Erreger offenbar in der Lage sind, das menschliche Protein p53 zu deaktivieren. Dieser wichtige Tumorsuppressor kann Veränderungen im Erbgut verhindern: Entweder repariert die Zelle daraufhin die beschädigte DNA oder – falls dies nicht möglich sein sollte – startet das zelluläre Selbstmordprogramm. Damit sollen Zellen im Normalfall vor der Entstehung von Krebs geschützt werden.
Allein eine Virusinfektion genügt jedoch nicht, um eine Krebserkrankung auszulösen, so das Deutsche Krebsforschungszentrum. Dazu müssten noch andere Faktoren hinzukommen wie eine chronische Entzündung, in deren Folge das Immunsystem die Erreger nicht wirksam bekämpfen kann. Das kann zu genetischen Veränderungen der Wirtszelle und schließlich zur bösartigen Entartung des Gewebes führen. Noch sind nicht alle Mechanismen bekannt, doch zahlreiche Forschungen unter anderem beim Max-Planck-Institut haben ergeben, dass diese Erreger offenbar in der Lage sind, das menschliche Protein p53 zu deaktivieren. Dieser wichtige Tumorsuppressor kann Veränderungen im Erbgut verhindern: Entweder repariert die Zelle daraufhin die beschädigte DNA oder – falls dies nicht möglich sein sollte – startet das zelluläre Selbstmordprogramm. Damit sollen Zellen im Normalfall vor der Entstehung von Krebs geschützt werden.

Tumorsuppressoren verhindern Veränderungen im Erbgut. Foto: Archiv
Schließen
Hepatitis B zuerst als Risikofaktor erkannt
Hepatitis B zuerst als Risikofaktor erkannt

Studien belegen eine erhebliche Erhöhung des Risikos für Leberzellkarzinome durch Hepatitis-Viren. Foto: dpa
Vollbild
Eine chronische Hepatitis B ist die erste Infektionskrankheit, die als Risikofaktor für eine Krebserkrankung erkannt wurde, so der Bericht zum Krebsgeschehen in Deutschland 2016. Nach ersten Hinweisen 1956 folgten nach der Identifizierung des HB-Virus 1965 zahlreiche Studien, die schließlich eine erhebliche Erhöhung des Risikos für Leberzellkarzinome durch HBV belegten. Hepatitis B wird vorwiegend durch Sexualkontakte oder durch Blut übertragen. Bei Erwachsenen heilt sie meistens aus, kann aber in fünf bis zehn Prozent der Fälle chronisch verlaufen. Dabei könnte die HBV-Impfung, die erste effektive Schutzimpfung, auch Krebserkrankungen verhindern.
Neben Hepatitis-B- gelten auch Hepatitis-C-Viren als Risikofaktoren für die Entwicklung von Leberzellkarzinomen. Die HC-Viren werden durch Blut übertragen und lösen beim Menschen Leberentzündungen aus, die in rund 75 Prozent der Fälle unauffällig verlaufen. Das ist tückisch, da die Infektion ohne eine antivirale Therapie in 50 bis 85 Prozent der Fälle chronisch wird und gegen Hepatitis C kein Impfstoff existiert. Die einzig wirksame Vorbeugung ist bislang, eine Infektion zu vermeiden.
Neben Hepatitis-B- gelten auch Hepatitis-C-Viren als Risikofaktoren für die Entwicklung von Leberzellkarzinomen. Die HC-Viren werden durch Blut übertragen und lösen beim Menschen Leberentzündungen aus, die in rund 75 Prozent der Fälle unauffällig verlaufen. Das ist tückisch, da die Infektion ohne eine antivirale Therapie in 50 bis 85 Prozent der Fälle chronisch wird und gegen Hepatitis C kein Impfstoff existiert. Die einzig wirksame Vorbeugung ist bislang, eine Infektion zu vermeiden.

Studien belegen eine erhebliche Erhöhung des Risikos für Leberzellkarzinome durch Hepatitis-Viren. Foto: dpa
Schließen
Bakterien schädigen DNA des Wirtes
Bakterien schädigen DNA des Wirtes

Das Bakterium Helicobacter pylori. Foto: dpa
Vollbild
1994 wurde das Bakterium Helicobacter pylori (H. pylori) von der IARC als Erreger klassifiziert, der beim Menschen Krebs verursacht. Schätzungen zufolge werden global 5,5 Prozent aller Krebserkrankungen sowie 63,4 Prozent der Magenkrebsfälle durch dieses Bakterium verursacht. Dabei kann man das Bakterium, das chronische Entzündungen der Magenschleimhaut und Magengeschwüre verursacht, schon frühzeitig effektiv bekämpfen: Mithilfe einer antibiotischen Kombinationstherapie kann er vollständig eliminiert werden. Da Schätzungen zufolge weltweit jeder zweite Mensch mit H. pylori infiziert sein soll, könnte eine frühzeitige Erkennung und Behandlung die Zahl der Krebserkrankungen erheblich senken.
Auch das sexuell übertragbare Bakterium Chlamydia trachomatis steht im Verdacht, an der Entstehung von Eierstockkrebs beteiligt zu sein, so das Max-Planck-Institut. Bedenkt man, dass sich jedes Jahr weltweit 90 Millionen Menschen mit diesen Erregern neu anstecken, wird deutlich, wie wichtig auch hier die Behandlung dieser Infektion ist. Zumal sie bei rechtzeitiger Entdeckung und Gabe von Antibiotika vollständig ausheilen kann.
Auch das sexuell übertragbare Bakterium Chlamydia trachomatis steht im Verdacht, an der Entstehung von Eierstockkrebs beteiligt zu sein, so das Max-Planck-Institut. Bedenkt man, dass sich jedes Jahr weltweit 90 Millionen Menschen mit diesen Erregern neu anstecken, wird deutlich, wie wichtig auch hier die Behandlung dieser Infektion ist. Zumal sie bei rechtzeitiger Entdeckung und Gabe von Antibiotika vollständig ausheilen kann.

Das Bakterium Helicobacter pylori. Foto: dpa
Schließen
Auch Jungen sollten gegen HPV geimpft werden
Auch Jungen sollten gegen HPV geimpft werden

Humane Papillomviren (HPV). Foto: dpa
Vollbild
Fast alle Frauen und Männer infizieren sich im Laufe ihres Leben mit mindestens einem Typ der Humanen Papillomviren (HPV).
In den meisten Fällen kann das Immunsystem die Infektion erfolgreich bekämpfen. Doch bei einem kleinen Anteil heilt die Infektion nicht aus, wird chronisch und kann sich im weiteren Verlauf zu Krebs entwickeln. Harald zur Hausen hatte bereits 1976 die Annahme veröffentlicht, dass humane Papillomviren bei der Entstehung von Gebärmutterhalskrebs – der dritthäufigsten Krebserkrankung bei Frauen – eine Rolle spielen.
Mittlerweile gibt es eine Impfung gegen die Hochrisiko-Typen HPV 16 und HPV 18, die bei den meisten Krebserkrankungen eine Rolle spielen. Diese Impfung ist für Mädchen und Jungen ab neun Jahren zugelassen. Doch obwohl so signifikant viele Krebserkrankungen verhindert werden können, hatten laut Robert-Koch-Institut im Jahr 2016 nur 29 Prozent oder 15-jährigen Mädchen in Deutschland den vollen Impfschutz. Harald zur Hausen führt dies darauf zurück, dass Ärzte, Politiker, sowie Lehrer, Eltern und Kinder ungenügend über „die hohe Wirksamkeit und Sicherheit der HPV-Impfung informiert“ seien. Zudem mahnt er, auch Jungen gegen HPV zu impfen. Denn junge Männer hätten in nahezu allen Kulturen mehr Sexualpartner als Frauen der gleichen Altersgruppe und seien damit die wichtigsten Verbreiter der Infektion.
In den meisten Fällen kann das Immunsystem die Infektion erfolgreich bekämpfen. Doch bei einem kleinen Anteil heilt die Infektion nicht aus, wird chronisch und kann sich im weiteren Verlauf zu Krebs entwickeln. Harald zur Hausen hatte bereits 1976 die Annahme veröffentlicht, dass humane Papillomviren bei der Entstehung von Gebärmutterhalskrebs – der dritthäufigsten Krebserkrankung bei Frauen – eine Rolle spielen.
Mittlerweile gibt es eine Impfung gegen die Hochrisiko-Typen HPV 16 und HPV 18, die bei den meisten Krebserkrankungen eine Rolle spielen. Diese Impfung ist für Mädchen und Jungen ab neun Jahren zugelassen. Doch obwohl so signifikant viele Krebserkrankungen verhindert werden können, hatten laut Robert-Koch-Institut im Jahr 2016 nur 29 Prozent oder 15-jährigen Mädchen in Deutschland den vollen Impfschutz. Harald zur Hausen führt dies darauf zurück, dass Ärzte, Politiker, sowie Lehrer, Eltern und Kinder ungenügend über „die hohe Wirksamkeit und Sicherheit der HPV-Impfung informiert“ seien. Zudem mahnt er, auch Jungen gegen HPV zu impfen. Denn junge Männer hätten in nahezu allen Kulturen mehr Sexualpartner als Frauen der gleichen Altersgruppe und seien damit die wichtigsten Verbreiter der Infektion.

Humane Papillomviren (HPV). Foto: dpa
Schließen
Daten, Zahlen und Fakten zum Krebsgeschehen in Deutschland
Daten, Zahlen und Fakten zum Krebsgeschehen in Deutschland
Daten, Zahlen und Fakten zum Krebsgeschehen in Deutschland

Vollbild
Wie viele Menschen sind an Krebs erkrankt, wie viele sind an ihrer Krebserkrankungen gestorben. Unsere Grafik gibt einen Überblick mit den aktuellsten Zahlen von 2013.
Zur interaktiven Grafik
Zur interaktiven Grafik

Schließen
Asiatische Tigermücke: Gefahr im Anflug
Asiatische Tigermücke: Gefahr im Anflug
Experten sind besorgt: Immer mehr exotische Mückenarten siedeln sich in Deutschland an. Denn die Stiche der ungebetenen Gäste sind nicht nur lästig, sondern könnten im schlimmsten Fall gefährliche, tropische Krankheiten übertragen.
Von Christin Hartard
Von Christin Hartard
Gut behandelbar
Gut behandelbar

Auch die „Anopheles gambiae“-Mücken sind Malaria-Überträger. Foto: dpa
Vollbild
Als der Rettungsdienst am Abend in seine Münchner Wohnung kommt, liegt Baris Gelir mit hohem Fieber im Bett. Er friert und schwitzt gleichzeitig, zittert, ist kaum noch ansprechbar. Die Sanitäter schließen auf eine Grippe. Sie empfehlen Gelirs’ Freundin, beim Bereitschaftsarzt Antibiotika zu holen und fahren wieder von dannen. Hätte seine Freundin auf den Rettungsdienst gehört, wäre der 32-Jährige heute tot.
Erst am nächsten Morgen stellt ein Arzt im Klinikum Schwabing die nahe liegende Diagnose: Gelir, der vor wenigen Wochen geschäftlich in Westafrika war, hat Malaria. Zu diesem Zeitpunkt sind bereits 30 Prozent seiner roten Blutkörperchen von den Erregern befallen. „Der Arzt hatte meiner Freundin schon gesagt, sie soll meine Eltern anrufen, falls sie mich noch ein letztes Mal sehen wollen“, erzählt Gelir im Gespräch mit der „Schwäbischen Zeitung“. Doch entgegen der Erwartungen der Ärzte schlagen die Medikamente an, Gelir überlebt.
Schwere Verläufe der Malariaerkrankung wie bei Baris Gelir sind in Deutschland selten. Denn wird Malaria rechtzeitig erkannt, ist sie mit Medikamenten gut behandelbar. 2015 gab es laut Robert-Koch-Institut in Deutschland 1068 Malaria-Fälle, darunter zwei Tote. Alle Infizierten hatten sich – genauso wie Gelir – im Ausland angesteckt, überwiegend in Ländern Afrikas und Asiens. Dort übertragen Mücken die Krankheit. Auch in Deutschland war Malaria bis ins 19. Jahrhundert noch weitverbreitet. „Seit den 1950er-Jahren gilt die Krankheit bei uns allerdings als ausgerottet“, sagt Mückenexperte Helge Kampen vom Friedrich-Loeffler-Institut auf der Insel Riems. Es gebe zwar noch einige einheimische Mückenarten der Gattung Anopheles, die Malaria theoretisch übertragen könnten, doch die einheimischen Erreger existieren nicht mehr. „Die tropischen Erreger hingegen können sich in den einheimischen Anopheles-Arten nicht gut entwickeln“, so Kampen.
Erst am nächsten Morgen stellt ein Arzt im Klinikum Schwabing die nahe liegende Diagnose: Gelir, der vor wenigen Wochen geschäftlich in Westafrika war, hat Malaria. Zu diesem Zeitpunkt sind bereits 30 Prozent seiner roten Blutkörperchen von den Erregern befallen. „Der Arzt hatte meiner Freundin schon gesagt, sie soll meine Eltern anrufen, falls sie mich noch ein letztes Mal sehen wollen“, erzählt Gelir im Gespräch mit der „Schwäbischen Zeitung“. Doch entgegen der Erwartungen der Ärzte schlagen die Medikamente an, Gelir überlebt.
Schwere Verläufe der Malariaerkrankung wie bei Baris Gelir sind in Deutschland selten. Denn wird Malaria rechtzeitig erkannt, ist sie mit Medikamenten gut behandelbar. 2015 gab es laut Robert-Koch-Institut in Deutschland 1068 Malaria-Fälle, darunter zwei Tote. Alle Infizierten hatten sich – genauso wie Gelir – im Ausland angesteckt, überwiegend in Ländern Afrikas und Asiens. Dort übertragen Mücken die Krankheit. Auch in Deutschland war Malaria bis ins 19. Jahrhundert noch weitverbreitet. „Seit den 1950er-Jahren gilt die Krankheit bei uns allerdings als ausgerottet“, sagt Mückenexperte Helge Kampen vom Friedrich-Loeffler-Institut auf der Insel Riems. Es gebe zwar noch einige einheimische Mückenarten der Gattung Anopheles, die Malaria theoretisch übertragen könnten, doch die einheimischen Erreger existieren nicht mehr. „Die tropischen Erreger hingegen können sich in den einheimischen Anopheles-Arten nicht gut entwickeln“, so Kampen.

Auch die „Anopheles gambiae“-Mücken sind Malaria-Überträger. Foto: dpa
Schließen
Bereits eine ausgewachsene Plage
Bereits eine ausgewachsene Plage

Die tropischen Mücken kommen mit dem Gebrauchtreifenhandel nach Europa. Foto: dpa
Vollbild
Viel mehr Sorgen bereiten Experten exotische Mückenarten, die sich in Deutschland ansiedeln. Denn die Stiche der ungebetenen Gäste sind nicht nur lästig, sondern könnten im schlimmsten Fall gefährliche, tropische Krankheiten übertragen. Auf der anderen Seite der Alpen, in Norditalien, ist genau das bereits geschehen. Im Sommer 2007 erkrankten dort fast 200 Menschen an Chikungunya-Fieber, ein Mensch starb sogar an der tropischen Infektionskrankheit.
Mediziner gingen auf Spurensuche und konnten den Verlauf der Epidemie sehr genau rekonstruieren. Ein Mann aus Indien besuchte Verwandte in Italien, wo er plötzlich Fieber bekam. Wie sich später rausfinden ließ, trug der Inder das Chikungunya-Virus in sich, einen in Italien eigentlich fremden Erreger. Eine Asiatische Tigermücke, eine in Italien eigentlich nicht heimische, aber angesiedelte Mücke, stach ihn, nahm das tropische Virus auf und trug es weiter.
„Wegen der günstigen klimatischen Bedingungen ist die Asiatische Tigermücke in Italien bereits zu einer ausgewachsenen Plage geworden“, sagt Jonas Schmidt-Chanasit vom Bernhard-Nocht-Institut für Tropenmedizin in Hamburg. In den vergangenen Jahren ist die Tigermücke auch nach Deutschland vorgedrungen. „Aedes albopictus“ – so der lateinische Name – kann mehr als 20 Viren übertragen, darunter Dengue-, West-Nil- oder eben Chikungunya-Viren. Erst kürzlich konnten Forscher des Bernhard-Nocht-Instituts nachweisen, dass auch in Deutschland angesiedelte Exemplare der Tigermücke in der Lage sind, das in Brasilien grassierende Zika-Virus zu übertragen. Ein weiterer ungebetener Gast: Die Japanische Buschmücke. Die ursprünglich in Japan, Korea und Südchina beheimatete Stechmücke gilt als Überträger des West-Nil-Virus.
Nach Europa gekommen sind die tropischen Mücken mit dem Gebrauchtreifenhandel. „Asien ist auf diesem Gebiet ein großer Exporteur“, sagt Mückenexperte Kampen. Die alten Reifen werden hierzulande vor allem für den Straßenbau verwendet, zum Beispiel um Flüsterbeton herzustellen. Bevor sie verschifft werden, lagern sie allerdings oft wochenlang im Freien, sodass sich bei Regen Wasser in ihnen sammelt. „Die Weibchen legen ihre schwarzen Eier an die feuchte Gummistruktur oberhalb des Wassers“, erklärt der Mückenexperte. So können die kälteresistenten Eier Monate oder sogar Jahre überdauern, bis der Wasserspiegel schließlich steigt, die Eier geflutet werden und die Larven schlüpfen. Genug Zeit also für eine Verschiffung nach Europa. Eine weitere bequeme Reisemöglichkeit für die Tigermücke sind Zierpflanzen aus Asien. Auch dort haben Forscher schon Larven der Asiatischen Tigermücke gefunden.
Mediziner gingen auf Spurensuche und konnten den Verlauf der Epidemie sehr genau rekonstruieren. Ein Mann aus Indien besuchte Verwandte in Italien, wo er plötzlich Fieber bekam. Wie sich später rausfinden ließ, trug der Inder das Chikungunya-Virus in sich, einen in Italien eigentlich fremden Erreger. Eine Asiatische Tigermücke, eine in Italien eigentlich nicht heimische, aber angesiedelte Mücke, stach ihn, nahm das tropische Virus auf und trug es weiter.
„Wegen der günstigen klimatischen Bedingungen ist die Asiatische Tigermücke in Italien bereits zu einer ausgewachsenen Plage geworden“, sagt Jonas Schmidt-Chanasit vom Bernhard-Nocht-Institut für Tropenmedizin in Hamburg. In den vergangenen Jahren ist die Tigermücke auch nach Deutschland vorgedrungen. „Aedes albopictus“ – so der lateinische Name – kann mehr als 20 Viren übertragen, darunter Dengue-, West-Nil- oder eben Chikungunya-Viren. Erst kürzlich konnten Forscher des Bernhard-Nocht-Instituts nachweisen, dass auch in Deutschland angesiedelte Exemplare der Tigermücke in der Lage sind, das in Brasilien grassierende Zika-Virus zu übertragen. Ein weiterer ungebetener Gast: Die Japanische Buschmücke. Die ursprünglich in Japan, Korea und Südchina beheimatete Stechmücke gilt als Überträger des West-Nil-Virus.
Nach Europa gekommen sind die tropischen Mücken mit dem Gebrauchtreifenhandel. „Asien ist auf diesem Gebiet ein großer Exporteur“, sagt Mückenexperte Kampen. Die alten Reifen werden hierzulande vor allem für den Straßenbau verwendet, zum Beispiel um Flüsterbeton herzustellen. Bevor sie verschifft werden, lagern sie allerdings oft wochenlang im Freien, sodass sich bei Regen Wasser in ihnen sammelt. „Die Weibchen legen ihre schwarzen Eier an die feuchte Gummistruktur oberhalb des Wassers“, erklärt der Mückenexperte. So können die kälteresistenten Eier Monate oder sogar Jahre überdauern, bis der Wasserspiegel schließlich steigt, die Eier geflutet werden und die Larven schlüpfen. Genug Zeit also für eine Verschiffung nach Europa. Eine weitere bequeme Reisemöglichkeit für die Tigermücke sind Zierpflanzen aus Asien. Auch dort haben Forscher schon Larven der Asiatischen Tigermücke gefunden.

Die tropischen Mücken kommen mit dem Gebrauchtreifenhandel nach Europa. Foto: dpa
Schließen
Infizierte Reiserückkehrer
Infizierte Reiserückkehrer

Um die Verbreitung der Tigermücke und anderer Mückenarten im Blick zu behalten, wurde der „Mückenatlas“ ins Leben gerufen. Foto: dpa
Vollbild
Mittlerweile ist sie in 29 europäischen Ländern nachgewiesen – auch in Deutschland. Das erste Exemplar fand man 2007 an einem Rastplatz an der A5 in Bad Bellingen im Landkreis Lörrach. Forscher vermuten, dass Reisende aus Italien die Tigermücken mitbringen. „Die Mücken sind sehr aggressiv und folgen dem Mensch bis ins Auto“, so Kampen.
Um die Verbreitung der Tigermücke und anderer Mückenarten im Blick zu behalten, hat Helge Kampen gemeinsam mit Doreen Walther vom Leibniz-Zentrum für Agrarlandschaftsforschung (Zalf) das Projekt „Mückenatlas“ ins Leben gerufen. Egal ob aus dem heimischen Schlafzimmer oder der Regentonne: Allein im vergangenen Jahr schickten Bürger über 40.000 Mücken an die Forscher. „Mittlerweile sind auch zahlreiche Exemplare von invasiven – also nicht heimischen – Stechmücken dabei“, sagt Kampen. In Heidelberg und Freiburg konnten bereits größere Populationen und sogar die Überwinterung der Tigermücke nachgewiesen werden.
„Gefährliche Erreger wurden bisher aber in keiner der Mücken gefunden“, sagt Kampen. Derzeit sei die Gefahr einer Epidemie wie in Italien gering. Doch mit dem zunehmenden Massentourismus in exotische Länder wachse auch die Zahl infizierter Reiserückkehrer, also potenzieller Infektionsquellen. Noch 2013 registrierte das Robert-Koch-Institut nur 16 Fälle von Chikungunya-Fieber in Deutschland, 2015 waren es bereits 110. Mehr als 700 Menschen kamen 2015 mit Dengue-Fieber zurück nach Deutschland. Wird ein infizierter Reiserückkehrer dann hier von einer Tigermücke gestochen, kann sie das Virus aufnehmen und weitergeben. Doch solange nur die Mücken vorhanden sind, aber nicht die Erreger, schreibt das Infektionsschutzgesetz keine Bekämpfung vor.
Allerdings können nicht nur tropische Mücken für den Menschen gefährlich werden. Das afrikanische Usutu-Virus etwa, das 2011 zu einem Massensterben von Amseln und anderen Vögeln führte, kann von heimischen Exemplaren übertragen werden. Bestimmte Unterarten der gemeinen deutschen Hausmücke sind außerdem in der Lage, das West-Nil-Virus zu übertragen. Von einem Menschen, der sich in Deutschland infizierte, ist bisher nichts bekannt.
Um die Verbreitung der Tigermücke und anderer Mückenarten im Blick zu behalten, hat Helge Kampen gemeinsam mit Doreen Walther vom Leibniz-Zentrum für Agrarlandschaftsforschung (Zalf) das Projekt „Mückenatlas“ ins Leben gerufen. Egal ob aus dem heimischen Schlafzimmer oder der Regentonne: Allein im vergangenen Jahr schickten Bürger über 40.000 Mücken an die Forscher. „Mittlerweile sind auch zahlreiche Exemplare von invasiven – also nicht heimischen – Stechmücken dabei“, sagt Kampen. In Heidelberg und Freiburg konnten bereits größere Populationen und sogar die Überwinterung der Tigermücke nachgewiesen werden.
„Gefährliche Erreger wurden bisher aber in keiner der Mücken gefunden“, sagt Kampen. Derzeit sei die Gefahr einer Epidemie wie in Italien gering. Doch mit dem zunehmenden Massentourismus in exotische Länder wachse auch die Zahl infizierter Reiserückkehrer, also potenzieller Infektionsquellen. Noch 2013 registrierte das Robert-Koch-Institut nur 16 Fälle von Chikungunya-Fieber in Deutschland, 2015 waren es bereits 110. Mehr als 700 Menschen kamen 2015 mit Dengue-Fieber zurück nach Deutschland. Wird ein infizierter Reiserückkehrer dann hier von einer Tigermücke gestochen, kann sie das Virus aufnehmen und weitergeben. Doch solange nur die Mücken vorhanden sind, aber nicht die Erreger, schreibt das Infektionsschutzgesetz keine Bekämpfung vor.
Allerdings können nicht nur tropische Mücken für den Menschen gefährlich werden. Das afrikanische Usutu-Virus etwa, das 2011 zu einem Massensterben von Amseln und anderen Vögeln führte, kann von heimischen Exemplaren übertragen werden. Bestimmte Unterarten der gemeinen deutschen Hausmücke sind außerdem in der Lage, das West-Nil-Virus zu übertragen. Von einem Menschen, der sich in Deutschland infizierte, ist bisher nichts bekannt.

Um die Verbreitung der Tigermücke und anderer Mückenarten im Blick zu behalten, wurde der „Mückenatlas“ ins Leben gerufen. Foto: dpa
Schließen
Unerklärliche Fieberschübe
Unerklärliche Fieberschübe

Viele Tropenkrankheiten lassen sich leicht mit harmloseren Krankheiten verwechseln. Foto: Archiv
Vollbild
Fieber, Gliederschmerzen, Erbrechen: Viele Tropenkrankheiten lassen sich leicht mit harmloseren Krankheiten verwechseln. „Wichtig ist, dass behandelnde Ärzte in solchen Fällen immer nach der Reisetätigkeit ihrer Patienten fragen und sie im Zweifel an Spezialisten überweisen“, sagt Schmidt-Chanasit vom Bernhard-Nocht-Institut. Doch was, wenn es keine Auslandsaufenthalte in der Vergangenheit gibt?
Duisburg, Sommer 1997: Ein vierjähriges Kind wird im Krankenhaus wegen einer Nierenbeckenentzündung behandelt. Kaum als geheilt entlassen, kommt es mit hohem Fieber in die Klinik zurück. Der behandelnde Arzt vermutet eine Blutvergiftung. Doch wie sich durch Zufall herausstellt, ist das Kind an Malaria tropica erkrankt, der gefährlichsten Variante der Tropenkrankheit. Und das obwohl das Kind nie in Afrika oder Asien gewesen ist.
Kurze Zeit später treten bei einem weiteren Patienten unerklärliche Fieberschübe auf. Auch hier lautet die Diagnose: Malaria tropica. Einige Zimmer weiter liegt ein Mädchen aus Angola, das die Malariaparasiten im Blut mit nach Deutschland gebracht hat. Weil es heiß ist, schläft das Mädchen bei offenem Fenster. Offenbar hat eine heimische Anopheles-Mücke das Mädchen gestochen und die anderen beiden Patienten infiziert.
„So etwas kommt vor, ist aber die absolute Ausnahme“, sagt Mückenexperte Kampen über die Ereignisse in Duisburg. Im Fall von Baris Gelir hätte die Diagnose eigentlich keine Schwierigkeiten bereiten dürfen. Schließlich wies der Münchner die behandelnden Ärzte sogar mehrmals auf seine vergangene Afrikareise hin, wie er erzählt. Trotzdem wurde keine Malaria-Erkrankung diagnostiziert. Ein fataler Fehler, der Gelir fast das Leben gekostet hätte. Der junge Mann hat nun einen Rechtsanwalt eingeschaltet und verlangt Schmerzensgeld von seinem Arzt. Mittlerweile ist der Münchner wieder fit, die nächste Afrikareise soll allerdings noch bis 2018 warten.
Duisburg, Sommer 1997: Ein vierjähriges Kind wird im Krankenhaus wegen einer Nierenbeckenentzündung behandelt. Kaum als geheilt entlassen, kommt es mit hohem Fieber in die Klinik zurück. Der behandelnde Arzt vermutet eine Blutvergiftung. Doch wie sich durch Zufall herausstellt, ist das Kind an Malaria tropica erkrankt, der gefährlichsten Variante der Tropenkrankheit. Und das obwohl das Kind nie in Afrika oder Asien gewesen ist.
Kurze Zeit später treten bei einem weiteren Patienten unerklärliche Fieberschübe auf. Auch hier lautet die Diagnose: Malaria tropica. Einige Zimmer weiter liegt ein Mädchen aus Angola, das die Malariaparasiten im Blut mit nach Deutschland gebracht hat. Weil es heiß ist, schläft das Mädchen bei offenem Fenster. Offenbar hat eine heimische Anopheles-Mücke das Mädchen gestochen und die anderen beiden Patienten infiziert.
„So etwas kommt vor, ist aber die absolute Ausnahme“, sagt Mückenexperte Kampen über die Ereignisse in Duisburg. Im Fall von Baris Gelir hätte die Diagnose eigentlich keine Schwierigkeiten bereiten dürfen. Schließlich wies der Münchner die behandelnden Ärzte sogar mehrmals auf seine vergangene Afrikareise hin, wie er erzählt. Trotzdem wurde keine Malaria-Erkrankung diagnostiziert. Ein fataler Fehler, der Gelir fast das Leben gekostet hätte. Der junge Mann hat nun einen Rechtsanwalt eingeschaltet und verlangt Schmerzensgeld von seinem Arzt. Mittlerweile ist der Münchner wieder fit, die nächste Afrikareise soll allerdings noch bis 2018 warten.

Viele Tropenkrankheiten lassen sich leicht mit harmloseren Krankheiten verwechseln. Foto: Archiv
Schließen
Tigermücke: Ausbreitung seit 1979
Tigermücke: Ausbreitung seit 1979

Vollbild
Immer mehr Tropenmücken machen sich in Deutschland breit: Experten beobachten die Entwicklung mit großer Sorge.
Zur interaktiven Karte
Zur interaktiven Karte

Schließen
Haus- und Facharztversorgung vor Ort
Haus- und Facharztversorgung vor Ort
Stimmt es, dass es zu wenig Haus- und Fachärzte gibt und deshalb die Wartezeiten für Termine in den Praxen zu lang sind. Wir haben uns einmal vor Ort bei Ärzten und Patienten umgehört.
- Biberach: Warten auf den Facharzttermin
- Bad Waldsee: KV: Hausarztversorgung sehr gut
- Ravensburg: Patienten warten wochenlang auf Facharzttermin
- Wangen: Arztversorgung: „Auf dem Land fehlt es halt“
- Biberach: Warten auf den Facharzttermin
- Bad Waldsee: KV: Hausarztversorgung sehr gut
- Ravensburg: Patienten warten wochenlang auf Facharzttermin
- Wangen: Arztversorgung: „Auf dem Land fehlt es halt“
Autoimmunerkrankungen
Wenn Partner zu Feinden werden
Das Immunsystem dient in der Regel dazu, schädliche Einflüsse von außen abzuwehren. Doch es gibt Menschen, bei denen arbeitet die körpereigene Abwehr zu stark – die Folge sind sogenannte Autoimmunerkrankungen.
Von Daniel Hadrys
Von Daniel Hadrys
Körpereigene Abwehr außer Kontrolle
Körpereigene Abwehr außer Kontrolle

Bei einer Hashimoto thyreoiditis halten die Abwehrzellen die Schilddrüse für einen Fremdling, Foto: Archiv
Vollbild
Das Immunsystem dient in der Regel dazu, schädliche Einflüsse von außen abzuwehren. Doch es gibt Menschen, bei denen arbeitet die körpereigene Abwehr zu stark – die Folge sind sogenannte Autoimmunerkrankungen.
Für gewöhnlich können T-Lymphozyten zwischen Freund und Feind unterscheiden. Sie gehören zur körpereigenen Armee. Dringen Parasiten, Bakterien, Pilze oder Viren in den Körper ein, wissen die kleinsten der weißen Blutkörperchen, was zu tun ist. Sie erkennen Krankheitserreger und mutierte Zellen und machen sie unschädlich.
Wenn die eigene Schilddrüse zum vermeintlichen Gegenspieler wird und die Abwehrzellen sie nach und nach fressen, läuft was schief im Immunsystem. Bei einer Hashimoto thyreoiditis halten sie das Organ für einen Fremdling, der bekämpft werden muss. Auch wenn bei einer multiplen Sklerose die T-Zellen die Hüllen der Nervenzellen so lange schädigen, bis der Mensch bei einem schweren Verlauf auf den Rollstuhl angewiesen ist, ist die körpereigene Abwehr außer Kontrolle.
Für gewöhnlich können T-Lymphozyten zwischen Freund und Feind unterscheiden. Sie gehören zur körpereigenen Armee. Dringen Parasiten, Bakterien, Pilze oder Viren in den Körper ein, wissen die kleinsten der weißen Blutkörperchen, was zu tun ist. Sie erkennen Krankheitserreger und mutierte Zellen und machen sie unschädlich.
Wenn die eigene Schilddrüse zum vermeintlichen Gegenspieler wird und die Abwehrzellen sie nach und nach fressen, läuft was schief im Immunsystem. Bei einer Hashimoto thyreoiditis halten sie das Organ für einen Fremdling, der bekämpft werden muss. Auch wenn bei einer multiplen Sklerose die T-Zellen die Hüllen der Nervenzellen so lange schädigen, bis der Mensch bei einem schweren Verlauf auf den Rollstuhl angewiesen ist, ist die körpereigene Abwehr außer Kontrolle.

Bei einer Hashimoto thyreoiditis halten die Abwehrzellen die Schilddrüse für einen Fremdling, Foto: Archiv
Schließen
Bislang 60 Autoimmunerkrankungen bekannt
Bislang 60 Autoimmunerkrankungen bekannt

Professor Günther Wiedemann. Foto: privat
Vollbild
Beide Krankheiten gehören zu den rund 60 bekannten Autoimmunerkrankungen. Fünf bis acht Prozent der Bevölkerung leiden an einer solchen Fehlleitung des Immunsystems. Sie sind nach Herz-Kreislauf- und Tumorerkrankungen die häufigsten Krankheitsbilder.
Bei einer Autoimmunerkrankung unterscheidet der Körper nicht mehr in „fremd“ und „selbst“ („auto“). Er steht im ständigen Kampf mit eigenen Organen und bestimmten Zellen. Bei einer Colitis ulcerosa oder Morbus Crohn zerstören Immunzellen Bestandteile des Darms, bei einer Diabetes vom Typ 1 Zellen der Bauchspeicheldrüse, bei einer rheumatoiden Arthritis Gelenkhäute zwischen den Knochen.
Der Grund dafür liegt in hyperaktiven Abwehrkräften. „Der Mensch kommt mit einem angeborenen Immunsystem auf die Welt“, erklärt Professor Günther Wiedemann, Chefarzt für Innere Medizin am Krankenhaus St. Elisabeth in Ravensburg. „Im Laufe des Lebens entwickelt sich außerdem das erworbene Immunsystem.“ Der Mensch kommt in Kontakt mit Erregern und Fremdkörpern. Das erworbene Immunsystem lernt zu beurteilen, was schädlich ist und was nicht. „Der Körper unterscheidet auch, was schnell behandelt werden muss und was toleriert werden kann“, sagt Wiedemann. Ein Beispiel dafür seien die nützlichen Keime im Darm, die – in einem gesunden Körper – nicht angegriffen werden.
Bei einer Autoimmunerkrankung unterscheidet der Körper nicht mehr in „fremd“ und „selbst“ („auto“). Er steht im ständigen Kampf mit eigenen Organen und bestimmten Zellen. Bei einer Colitis ulcerosa oder Morbus Crohn zerstören Immunzellen Bestandteile des Darms, bei einer Diabetes vom Typ 1 Zellen der Bauchspeicheldrüse, bei einer rheumatoiden Arthritis Gelenkhäute zwischen den Knochen.
Der Grund dafür liegt in hyperaktiven Abwehrkräften. „Der Mensch kommt mit einem angeborenen Immunsystem auf die Welt“, erklärt Professor Günther Wiedemann, Chefarzt für Innere Medizin am Krankenhaus St. Elisabeth in Ravensburg. „Im Laufe des Lebens entwickelt sich außerdem das erworbene Immunsystem.“ Der Mensch kommt in Kontakt mit Erregern und Fremdkörpern. Das erworbene Immunsystem lernt zu beurteilen, was schädlich ist und was nicht. „Der Körper unterscheidet auch, was schnell behandelt werden muss und was toleriert werden kann“, sagt Wiedemann. Ein Beispiel dafür seien die nützlichen Keime im Darm, die – in einem gesunden Körper – nicht angegriffen werden.

Professor Günther Wiedemann. Foto: privat
Schließen
Vorbeugung ist schwer
Vorbeugung ist schwer

Allergien sind auch eine Form der Autoimmunkrankheit. Foto: Archiv
Vollbild
Dafür sorgt die dritte und wesentliche Funktion des Immunsystems: der Schutz vor überschießender Aktivierung. „Das nennt man Toleranz. Das ist eine echte Fähigkeit“, sagt der Mediziner. „Der Körper lernt, welche Reaktion der Immunabwehr nötig ist und welche zu viel. Eine Funktion des Immunsystems ist der Schutz vor dem eigenen Immunsystem.“ Bei Menschen, die an einer Autoimmunkrankheit leiden, ist diese Toleranz gegenüber bestimmten eigenen Zellen nicht vorhanden.
Vorbeugung ist bei einer Autoimmunkrankheit schwer. „Es gibt jedoch eine Studie, die besagt, dass Kinder, die auf Bauernhöfen aufwachsen, weniger häufig an Allergien leiden“, sagt Wiedemann. „Allergien sind auch eine Form der Autoimmunkrankheit.“ Eigentlich ungefährliche Stoffe können bei Allergikern lebensbedrohliche Zustände auslösen. „Man kann durch Übervorsichtigkeit Kinder schädigen. Dreck ist manchmal gut. Das ist vor allem für unsere ländliche Region interessant.“
Häufig verlaufen Autoimmunkrankheiten in Schüben. Behandelt werden sie dann mit Wirkstoffen wie Cortison, Methotrexat, Cyclophosphamid oder Azathioprin. „Das sind die entscheidenden Medikamente“, erklärt Wiedemann. Diese unterdrücken das Immunsystem. „Das ist aber ein zusätzliches Problem. Dieses Immunsystem verbeißt sich bereitsam eigenen Körper, zusätzlich schwächen diese Medikamente die Funktionen, die das Immunsystem erfüllen sollte: Erreger abwehren.“ Menschen würden anfälliger für Infekte und eine Sepsis. „Das ist nicht banal.“
Vorbeugung ist bei einer Autoimmunkrankheit schwer. „Es gibt jedoch eine Studie, die besagt, dass Kinder, die auf Bauernhöfen aufwachsen, weniger häufig an Allergien leiden“, sagt Wiedemann. „Allergien sind auch eine Form der Autoimmunkrankheit.“ Eigentlich ungefährliche Stoffe können bei Allergikern lebensbedrohliche Zustände auslösen. „Man kann durch Übervorsichtigkeit Kinder schädigen. Dreck ist manchmal gut. Das ist vor allem für unsere ländliche Region interessant.“
Häufig verlaufen Autoimmunkrankheiten in Schüben. Behandelt werden sie dann mit Wirkstoffen wie Cortison, Methotrexat, Cyclophosphamid oder Azathioprin. „Das sind die entscheidenden Medikamente“, erklärt Wiedemann. Diese unterdrücken das Immunsystem. „Das ist aber ein zusätzliches Problem. Dieses Immunsystem verbeißt sich bereitsam eigenen Körper, zusätzlich schwächen diese Medikamente die Funktionen, die das Immunsystem erfüllen sollte: Erreger abwehren.“ Menschen würden anfälliger für Infekte und eine Sepsis. „Das ist nicht banal.“

Allergien sind auch eine Form der Autoimmunkrankheit. Foto: Archiv
Schließen
Das Verständnis fehlt
Das Verständnis fehlt

Einige Menschen, die gegen Schweinegrippe geimpft wurden, litten plötzlich an Narkolepsie. Foto: dpa
Vollbild
Einen anderen, vielversprechenden Ansatz für eine Therapie gebe es bislang nicht, sagt Hans-Jörg Fehling, Mikrobiologe und Professor für Immunologie an der Universität Ulm. „Der Hauptforschungsansatz ist, überhaupt erst einmal zu verstehen, wie es zur Autoimmunität kommt, warum der Körper einige Zellen angreift und andere nicht.“ Erst dann könne man entscheiden, an welchen Stellen man eventuell eingreift. „Kein Wissenschaftler kann jedoch bislang erklären, warum die Toleranz der T-Zellen verloren geht.“
Eine Erklärung ist laut Fehling die Theorie der „Molekularen Mimikry“: Die Eiweißsequenzen einiger Erreger gleichen denen von gesunden Körperzellen. Nach einer überstandenen Infektion glaubt der Körper wegen deren ähnlicher Struktur, weiterhin befallen zu sein. Als Konsequenz greift er die gesunden Zellen an. Ein Beispiel dafür sei die Schweinegrippe. „Einige Menschen, die dagegen geimpft wurden, litten plötzlich an Narkolepsie, also einer Krankheit, bei der die Betroffenen unkontrolliert einschlafen“, erzählt Fehling. Eine Studie habe gezeigt, dass das Virusprotein bestimmten Andockstationen im Gehirn gleicht. Das Immunsystem richte sich gegen die Zellen im Gehirn, die für das Schlafverhalten wichtig sind. Auch nach Infektionen des Darms könne etwas aus dem Gleichgewicht geraten“ und sich eine Autoimmunkrankheit entwickeln, so Fehling.
Dass eine Autoimmunerkrankung allein in den Genen liegt, glaubt der Forscher nicht. Das zeige auch das Beispiel eineiiger Zwillinge, bei denen einer der beiden an einer Typ-1-Diabetes leidet. „Die Wahrscheinlichkeit, dass der gesunde Zwilling auch erkrankt, liegt bei 40 bis 50 Prozent. Es muss noch etwas geben außer der Genetik.“
Eine Erklärung ist laut Fehling die Theorie der „Molekularen Mimikry“: Die Eiweißsequenzen einiger Erreger gleichen denen von gesunden Körperzellen. Nach einer überstandenen Infektion glaubt der Körper wegen deren ähnlicher Struktur, weiterhin befallen zu sein. Als Konsequenz greift er die gesunden Zellen an. Ein Beispiel dafür sei die Schweinegrippe. „Einige Menschen, die dagegen geimpft wurden, litten plötzlich an Narkolepsie, also einer Krankheit, bei der die Betroffenen unkontrolliert einschlafen“, erzählt Fehling. Eine Studie habe gezeigt, dass das Virusprotein bestimmten Andockstationen im Gehirn gleicht. Das Immunsystem richte sich gegen die Zellen im Gehirn, die für das Schlafverhalten wichtig sind. Auch nach Infektionen des Darms könne etwas aus dem Gleichgewicht geraten“ und sich eine Autoimmunkrankheit entwickeln, so Fehling.
Dass eine Autoimmunerkrankung allein in den Genen liegt, glaubt der Forscher nicht. Das zeige auch das Beispiel eineiiger Zwillinge, bei denen einer der beiden an einer Typ-1-Diabetes leidet. „Die Wahrscheinlichkeit, dass der gesunde Zwilling auch erkrankt, liegt bei 40 bis 50 Prozent. Es muss noch etwas geben außer der Genetik.“

Einige Menschen, die gegen Schweinegrippe geimpft wurden, litten plötzlich an Narkolepsie. Foto: dpa
Schließen
Antibiotika-Forschung
Antibiotika-Forschung lohnt sich nicht
Pharmafirmen verdienen mit neuen Medikamenten in diesem Segment kaum noch Geld und haben die Entwicklung größtenteils aufgegeben.
Von Andreas Knoch
Von Andreas Knoch
Kein funktionierendes Geschäftsmodell
Kein funktionierendes Geschäftsmodell

Die Entwicklung neuer Antibiotika lohnt sich wirtschaftlich nicht. Foto: dpa
Vollbild
Sie gelten als das goldene Zeitalter der Antibiotika-Forschung: die 1980er- und 1990er-Jahre des vergangenen Jahrhunderts. Allein in Deutschland sind in diesen beiden Dekaden 42 neue Antibiotika auf den Markt gekommen. Von den weltweit 50 größten Pharmafirmen unterhielten nicht weniger als 18 eine große Antibiotika-Forschungsabteilung.
Doch seitdem herrscht Flaute. Zwischen 2001 und 2010 schafften es lediglich acht Antibiotika-Medikamente auf den Markt, und von den 50 größten Pharmafirmen engagieren sich nur noch sechs in der Antiinfektiva-Forschung.
Die Gründe dafür sind vielfältig, lassen sich aus Sicht von Big Pharma, wie die großen Arzneimittelkonzerne auch genannt werden, aber auf einen einfachen Nenner bringen: Es gibt für Antibiotika aktuell kein funktionierendes Geschäftsmodell. Oder anders ausgedrückt: Die Entwicklung neuer Antibiotika lohnt sich wirtschaftlich nicht.
Das hat viel mit den Besonderheiten von Antibiotika zu tun. Die Medikamente werden entwickelt, um sie nach Möglichkeit nicht oder nur sparsam einzusetzen. Je mehr man von den Wirkstoffen den Patienten verabreicht, desto schneller entwickeln die zu bekämpfenden Keime Resistenzen. Zudem werden Antibiotika nur über einen relativ kurzen Zeitraum beim Patienten eingesetzt. Während die meisten Antibiotika nur über Tage eingenommen werden, werden Cholesterinsenker mitunter ein Leben lang verschrieben. Das macht es für Pharmafirmen per se unattraktiv, in diesem Feld zu investieren. Sie konzentrieren sich lieber auf chronische Krankheiten.
Doch seitdem herrscht Flaute. Zwischen 2001 und 2010 schafften es lediglich acht Antibiotika-Medikamente auf den Markt, und von den 50 größten Pharmafirmen engagieren sich nur noch sechs in der Antiinfektiva-Forschung.
Die Gründe dafür sind vielfältig, lassen sich aus Sicht von Big Pharma, wie die großen Arzneimittelkonzerne auch genannt werden, aber auf einen einfachen Nenner bringen: Es gibt für Antibiotika aktuell kein funktionierendes Geschäftsmodell. Oder anders ausgedrückt: Die Entwicklung neuer Antibiotika lohnt sich wirtschaftlich nicht.
Das hat viel mit den Besonderheiten von Antibiotika zu tun. Die Medikamente werden entwickelt, um sie nach Möglichkeit nicht oder nur sparsam einzusetzen. Je mehr man von den Wirkstoffen den Patienten verabreicht, desto schneller entwickeln die zu bekämpfenden Keime Resistenzen. Zudem werden Antibiotika nur über einen relativ kurzen Zeitraum beim Patienten eingesetzt. Während die meisten Antibiotika nur über Tage eingenommen werden, werden Cholesterinsenker mitunter ein Leben lang verschrieben. Das macht es für Pharmafirmen per se unattraktiv, in diesem Feld zu investieren. Sie konzentrieren sich lieber auf chronische Krankheiten.

Die Entwicklung neuer Antibiotika lohnt sich wirtschaftlich nicht. Foto: dpa
Schließen
Tödlicher Irrtum
Tödlicher Irrtum

Jochen Maas. Foto: dpa
Vollbild
Darüber hinaus sind klinische Studien in der Antibiotika-Forschung sehr aufwendig. „Sie wollen mit der Verabreichung von Antibiotika Lebewesen töten, müssen sie aber Lebewesen – sprich, dem Menschen – verabreichen. Feuer und Dampf sind wunderbare Mittel, um Bakterien den Garaus zu machen, doch damit ist der Patient auch tot“, umreißt Jochen Maas, Leiter Forschung und Entwicklung von Sanofi in Deutschland, die Schwierigkeiten. Bei Notfall-Antibiotika wie Colestin ist die tödliche Dosis für einen Menschen nur wenig höher als die therapeutische Dosis.
Doch der Hauptgrund für die aktuell überschaubaren Forschungsaktivitäten, so Maas, sei die Fehleinschätzung der Wissenschaft gewesen, Infektionskrankheiten im Griff zu haben. Dieser Trugschluss erweist sich als fatal und äußert sich im Vordringen resistenter Keime und der Rückkehr von als bereits besiegt geglaubter Infektionskrankheiten wie Lepra oder Tuberkulose. „Das mit Abstand größte Problem sind resistente Hospitalkeime“, sagt Werner Lanthaler, Chef des Hamburger Biotech-Unternehmens Evotec, das aktuell vier große Antibiotika-Forschungsprojekte verfolgt.
Die Problematik ist inzwischen in der Gesellschaft angekommen – nicht zuletzt wegen warnender Stimmen aus der Wissenschaft. Forscher befürchten, dass sich das Problem resistenter Keime potenzieren und negativ auf die Lebenserwartung der Menschen auswirken könnte. Sanofi-Entwicklungschef Maas fordert deshalb, die Rahmenbedingungen für die Antibiotika-Forschung der neuen Bedrohung anzupassen.
Doch der Hauptgrund für die aktuell überschaubaren Forschungsaktivitäten, so Maas, sei die Fehleinschätzung der Wissenschaft gewesen, Infektionskrankheiten im Griff zu haben. Dieser Trugschluss erweist sich als fatal und äußert sich im Vordringen resistenter Keime und der Rückkehr von als bereits besiegt geglaubter Infektionskrankheiten wie Lepra oder Tuberkulose. „Das mit Abstand größte Problem sind resistente Hospitalkeime“, sagt Werner Lanthaler, Chef des Hamburger Biotech-Unternehmens Evotec, das aktuell vier große Antibiotika-Forschungsprojekte verfolgt.
Die Problematik ist inzwischen in der Gesellschaft angekommen – nicht zuletzt wegen warnender Stimmen aus der Wissenschaft. Forscher befürchten, dass sich das Problem resistenter Keime potenzieren und negativ auf die Lebenserwartung der Menschen auswirken könnte. Sanofi-Entwicklungschef Maas fordert deshalb, die Rahmenbedingungen für die Antibiotika-Forschung der neuen Bedrohung anzupassen.

Jochen Maas. Foto: dpa
Schließen
Neue Anreizsysteme
Neue Anreizsysteme

Sanofi forscht mithilfe von Termiten an neuen Antibiotika. Foto: dpa
Vollbild
„Was wir brauchen sind neue Anreizsysteme. Das können höhere Preise, längere Patentlaufzeiten oder öffentliche Zuschüsse sein“, fordert Maas, dessen Arbeitgeber Sanofi als einer der wenigen Big-Pharma-Vertreter nach wie vor im Bereich Antiinfektiva forscht. Und Morris Hosseini vom Beratungsunternehmen Roland Berger prangert die einseitig auf niedrige Preise fixierte Ausschreibungspraxis der Krankenkassen und Krankenhäuser an.
Dass Sanofi in dem für viele Wettbewerber unattraktiven Forschungsfeld trotzdem engagiert bleibt, begründet Maas damit, unbedingt die Forschungsaktivitäten mit Naturwirkstoffen aufrechterhalten zu wollen. Die Antibiotika-Forschung betreibt der Konzern inzwischen aber nicht mehr allein, sondern zusammen mit dem Fraunhofer Institut. Früher wurden solche Kooperationen kritisch gesehen, heute ziehen beide Seiten an einem Strang. „Wir stellen den Forschern vom Fraunhofer Institut unsere Stammsammlung von 130.000 Organismen zur Verfügung und dürfen im Gegenzug die Ergebnisse aus den Forschungsaktivitäten wirtschaftlich nutzen“, erklärt Maas das Geschäftsmodell.
Darüber hinaus forscht Sanofi mithilfe von Termiten an neuen Antibiotika. Die Insekten haben kein eigenes Immunsystem und wehren sich bei einem Angriff durch Keime und Bakterien, indem sie Antibiotika produzieren.
Auch der Evotec-Chef beobachtet eine Verschiebung der Antibiotika-Forschung von den großen Pharmakonzernen hin zu kleineren Biotech-Firmen und akademischen Forschungskooperationen. „Wirtschaftlich möglich gemacht wird das mithilfe des finanziellen Engagements von Stiftungen und Nichtregierungsorganisationen wie der Bill and Melinda Gates Foundation, die Millionen in die Antibiotika-Forschung investieren“, erklärt Lanthaler und fügt hinzu, dass man bei großen gesellschaftlichen Problemen nicht alles dem Profitstreben unterwerfen dürfe.
Dass Sanofi in dem für viele Wettbewerber unattraktiven Forschungsfeld trotzdem engagiert bleibt, begründet Maas damit, unbedingt die Forschungsaktivitäten mit Naturwirkstoffen aufrechterhalten zu wollen. Die Antibiotika-Forschung betreibt der Konzern inzwischen aber nicht mehr allein, sondern zusammen mit dem Fraunhofer Institut. Früher wurden solche Kooperationen kritisch gesehen, heute ziehen beide Seiten an einem Strang. „Wir stellen den Forschern vom Fraunhofer Institut unsere Stammsammlung von 130.000 Organismen zur Verfügung und dürfen im Gegenzug die Ergebnisse aus den Forschungsaktivitäten wirtschaftlich nutzen“, erklärt Maas das Geschäftsmodell.
Darüber hinaus forscht Sanofi mithilfe von Termiten an neuen Antibiotika. Die Insekten haben kein eigenes Immunsystem und wehren sich bei einem Angriff durch Keime und Bakterien, indem sie Antibiotika produzieren.
Auch der Evotec-Chef beobachtet eine Verschiebung der Antibiotika-Forschung von den großen Pharmakonzernen hin zu kleineren Biotech-Firmen und akademischen Forschungskooperationen. „Wirtschaftlich möglich gemacht wird das mithilfe des finanziellen Engagements von Stiftungen und Nichtregierungsorganisationen wie der Bill and Melinda Gates Foundation, die Millionen in die Antibiotika-Forschung investieren“, erklärt Lanthaler und fügt hinzu, dass man bei großen gesellschaftlichen Problemen nicht alles dem Profitstreben unterwerfen dürfe.

Sanofi forscht mithilfe von Termiten an neuen Antibiotika. Foto: dpa
Schließen
Neue Antibiotika
Pharmazeut:„Bakterien sind sehr erfinderisch“
Infektionen mit bestimmten Bakterien waren damals ein sicheres Todesurteil. Es ist noch nicht einmal 100 Jahre her, als Krankheiten wie Tuberkulose und Wundbrand unheilbar waren. Bis der Mediziner Alexander Fleming 1928 einen Stoff gegen die Erreger entdeckte – das Penicillin. Seitdem haben Forscher immer neue Substanzen gegen verschiedene bakterielle Erreger entdeckt. Lange sah es so aus, als würde der Mensch über einen Großteil krankheitserregender Bakterien siegen. Doch derzeit breiten sich Resistenzen gegen Antibiotika immer weiter aus. Wie und wo neue Wirkstoffe gefunden werden können, erklärt Professor Timo Niedermeyer, Pharmazeut und Wissenschaftler am Deutschen Zentrum für Infektionsforschung.
Von Daniel Hadrys
Von Daniel Hadrys
Droht uns wirklich ein „postantibiotisches Zeitalter“?
Droht uns wirklich ein „postantibiotisches Zeitalter“?

Professor Timo Niedermeyer. Foto: dpa
Vollbild
Herr Niedermeyer, droht uns wirklich ein „postantibiotisches Zeitalter“? Einige Experten sagen voraus, dass bis zum Jahr 2050 jährlich bis zu zehn Millionen Menschen an Infektionen mit resistenten Bakterien sterben – das wären mehr als Krebs- und Verkehrstote zusammen.
Wenn wir nichts tun, auf jeden Fall. Das lässt sich hochrechnen, wenn man sich anschaut, wie schnell Resistenzen sich entwickeln und verbreiten. Daher ist eine große Anstrengung in dem Bereich notwendig – die es aber auch gerade gibt.
Wie viele Antibiotika kennen wir und wie viele sind noch uneingeschränkt wirksam?
In Deutschland werden etwa 80 antibiotische Wirkstoffe gegen verschiedene bakteriell verursachte Krankheiten eingesetzt. Diese Antibiotika kommen aus etwa 15 chemisch unterschiedlichen Wirkstoffklassen, die jeweils verschiedene Wirkmechanismen haben. Es gibt einige „Reserveantibiotika“, die noch gut wirksam sind. Das eigentliche Problem ist aber, dass die gut verträglichen Antibiotika auch am meisten verschrieben werden und sich gegen diese deshalb die meisten Resistenzen ausbreiten. Die Antibiotika, die dann irgendwann nur noch zur Verfügung stehen, sind auch die, die auf den Menschen toxisch wirken.
Wie lernen Bakterien, mit Antibiotika umzugehen?
Die meisten Antibiotika basieren auf natürlichen Substanzen, die beispielsweise von Bakterien gebildet werden. Bei jeder Substanz, die wir in der Natur finden, gibt es auch schon einen Resistenzmechanismus. Es ist nur die Frage, wie schnell sich dieser Mechanismus bei den krankheitserregenden Bakterien durchsetzt. Auch die Evolution hilft den Bakterien – wenn Bakterien von Antibiotika nur geschwächt, aber nicht getötet werden, setzen sich unempfindlichere mit der Zeit durch. Stoffe können von resistenten Bakterien zum Beispiel durch Transporter wieder direkt aus der Zelle befördert werden. Oder die Zielstruktur, an die sich das Antibiotikum heften soll, kann sich verändern. Bakterien können Enzyme bilden, die die Antibiotika abbauen oder so verändern, dass sie nicht mehr wirken können. Bakterien sind unglaublich erfinderisch.
Wenn wir nichts tun, auf jeden Fall. Das lässt sich hochrechnen, wenn man sich anschaut, wie schnell Resistenzen sich entwickeln und verbreiten. Daher ist eine große Anstrengung in dem Bereich notwendig – die es aber auch gerade gibt.
Wie viele Antibiotika kennen wir und wie viele sind noch uneingeschränkt wirksam?
In Deutschland werden etwa 80 antibiotische Wirkstoffe gegen verschiedene bakteriell verursachte Krankheiten eingesetzt. Diese Antibiotika kommen aus etwa 15 chemisch unterschiedlichen Wirkstoffklassen, die jeweils verschiedene Wirkmechanismen haben. Es gibt einige „Reserveantibiotika“, die noch gut wirksam sind. Das eigentliche Problem ist aber, dass die gut verträglichen Antibiotika auch am meisten verschrieben werden und sich gegen diese deshalb die meisten Resistenzen ausbreiten. Die Antibiotika, die dann irgendwann nur noch zur Verfügung stehen, sind auch die, die auf den Menschen toxisch wirken.
Wie lernen Bakterien, mit Antibiotika umzugehen?
Die meisten Antibiotika basieren auf natürlichen Substanzen, die beispielsweise von Bakterien gebildet werden. Bei jeder Substanz, die wir in der Natur finden, gibt es auch schon einen Resistenzmechanismus. Es ist nur die Frage, wie schnell sich dieser Mechanismus bei den krankheitserregenden Bakterien durchsetzt. Auch die Evolution hilft den Bakterien – wenn Bakterien von Antibiotika nur geschwächt, aber nicht getötet werden, setzen sich unempfindlichere mit der Zeit durch. Stoffe können von resistenten Bakterien zum Beispiel durch Transporter wieder direkt aus der Zelle befördert werden. Oder die Zielstruktur, an die sich das Antibiotikum heften soll, kann sich verändern. Bakterien können Enzyme bilden, die die Antibiotika abbauen oder so verändern, dass sie nicht mehr wirken können. Bakterien sind unglaublich erfinderisch.

Professor Timo Niedermeyer. Foto: dpa
Schließen
Riesiges Problem: Antibiotika in der Massentierhaltung
Riesiges Problem: Antibiotika in der Massentierhaltung

Antibiotika werden in der Massentierhaltung breit eingesetzt, um mangelnde Hygienezustände abzudecken. Foto: dpa
Vollbild
Warum werden denn immer mehr Bakterienarten resistent gegen verschiedene Antibiotika?
Dafür gibt es mehrere Gründe. Auf der einen Seite werden Antibiotika zu freigiebig verschrieben. Der Patient kommt mit einem Halskratzen in die Praxis, der Arzt schreibt ein Antibiotikum auf, obwohl es vielleicht gar nicht nötig oder sinnvoll gewesen wäre. Bei Halsentzündungen und Husten beispielsweise, die größtenteils viral bedingt sind, machen Antibiotika keinen Sinn, weil sie nicht gegen Viren wirken. Auch wird zu wenig getestet, welcher Erreger genau für eine Erkrankung verantwortlich ist. Ärzte verschreiben häufig Breitbandantibiotika. Die treffen dann zwar den Krankheitserreger, aber auch alles links und rechts davon.
Welchen Anteil tragen die Patienten an den Resistenzen?
Antibiotika sind fantastische Arzneimittel. Sie wirken sehr schnell, man fühlt sich schnell besser. Das kann dazu führen, dass einige Patienten die Medizin nach drei Tagen absetzen – obwohl sie die vielleicht eine Woche hätten nehmen müssen. Die Erreger, die nicht ganz empfindlich gegen das Antibiotikum waren, sind zwar geschwächt, aber noch nicht vollständig abgetötet und können wieder hochwachsen. So setzen sich die unempfindlicheren Bakterien durch. Es ist sehr wichtig, dass die Patienten die Antibiotika so lange nehmen, wie der Arzt es ihnen sagt oder es in der Packungsbeilage steht.
Verbände warnen vor einem zu exzessiven Verbrauch von Antibiotika in der Massentierhaltung, Landwirtschaftsminister Christian Schmidt (CSU) brachte sogar das Verbot einiger Antibiotika ins Gespräch. Wie groß ist das Problem dort?
Das ist ein riesiges Problem. Antibiotika werden in der Massentierhaltung breit eingesetzt, um mangelnde Hygienezustände abzudecken. Die Antibiotikabgabe führt auch zu einer Wachstumssteigerung.
Wie sieht es mit der Verbreitung multiresistenter Keime in Krankenhäusern aus?
Im Krankenhaus kommen viele kranke Menschen auf engem Raum zusammen, die auch im Zusammenhang mit größeren Operationen häufig eine antibiotische Therapie benötigen. Daher sind dort viele dieser problematischen Keime zu finden. Auch herrschen häufig Zeit- und Kostendruck, da lässt sich eine Verbreitung nicht immer vermeiden.
Dafür gibt es mehrere Gründe. Auf der einen Seite werden Antibiotika zu freigiebig verschrieben. Der Patient kommt mit einem Halskratzen in die Praxis, der Arzt schreibt ein Antibiotikum auf, obwohl es vielleicht gar nicht nötig oder sinnvoll gewesen wäre. Bei Halsentzündungen und Husten beispielsweise, die größtenteils viral bedingt sind, machen Antibiotika keinen Sinn, weil sie nicht gegen Viren wirken. Auch wird zu wenig getestet, welcher Erreger genau für eine Erkrankung verantwortlich ist. Ärzte verschreiben häufig Breitbandantibiotika. Die treffen dann zwar den Krankheitserreger, aber auch alles links und rechts davon.
Welchen Anteil tragen die Patienten an den Resistenzen?
Antibiotika sind fantastische Arzneimittel. Sie wirken sehr schnell, man fühlt sich schnell besser. Das kann dazu führen, dass einige Patienten die Medizin nach drei Tagen absetzen – obwohl sie die vielleicht eine Woche hätten nehmen müssen. Die Erreger, die nicht ganz empfindlich gegen das Antibiotikum waren, sind zwar geschwächt, aber noch nicht vollständig abgetötet und können wieder hochwachsen. So setzen sich die unempfindlicheren Bakterien durch. Es ist sehr wichtig, dass die Patienten die Antibiotika so lange nehmen, wie der Arzt es ihnen sagt oder es in der Packungsbeilage steht.
Verbände warnen vor einem zu exzessiven Verbrauch von Antibiotika in der Massentierhaltung, Landwirtschaftsminister Christian Schmidt (CSU) brachte sogar das Verbot einiger Antibiotika ins Gespräch. Wie groß ist das Problem dort?
Das ist ein riesiges Problem. Antibiotika werden in der Massentierhaltung breit eingesetzt, um mangelnde Hygienezustände abzudecken. Die Antibiotikabgabe führt auch zu einer Wachstumssteigerung.
Wie sieht es mit der Verbreitung multiresistenter Keime in Krankenhäusern aus?
Im Krankenhaus kommen viele kranke Menschen auf engem Raum zusammen, die auch im Zusammenhang mit größeren Operationen häufig eine antibiotische Therapie benötigen. Daher sind dort viele dieser problematischen Keime zu finden. Auch herrschen häufig Zeit- und Kostendruck, da lässt sich eine Verbreitung nicht immer vermeiden.

Antibiotika werden in der Massentierhaltung breit eingesetzt, um mangelnde Hygienezustände abzudecken. Foto: dpa
Schließen
Kennen nur einen Bruchteil der Bakterien auf der Erde
Kennen nur einen Bruchteil der Bakterien auf der Erde

Ein Bakterium produziert einen Cocktail aus vielen Substanzen. Foto: dpa
Vollbild
Wie und wo können Sie denn überhaupt neue Wirkstoffe finden?
Mikroorganismen befinden sich immer in einer Konkurrenzsituation. Die Krankheitsorganismen sind in ihrem natürlichen Umfeld, beispielsweise im Boden, von vielen anderen Mikroorganismen umgeben und müssen sich gegen diese durchsetzen. Dafür bilden sie entsprechende Stoffe. Ich beschäftige mich mit Cyanobakterien, die noch nicht so gut erforscht sind, und in Süß- und Salzwasser, Böden oder auf den Oberflächen von Bäumen oder Gesteinen vorkommen. Andere forschen zum Beispiel mit Myxobakterien, die ebenfalls noch nicht so gut untersucht sind. Es gibt einen Trend, dort nach neuen Stoffen zu suchen, wo man bisher noch nicht gesucht hat. Da ist die Wahrscheinlichkeit, etwas Neues zu finden, einfach größer.
Kriechen Sie als Forscher durch den Regenwald oder tauchen den Meeresgrund ab, um neue Stoffe zu finden?
Das machen wir tatsächlich. Aber Bakterien im Schönbuch können genauso interessant sein wie die im Regenwald. Wir kennen nur einen Bruchteil der Bakterien, die es auf dem Planeten gibt. Von einem Großteil wissen wir nicht einmal, wie wir sie im Labor kultivieren können. Wir müssen überall suchen. Es wäre falsch, nur in artenreichen Regionen in den Tropen zu suchen.
Wie entdecken Sie diese neuen Substanzen?
Zunächst kultivieren wir eine Reihe von Krankheitserregern im Labor und setzen neu isolierte Bakterien auf diese Keime an. Wir achten darauf, ob sie sich gegenseitig beeinflussen oder nicht. Wenn wir Bakterien finden, die diese Krankheitserreger abtöten können, müssen wir herausfinden, wie sie das tun. Ein Bakterium produziert einen Cocktail aus vielen Substanzen. Unsere Aufgabe ist es, den Stoff aus dem Cocktail zu identifizieren, der gegen den Krankheitserreger wirkt. Wir müssen jedoch ausschließen, dass es sich um eine Substanz handelt, die wir schon kennen.
Mikroorganismen befinden sich immer in einer Konkurrenzsituation. Die Krankheitsorganismen sind in ihrem natürlichen Umfeld, beispielsweise im Boden, von vielen anderen Mikroorganismen umgeben und müssen sich gegen diese durchsetzen. Dafür bilden sie entsprechende Stoffe. Ich beschäftige mich mit Cyanobakterien, die noch nicht so gut erforscht sind, und in Süß- und Salzwasser, Böden oder auf den Oberflächen von Bäumen oder Gesteinen vorkommen. Andere forschen zum Beispiel mit Myxobakterien, die ebenfalls noch nicht so gut untersucht sind. Es gibt einen Trend, dort nach neuen Stoffen zu suchen, wo man bisher noch nicht gesucht hat. Da ist die Wahrscheinlichkeit, etwas Neues zu finden, einfach größer.
Kriechen Sie als Forscher durch den Regenwald oder tauchen den Meeresgrund ab, um neue Stoffe zu finden?
Das machen wir tatsächlich. Aber Bakterien im Schönbuch können genauso interessant sein wie die im Regenwald. Wir kennen nur einen Bruchteil der Bakterien, die es auf dem Planeten gibt. Von einem Großteil wissen wir nicht einmal, wie wir sie im Labor kultivieren können. Wir müssen überall suchen. Es wäre falsch, nur in artenreichen Regionen in den Tropen zu suchen.
Wie entdecken Sie diese neuen Substanzen?
Zunächst kultivieren wir eine Reihe von Krankheitserregern im Labor und setzen neu isolierte Bakterien auf diese Keime an. Wir achten darauf, ob sie sich gegenseitig beeinflussen oder nicht. Wenn wir Bakterien finden, die diese Krankheitserreger abtöten können, müssen wir herausfinden, wie sie das tun. Ein Bakterium produziert einen Cocktail aus vielen Substanzen. Unsere Aufgabe ist es, den Stoff aus dem Cocktail zu identifizieren, der gegen den Krankheitserreger wirkt. Wir müssen jedoch ausschließen, dass es sich um eine Substanz handelt, die wir schon kennen.

Ein Bakterium produziert einen Cocktail aus vielen Substanzen. Foto: dpa
Schließen
Der lange Weg zur masernfreien Zone
Der lange Weg zur masernfreien Zone
Der nationale Aktionsplan zielt auf eine Eliminierung der Masern bis 2020. Doch: Baden-Württemberg erreicht Impfquote noch nicht.
Von Barbara Waldvogel
Von Barbara Waldvogel
Keine Entwarnung
Keine Entwarnung

Langsam steigt die Impfquote, die Zahlen für das vergangene Jahr lesen sich auch nicht so dramatisch. Foto: dpa
Vollbild
„Es gibt keinen Wundertrunk gegen gesundheitsgefährdende Übel. Aber es gibt doch etwas Gutes, das medizinisch bewährt ist, einfach und wirkungsvoll: sich impfen lassen.“ Das Statement von Bundesminister a.D. Franz Müntefering in einer Broschüre lässt an Klarheit nichts vermissen. Trotzdem ist in Deutschland nicht jeder von der Notwendigkeit dieser Immunisierung überzeugt, wie die Impfquoten belegen. Geht es aber nach dem Nationalen Aktionsplan, sollten die gefährlichen Masern- und Rötelnviren bis 2020 in Deutschland eliminiert sein.
Um dieses Ziel zu erreichen, brauchen 95 Prozent der Bevölkerung einen ausreichenden Impfschutz: Dass dies noch lange nicht gegeben ist, belegt ein Vorfall in Hofheim bei Frankfurt im März dieses Jahres. Ein Mädchen erkrankte an Masern. Daraufhin wurden vom Gesundheitsamt vorsorglich ein Drittel der Lehrer und 150 Schülerinnen und Schüler vom Unterricht ausgeschlossen, weil sie keinen Impfschutz für Masern nachweisen konnten.
Immerhin: Langsam steigt die Impfquote, die Zahlen für das vergangene Jahr lesen sich auch nicht so dramatisch. In Baden-Württemberg erkrankten nach Angaben des Landesgesundheitsamtes 2016 insgesamt 25 Menschen an Masern, das sind deutlich weniger als 2015 mit 132 Fällen (bundesweit: 2465). Doch Entwarnung kann trotzdem nicht gegeben werden. Im Land wurden in diesem Jahr bereits 40 Masernfälle gemeldet. Oft sind Ballungsräume, wie zuletzt auch Duisburg und Leipzig, von solchen Ausbrüchen betroffen. Dorothea Matysiak-Klose, Masernexpertin im Fachbereich Impfprävention des Robert-Koch-Instituts (RKI), hat dafür auch eine plausible Erklärung: „Es gibt in diesen Städten Gruppen von Menschen, die bisher nicht geimpft wurden und die keine Immunität aufweisen. Je größer diese Gruppierungen sind und je mehr sie miteinander in Kontakt stehen, desto länger sind die Infektionsketten von Mensch zu Mensch und desto mehr Fälle werden beobachtet.“
Um dieses Ziel zu erreichen, brauchen 95 Prozent der Bevölkerung einen ausreichenden Impfschutz: Dass dies noch lange nicht gegeben ist, belegt ein Vorfall in Hofheim bei Frankfurt im März dieses Jahres. Ein Mädchen erkrankte an Masern. Daraufhin wurden vom Gesundheitsamt vorsorglich ein Drittel der Lehrer und 150 Schülerinnen und Schüler vom Unterricht ausgeschlossen, weil sie keinen Impfschutz für Masern nachweisen konnten.
Immerhin: Langsam steigt die Impfquote, die Zahlen für das vergangene Jahr lesen sich auch nicht so dramatisch. In Baden-Württemberg erkrankten nach Angaben des Landesgesundheitsamtes 2016 insgesamt 25 Menschen an Masern, das sind deutlich weniger als 2015 mit 132 Fällen (bundesweit: 2465). Doch Entwarnung kann trotzdem nicht gegeben werden. Im Land wurden in diesem Jahr bereits 40 Masernfälle gemeldet. Oft sind Ballungsräume, wie zuletzt auch Duisburg und Leipzig, von solchen Ausbrüchen betroffen. Dorothea Matysiak-Klose, Masernexpertin im Fachbereich Impfprävention des Robert-Koch-Instituts (RKI), hat dafür auch eine plausible Erklärung: „Es gibt in diesen Städten Gruppen von Menschen, die bisher nicht geimpft wurden und die keine Immunität aufweisen. Je größer diese Gruppierungen sind und je mehr sie miteinander in Kontakt stehen, desto länger sind die Infektionsketten von Mensch zu Mensch und desto mehr Fälle werden beobachtet.“

Langsam steigt die Impfquote, die Zahlen für das vergangene Jahr lesen sich auch nicht so dramatisch. Foto: dpa
Schließen
Furcht vor Impfschäden
Furcht vor Impfschäden

Das Masernvirus. Foto: dpa
Vollbild
Skepsis gegenüber dem Impfen gibt es durchaus, wie Befragungen der Bundeszentrale für gesundheitliche Aufklärung (BZgA) 2014 ergaben. So lehnten damals zwei Prozent das Impfen völlig ab, vier Prozent waren auch eher abgeneigt, und ein Viertel sprach sich nur teilweise für eine Immunisierung aus. Die Gründe der Impfgegner und -skeptiker sind vielfältig. Sie reichen von der Behauptung des Biologen Stefan Lanka, Masernviren gebe es gar nicht, über die längst widerlegte Studie des britischen Arztes Andrew Wakefield von 1998, wonach eine Masern-Mumps-Röteln-Impfung Autismus fördern würde, bishin zum Vorwurf rein geschäftlicher Interessen der Pharmaindustrie.
Auch die Furcht vor Impfschäden spielt eine Rolle. Die gibt es, und das Leid der Betroffenen soll hier nicht geschmälert werden. Allerdings sind die Zahlen gering. In der Zeit von 2005 bis 2009 gab es in der Bundesrepublik insgesamt 169 anerkannte Impfschäden.
Wie kommt es aber, dass sich Mythen und Falschinformationen im Bezug auf das Impfen so hartnäckig halten? Der Virologe, Professor Thomas Mertens, Ärztlicher Direktor am Universitätsklinikum Ulm und Vorsitzender der Ständigen Impfkommission (STIKO), macht zumindest teilweise das Internet dafür verantwortlich. „Die Aussagen, die da verbreitet werden, sind wissenschaftlich ja nicht geprüft. Da gibt es keine eingebaute Qualitätskontrolle“, sagt der Wissenschaftler. Zudem seien es auch die überzeugten Impfgegner, die diese Falschinformationen bewusst streuten und dann auch aufrechterhielten.
Auch die Furcht vor Impfschäden spielt eine Rolle. Die gibt es, und das Leid der Betroffenen soll hier nicht geschmälert werden. Allerdings sind die Zahlen gering. In der Zeit von 2005 bis 2009 gab es in der Bundesrepublik insgesamt 169 anerkannte Impfschäden.
Wie kommt es aber, dass sich Mythen und Falschinformationen im Bezug auf das Impfen so hartnäckig halten? Der Virologe, Professor Thomas Mertens, Ärztlicher Direktor am Universitätsklinikum Ulm und Vorsitzender der Ständigen Impfkommission (STIKO), macht zumindest teilweise das Internet dafür verantwortlich. „Die Aussagen, die da verbreitet werden, sind wissenschaftlich ja nicht geprüft. Da gibt es keine eingebaute Qualitätskontrolle“, sagt der Wissenschaftler. Zudem seien es auch die überzeugten Impfgegner, die diese Falschinformationen bewusst streuten und dann auch aufrechterhielten.

Das Masernvirus. Foto: dpa
Schließen
Deutschland ist Schlusslicht
Deutschland ist Schlusslicht

Die größten Lücken beim Impfschutz bestehen aber bei Jugendlichen und Erwachsenen. Foto: dpa
Vollbild
Bundesweit liegt die Impfrate für die 1. Masernimpfung bei den Schulanfängern bei 97,4 Prozent, für die 2. Masernimpfung bei 92,8 Prozent. Baden-Württemberg nimmt einen unterdurchschnittlichen Rang ein. Bei Schuleingangsuntersuchungen wurde 2016 eine Quote von 95,2 Prozent für die erste Impfung und 89,5 Prozent für die zweite Impfung festgestellt. Das bedeutet: Ziel verfehlt, denn Maßstab für die Erreichung der Masernelimination ist eine Impfquote von 95 Prozent bei beiden Masernimpfungen. Außerdem erfolgen die Impfungen in vielen Fällen zu spät.
„Schlimm, dass Deutschland inzwischen in Europa das Schlusslicht bei der Masernelimination ist“, stellt Lothar H. Wieler, Präsident des Robert Koch-Instituts, aufgrund der neuen Auswertung von Abrechnungsdaten der Kassenärztlichen Vereinigungen (KV) fest. Erstmals haben die RKI-Wissenschaftler die absolute Zahl der Kinder hochgerechnet, die zum empfohlenen Zeitpunkt nicht oder nicht vollständig gegen Masern geimpft sind. Die erste Masernimpfung wird für das Alter von elf bis 14 Monaten empfohlen, die zweite für 15 bis 23 Monate alte Kinder. Im Alter von 24 Monaten waren nach der neuen Auswertung bundesweit 150.000 Kinder des Jahrgangs 2013 nicht vollständig und weitere 28000 Kinder gar nicht gegen Masern geimpft.
Die größten Lücken beim Impfschutz bestehen derzeit aber nicht bei Kindern, sondern bei Jugendlichen und Erwachsenen, wie Sebastian Gülde, Pressereferent im Bundesgesundheitsministerium, auf Anfrage mitteilt. Deshalb soll nach dem 2015 verabschiedeten Gesetz zur Stärkung der Gesundheitsförderung und der Prävention der Impfschutz bei allen Routine-Gesundheitsuntersuchungen für Kinder, Jugendliche und Erwachsene sowie bei den Jugendarbeitsschutzuntersuchungen überprüft werden. Auch Betriebsärzte sollen künftig allgemeine Schutzimpfungen vornehmen können.
„Schlimm, dass Deutschland inzwischen in Europa das Schlusslicht bei der Masernelimination ist“, stellt Lothar H. Wieler, Präsident des Robert Koch-Instituts, aufgrund der neuen Auswertung von Abrechnungsdaten der Kassenärztlichen Vereinigungen (KV) fest. Erstmals haben die RKI-Wissenschaftler die absolute Zahl der Kinder hochgerechnet, die zum empfohlenen Zeitpunkt nicht oder nicht vollständig gegen Masern geimpft sind. Die erste Masernimpfung wird für das Alter von elf bis 14 Monaten empfohlen, die zweite für 15 bis 23 Monate alte Kinder. Im Alter von 24 Monaten waren nach der neuen Auswertung bundesweit 150.000 Kinder des Jahrgangs 2013 nicht vollständig und weitere 28000 Kinder gar nicht gegen Masern geimpft.
Die größten Lücken beim Impfschutz bestehen derzeit aber nicht bei Kindern, sondern bei Jugendlichen und Erwachsenen, wie Sebastian Gülde, Pressereferent im Bundesgesundheitsministerium, auf Anfrage mitteilt. Deshalb soll nach dem 2015 verabschiedeten Gesetz zur Stärkung der Gesundheitsförderung und der Prävention der Impfschutz bei allen Routine-Gesundheitsuntersuchungen für Kinder, Jugendliche und Erwachsene sowie bei den Jugendarbeitsschutzuntersuchungen überprüft werden. Auch Betriebsärzte sollen künftig allgemeine Schutzimpfungen vornehmen können.

Die größten Lücken beim Impfschutz bestehen aber bei Jugendlichen und Erwachsenen. Foto: dpa
Schließen
Impfpflicht wäre kontraproduktiv
Impfpflicht wäre kontraproduktiv

Es gibt ausreichend gute Argumente für eine Impfung. Foto: dpa
Vollbild
Wie wichtig Information in diesem Zusammenhang ist, zeigt auch eine Erhebung der BZgA von 2014: Damals war 74 Prozent der Befragten die Masern-Impfempfehlung der Ständigen Impfkommission völlig unbekannt. Immerhin ist der Anteil der Informierten in zwei Jahren um sieben Prozent gestiegen. Dazu hat vielleicht auch das Internetportal „Mach den Impfcheck“ beigetragen. Die Initiative des Sozialministeriums in Zusammenarbeit mit der AOK und der Kassenärztlichen Vereinigung Baden-Württemberg sowie der Jugendzeitung „YAEZ“ bietet mit flott gemachten Videos und interaktiven Test verständlich verpacktes Wissen rund um die Bedeutung der Immunisierung für die Neun- bis 19-Jährigen. Dabei geht es nicht nur um Masern, sondern auch um andere Infektionskrankheiten.
Wenn Impfquoten nicht erfüllt werden, sollte dann eine Impfpflicht eingeführt werden? Laut Infektionsschutzgesetz (Paragraf 20 Abs. 6 und Abs. 7) ist dies nur möglich, „wenn eine übertragbare Krankheit mit klinisch schwerer Verlaufsform auftritt“. Davon kann ausgegangen werden, wenn eine Krankheit häufig oder immer zu schweren, bleibenden Gesundheitsschäden oder zum Tod führt. Dies trifft bei den meisten Krankheiten, für die es eine Schutzimpfung gibt, jedoch nicht zu, heißt es in einer Mitteilung des Sozialministeriums in Stuttgart. RKI-Pressesprecherin Glasmacher erklärt: „Es gibt ausreichend gute Argumente für eine Impfung. Eine Impfpflicht könnte den unerwünschten Eindruck erwecken, dass die Argumente doch nicht so gut sind. Zudem wäre bei Einführung einer Impfpflicht massiver Widerstand der organisierten Impfgegner und vermutlich auch mancher Eltern zu erwarten, der zum Beispiel die Masernimpfung in der öffentlichen Wahrnehmung eher diskreditieren als stärken würde.“ Auch Virologe Mertens hält nichts von einer Impfpflicht, weil bei jeder medizinischen Maßnahme Nebenwirkungen auftreten können. Auch bei der Impfung. Diese dann gegen den Willen der Eltern durchzuführen, hält er für sehr problematisch.
Wenn Impfquoten nicht erfüllt werden, sollte dann eine Impfpflicht eingeführt werden? Laut Infektionsschutzgesetz (Paragraf 20 Abs. 6 und Abs. 7) ist dies nur möglich, „wenn eine übertragbare Krankheit mit klinisch schwerer Verlaufsform auftritt“. Davon kann ausgegangen werden, wenn eine Krankheit häufig oder immer zu schweren, bleibenden Gesundheitsschäden oder zum Tod führt. Dies trifft bei den meisten Krankheiten, für die es eine Schutzimpfung gibt, jedoch nicht zu, heißt es in einer Mitteilung des Sozialministeriums in Stuttgart. RKI-Pressesprecherin Glasmacher erklärt: „Es gibt ausreichend gute Argumente für eine Impfung. Eine Impfpflicht könnte den unerwünschten Eindruck erwecken, dass die Argumente doch nicht so gut sind. Zudem wäre bei Einführung einer Impfpflicht massiver Widerstand der organisierten Impfgegner und vermutlich auch mancher Eltern zu erwarten, der zum Beispiel die Masernimpfung in der öffentlichen Wahrnehmung eher diskreditieren als stärken würde.“ Auch Virologe Mertens hält nichts von einer Impfpflicht, weil bei jeder medizinischen Maßnahme Nebenwirkungen auftreten können. Auch bei der Impfung. Diese dann gegen den Willen der Eltern durchzuführen, hält er für sehr problematisch.

Es gibt ausreichend gute Argumente für eine Impfung. Foto: dpa
Schließen
Neue Krebstherapien
Brustkrebs ist die häufigste Krebsart bei Frauen
Mehr als 70 000-mal im Jahr stellen Mediziner nach Angaben des Robert-Koch-Instituts die Diagnose „Mammakarzinom“. Brustkrebs ist somit die häufigste Krebserkrankung bei Frauen.
Von Dirk Grupe
Von Dirk Grupe
Überlebenschancen deutlich gestiegen
Überlebenschancen deutlich gestiegen

Sibel Özder. Foto: privat
Vollbild
Dass Meike Schönauer möglicherweise an der Schwelle vom Leben zum Tod steht, ist der 47-Jährigen nicht anzusehen. Um den Kopf hat sie ein graues Tuch mit silbernen Pailletten gewickelt, auf die Stirn fallen sauerstoffblonde Haarsträhnen. Make-up gibt dem schmalen Gesicht einen warmen Teint. Dünn gezogene Augenbrauen und eine Bluse mit Pumpärmeln vermitteln den Eindruck, dass hier jemand ist, der auf sich achtet. Zu diesem Äußeren will allein ihre Aussage nicht passen: „Die Krankheit verändert einen, daran habe ich als Frau sehr zu knabbern.“ Meike Schönauer, die eigentlich anders heißt, hat Brustkrebs. Schon zum zweiten Mal in ihrem Leben. Wimpern, Augenbrauen und Kopfhaare hat sie während der Chemotherapie weitestgehend verloren, mit Schminke und Kunsthaar trotzt sie dem Angriff auf ihre Weiblichkeit. Und sie tröstet sich: „Es kommt ja alles wieder zurück.“ Wenn der Plan in Erfüllung geht: Gesund werden und gesund bleiben. Die Aussichten dafür stehen nicht mal schlecht.
„Die Überlebenschancen bei Brustkrebs sind in den vergangenen Jahren deutlich gestiegen“, sagt Sibel Özder, die das Brustzentrum Villingen-Schwenningen/Tuttlingen leitet, in dem auch Meike Schönauer behandelt wird. „Die meisten Patienten“, so Özder weiter, „die noch nicht metastasiert sind, können wir heilen.“ (Metastase ist die Absiedelung eines bösartigen Tumors in entferntem Gewebe, die Red.)
Und das bei einer Krebsart, bei der sich die Zahl der Fälle seit den 1980er-Jahren verdoppelt hat. Mehr als 70 000-mal im Jahr stellen Mediziner nach Angaben des Robert-Koch-Instituts die Diagnose „Mammakarzinom“. Brustkrebs ist somit die häufigste Krebserkrankung bei Frauen.
Und das bei einer Krebsart, bei de
„Die Überlebenschancen bei Brustkrebs sind in den vergangenen Jahren deutlich gestiegen“, sagt Sibel Özder, die das Brustzentrum Villingen-Schwenningen/Tuttlingen leitet, in dem auch Meike Schönauer behandelt wird. „Die meisten Patienten“, so Özder weiter, „die noch nicht metastasiert sind, können wir heilen.“ (Metastase ist die Absiedelung eines bösartigen Tumors in entferntem Gewebe, die Red.)
Und das bei einer Krebsart, bei der sich die Zahl der Fälle seit den 1980er-Jahren verdoppelt hat. Mehr als 70 000-mal im Jahr stellen Mediziner nach Angaben des Robert-Koch-Instituts die Diagnose „Mammakarzinom“. Brustkrebs ist somit die häufigste Krebserkrankung bei Frauen.
Und das bei einer Krebsart, bei de

Sibel Özder. Foto: privat
Schließen
Interdiziplinäre Planung
Interdiziplinäre Planung

Der Therapieplan kann kann sehr unterschiedlich ausfallen, in der Medikation, in der Chemotherapie oder in der Antikörpertherapie. Foto: dpa
Vollbild
In der Regel verläuft die Krankheit so: Nach einer Früherkennung wird eine Gewebeprobe entnommen und die Krebszelle genau untersucht; nach Oberflächenbeschaffenheit, Hormonrezeptoren, Aggressivität des Tumors. Anschließend legen Strahlentherapeuten, Radiologen, Gynäkologen, Hämatologen und Pathologen gemeinsam einen Therapieplan fest. Sibel Özder sagt aber: „Heute muss man nicht Angst vor Brustkrebs haben, sondern davor, dass er zu spät erkannt wird.“
Dieser kann sehr unterschiedlich ausfallen, in der Medikation, in der Chemotherapie oder in der Antikörpertherapie, die als sehr wirksam gilt, die sich aber nur für 15 Prozent der Patientinnen eignet. Alles in allem lautet die Zauberformel: individuelle Behandlung, ermöglicht durch eine Vielzahl an unterschiedlichen Medikamenten, die fortlaufend in Verträglichkeit und vor allem spezifischer Wirksamkeit verbessert werden.
Darunter Medikamente, die sogar bei Sterbenskranken, also da, wo der Krebs bereits gestreut hat, zwar nicht heilend, aber tief in die Krebszelle dringend erstaunlich lebensverlängernd wirken. „Wir hatten schon chronische Krankheitsverläufe von zehn Jahren und mehr bei hoher Lebensqualität“, betont Sibel Özder.
Darüber hinaus rät die Ärztin Erkrankten, ganz egal in welchem Stadium, zu aktiver Lebensweise gepaart mit gesunder Ernährung: „Die Studien sind hier eindeutig: Sport und bewusste Ernährung erhöhen die Heilungschancen und beugen auch vor.“
Dieser kann sehr unterschiedlich ausfallen, in der Medikation, in der Chemotherapie oder in der Antikörpertherapie, die als sehr wirksam gilt, die sich aber nur für 15 Prozent der Patientinnen eignet. Alles in allem lautet die Zauberformel: individuelle Behandlung, ermöglicht durch eine Vielzahl an unterschiedlichen Medikamenten, die fortlaufend in Verträglichkeit und vor allem spezifischer Wirksamkeit verbessert werden.
Darunter Medikamente, die sogar bei Sterbenskranken, also da, wo der Krebs bereits gestreut hat, zwar nicht heilend, aber tief in die Krebszelle dringend erstaunlich lebensverlängernd wirken. „Wir hatten schon chronische Krankheitsverläufe von zehn Jahren und mehr bei hoher Lebensqualität“, betont Sibel Özder.
Darüber hinaus rät die Ärztin Erkrankten, ganz egal in welchem Stadium, zu aktiver Lebensweise gepaart mit gesunder Ernährung: „Die Studien sind hier eindeutig: Sport und bewusste Ernährung erhöhen die Heilungschancen und beugen auch vor.“

Der Therapieplan kann kann sehr unterschiedlich ausfallen, in der Medikation, in der Chemotherapie oder in der Antikörpertherapie. Foto: dpa
Schließen
Mit dem Alter steigt das Risiko
Mit dem Alter steigt das Risiko

Beim Mammografie-Screening werden inzwischen auch kleinste Brustkrebszellen sowie Vorstufen erkannt. Foto: imago
Vollbild
Woran das liege, könne die Wissenschaft noch nicht sagen, bedauert Oberärztin Sibel Özder. Die Statistik werde allerdings durch verbesserte Diagnoseverfahren beeinflusst, da bei einem „Mammografie-Screening inzwischen auch kleinste Brustkrebszellen sowie Vorstufen“ erkannt werden. Auch die höhere Lebenserwartung bei Frauen schlägt sich in den Zahlen nieder, da das Erkrankungsrisiko mit dem Alter steigt. Brustkrebs ist zwar die häufigste Krebsart bei Frauen – aber nicht die gefährlichste. Denn mit der steigenden Zahl der Neuerkrankungen sinkt gleichzeitig jene der Sterbefälle. Rund 80 Prozent aller erkrankten Frauen leben auch zehn Jahre nach der Diagnose noch.
Diese Zahlen und die eigene Erfahrung machen Meike Schönauer Mut. Sie erlebt den Alptraum einer jeden Frau zum zweiten Mal. Vor zwölf Jahren war es, als sie morgens unter der Dusche einen Knoten ertastete. Schon damals ließ sie sich am Klinikum Tuttlingen untersuchen, schon damals lautete die Diagnose: bösartig.
„Wir hatten gerade die Hochzeit geplant“, erinnert sich Schönauer an die Zeit. Dann der Schock, Brustkrebs, mit 35. „Plötzlich war nichts mehr wie vorher.“ Es folgte eine Chemotherapie, verbunden mit Übelkeit bis zum Erbrechen, später die Entfernung des Tumors. Langsam fand sie zurück ins Leben, langsam schwand die Angst vor einem erneuten Ausbruch der Krankheit. Nach einer Weile konnte sie wieder zu 100 Prozent in ihren Marketingjob einsteigen, „das war mir wichtig, das gab mir Kraft, leistungsfähig zu sein“. Bis vor einigen Wochen, als sie wieder unter der Dusche und an derselben Brust dann eine Verhärtung spürte.
Der Schock sei diesmal nicht ganz so groß gewesen, „vielleicht, weil ich es schon einmal durchlaufen habe“. Und weil sich in den vergangenen zwölf Jahren die Behandlungsmethoden nochmals deutlich verbessert haben.
„Ganz früher hieß es, Chemotherapie, Brust ab“, sagt Sibel Özder. Diese Zeiten seien lange vorbei, aber nicht nur das: „Wir wissen heute sehr viel über Brustkrebszellen. Und wir wissen, dass sie sich sehr unterschiedlich verhalten. Brustkrebs ist nicht gleich Brustkrebs.“ Für die Patientinnen bedeutet das: „Wir wollen ihnen eine maßgeschneiderte Therapie anbieten.“
Diese Zahlen und die eigene Erfahrung machen Meike Schönauer Mut. Sie erlebt den Alptraum einer jeden Frau zum zweiten Mal. Vor zwölf Jahren war es, als sie morgens unter der Dusche einen Knoten ertastete. Schon damals ließ sie sich am Klinikum Tuttlingen untersuchen, schon damals lautete die Diagnose: bösartig.
„Wir hatten gerade die Hochzeit geplant“, erinnert sich Schönauer an die Zeit. Dann der Schock, Brustkrebs, mit 35. „Plötzlich war nichts mehr wie vorher.“ Es folgte eine Chemotherapie, verbunden mit Übelkeit bis zum Erbrechen, später die Entfernung des Tumors. Langsam fand sie zurück ins Leben, langsam schwand die Angst vor einem erneuten Ausbruch der Krankheit. Nach einer Weile konnte sie wieder zu 100 Prozent in ihren Marketingjob einsteigen, „das war mir wichtig, das gab mir Kraft, leistungsfähig zu sein“. Bis vor einigen Wochen, als sie wieder unter der Dusche und an derselben Brust dann eine Verhärtung spürte.
Der Schock sei diesmal nicht ganz so groß gewesen, „vielleicht, weil ich es schon einmal durchlaufen habe“. Und weil sich in den vergangenen zwölf Jahren die Behandlungsmethoden nochmals deutlich verbessert haben.
„Ganz früher hieß es, Chemotherapie, Brust ab“, sagt Sibel Özder. Diese Zeiten seien lange vorbei, aber nicht nur das: „Wir wissen heute sehr viel über Brustkrebszellen. Und wir wissen, dass sie sich sehr unterschiedlich verhalten. Brustkrebs ist nicht gleich Brustkrebs.“ Für die Patientinnen bedeutet das: „Wir wollen ihnen eine maßgeschneiderte Therapie anbieten.“

Beim Mammografie-Screening werden inzwischen auch kleinste Brustkrebszellen sowie Vorstufen erkannt. Foto: imago
Schließen
Zehn Prozent genetisch bedingt
Zehn Prozent genetisch bedingt

Angelina Jolie. Foto: AFP
Vollbild
Eine Brustentfernung dagegen ist heute die allerletzte Möglichkeit, sie wird nur bei einem besonders großen Tumor vorgenommen, der sich über weite Teile der Brust erstreckt. In seltenen Fällen erfolgt der Eingriff als Vorsichtsmaßnahme, wie bei der Hollywood-Schauspielerin Angelina Jolie, bei der eine genetische Veranlagung vorliegt. Dabei geht es um das sogenannte BRCA1- oder das BRCA2-Gen.
„Nur jeder zehnte Brustkrebs ist genetisch bedingt, dann ist das Risiko einer Erkrankung aber sehr hoch“, sagt Wolfgang Janni, Leiter der Frauenklinik Ulm, die Mitglied ist im BRCA-Netzwerk. Die Brust wird auch nicht mehr amputiert, sondern die Brustdrüsen werden entnommen, Haut und Brustwarze bleiben erhalten. Manche der betroffenen Frauen verzichten auf diesen Schritt und intensivieren die Vorsorge mit einer Kombination aus Mammografie und Kernspintomografie. Ab dem 40. Lebensjahr, nach abgeschlossener Familienplanung, raten Ärzte allerdings zu einer Entfernung der Eierstöcke, was laut Janni wiederum das Brustkrebsrisiko vermindere.
Der Körper ist die eine Sache. Der Geist , die Gefühle eine andere, wenn man mit der Furcht vor dem Tod leben muss. Mit der physischen Behandlung geht daher eine psychische einher, die schon mit der Diagnose beginnt. „Mut machen ist wichtig“, sagt Sibel Özder. „Wenn die Patientin eine Perspektive hat, ist das genauso wirksam wie die Chemotherapie.“
Meike Schönauer hat diese Perspektive, dafür ist sie dankbar: „Ich habe schon Frauen getroffen, die wie ich in jungen Jahren Brustkrebs bekamen und nicht überlebt haben.“ Das soll ihr nicht passieren. Damals, mit 35, hat sie nur zehn Tage nach der Operation geheiratet. Ihr Mann und ihre Freunde stehen auch heute hinter ihr, geben ihr Kraft, damit der Plan in Erfüllung geht: Gesund werden und gesund bleiben.
„Nur jeder zehnte Brustkrebs ist genetisch bedingt, dann ist das Risiko einer Erkrankung aber sehr hoch“, sagt Wolfgang Janni, Leiter der Frauenklinik Ulm, die Mitglied ist im BRCA-Netzwerk. Die Brust wird auch nicht mehr amputiert, sondern die Brustdrüsen werden entnommen, Haut und Brustwarze bleiben erhalten. Manche der betroffenen Frauen verzichten auf diesen Schritt und intensivieren die Vorsorge mit einer Kombination aus Mammografie und Kernspintomografie. Ab dem 40. Lebensjahr, nach abgeschlossener Familienplanung, raten Ärzte allerdings zu einer Entfernung der Eierstöcke, was laut Janni wiederum das Brustkrebsrisiko vermindere.
Der Körper ist die eine Sache. Der Geist , die Gefühle eine andere, wenn man mit der Furcht vor dem Tod leben muss. Mit der physischen Behandlung geht daher eine psychische einher, die schon mit der Diagnose beginnt. „Mut machen ist wichtig“, sagt Sibel Özder. „Wenn die Patientin eine Perspektive hat, ist das genauso wirksam wie die Chemotherapie.“
Meike Schönauer hat diese Perspektive, dafür ist sie dankbar: „Ich habe schon Frauen getroffen, die wie ich in jungen Jahren Brustkrebs bekamen und nicht überlebt haben.“ Das soll ihr nicht passieren. Damals, mit 35, hat sie nur zehn Tage nach der Operation geheiratet. Ihr Mann und ihre Freunde stehen auch heute hinter ihr, geben ihr Kraft, damit der Plan in Erfüllung geht: Gesund werden und gesund bleiben.

Angelina Jolie. Foto: AFP
Schließen
Gesundheit als Markt
Von der Idee zur App auf Rezept
Therapiehilfen per Smartphone werden stark nachgefragt. Doch um damit Geld zu verdienen, ist es ein langer Weg.
Von Tanja Tricarico und Mark Hänsgen
Von Tanja Tricarico und Mark Hänsgen
Gesetzliche Regularien
Gesetzliche Regularien

Mit der App „Tinnitracks“ können Patienten ihre Lieblingsmusik so filtern, dass sie zur Tinnitus-Therapie eingesetzt werden kann. Foto: privat
Vollbild
Es pfeift im Ohr, es zischt, rauscht. Das Geräusch ist immer da, im Job, beim Familienausflug, beim Abendessen mit Freunden. Stress schlägt sich bei vielen Menschen aufs Ohr. Den Tinnitus wieder loszuwerden ist schwierig, in manchen Fällen aussichtslos. Digitale Hilfe könnte das Leid der Betroffenen lindern. Jörg Land und seine Kollegen haben vor knapp vier Jahren die App „Tinnitracks“ auf den Markt gebracht. Mit der Software können Patienten ihre Lieblingsmusik so filtern, dass sie zur Tinnitus-Therapie eingesetzt werden kann. Experten fanden die Idee von Anfang an gut. Aber bis zum Angebot auf dem Gesundheitsmarkt war es ein langer und anstrengender Weg.
Um Geschäfte mit der Gesundheit zu machen, müssen Unternehmen etliche gesetzliche Regularien einhalten. „Ein Medizinprodukt ist Fleißarbeit“, sagt Land, Geschäftsführer von Sonormed, der Firma, die hinter der Tinnitus-App steht. Es geht um Auflagen zum Schutz der Patienten, darum, ob das neue Produkt den Betroffenen tatsächlich hilft. Darum, ob es Therapien ergänzt und medizinische und technische Leistungen so erfüllt, wie vom Hersteller beschrieben. Knapp ein Jahr hat es gedauert, bis Lands Firma für die Tinnitus-App die Zertifizierung bekommen hat. Der Aufwand hat sich gelohnt. Jetzt finanzieren auch einige Krankenkassen wie die Techniker und Axa das Angebot.
Um Geschäfte mit der Gesundheit zu machen, müssen Unternehmen etliche gesetzliche Regularien einhalten. „Ein Medizinprodukt ist Fleißarbeit“, sagt Land, Geschäftsführer von Sonormed, der Firma, die hinter der Tinnitus-App steht. Es geht um Auflagen zum Schutz der Patienten, darum, ob das neue Produkt den Betroffenen tatsächlich hilft. Darum, ob es Therapien ergänzt und medizinische und technische Leistungen so erfüllt, wie vom Hersteller beschrieben. Knapp ein Jahr hat es gedauert, bis Lands Firma für die Tinnitus-App die Zertifizierung bekommen hat. Der Aufwand hat sich gelohnt. Jetzt finanzieren auch einige Krankenkassen wie die Techniker und Axa das Angebot.

Mit der App „Tinnitracks“ können Patienten ihre Lieblingsmusik so filtern, dass sie zur Tinnitus-Therapie eingesetzt werden kann. Foto: privat
Schließen
Krankenkassen fördern kaum
Krankenkassen fördern kaum

Derzeit gibt es rund 130.000 gesundheitsbezogene Apps auf dem deutschen Markt. Foto: dpa
Vollbild
Die umständliche Zertifizierung sorgt aber dafür, dass solche Apps mit einem therapeutischen Nutzen noch selten sind. Schätzungen zufolge gibt es derzeit rund 130.000 gesundheitsbezogene Apps auf dem deutschen Markt. Gerade einmal 60 davon sind als Medizinprodukt anerkannt, neben „Tinnitracks“ zum Beispiel noch die Diabetes-App „MySugr“ oder die Allergie-App „Husteblume“. Die meisten Gesundheitsapps in den Stores von Apple und Google sind den Bereichen Lifestyle, Sport und Fitness zuzuordnen – wie etwa Schrittzähler, Ernährungsberater oder Trainingsplaner.
App-Entwickler und Unternehmer schreckt vor allem die Bürokratie. Sie müssen etliche Regeln einhalten, Vorschriften berücksichtigen und Studien durchführen, bis sie aus einer Gesundheitsapp ein Medizinprodukt machen und damit Geld verdienen können. Die Bundesregierung hat daher nun ein Innovationszentrum eröffnet, das Start-ups wie Sonormed unterstützen will. Angesiedelt ist das Büro beim Bundesinstitut für Arzneimittel und Medizinprodukte in Bonn. Die Berater der Behörde wollen den Start-ups und Forschern helfen, die eine gute Geschäftsidee haben, aber wenig Erfahrung mit den gesetzlichen Vorgaben.
„Es geht darum, den Entwicklern schon in einer frühen Phase ihres Produkts eine Orientierungshilfe zu geben und so Fehlentscheidungen zu vermeiden“, sagt Maik Pommer, Sprecher des Instituts. Geklärt werden sollen etwa Fragen wie: Wie werden Diagnose und Therapiepläne umgesetzt? Welchen Zusatznutzen hat der Patient? Wie steht es um den Datenschutz? Kommt eine Anerkennung als Medizinprodukt überhaupt infrage? Die Berater wollen den Entwicklern darauf Antworten geben – und zwar bevor sie viel Geld verbrannt haben. Im Zentrum steht aber immer der Schutz der Patienten.
App-Entwickler und Unternehmer schreckt vor allem die Bürokratie. Sie müssen etliche Regeln einhalten, Vorschriften berücksichtigen und Studien durchführen, bis sie aus einer Gesundheitsapp ein Medizinprodukt machen und damit Geld verdienen können. Die Bundesregierung hat daher nun ein Innovationszentrum eröffnet, das Start-ups wie Sonormed unterstützen will. Angesiedelt ist das Büro beim Bundesinstitut für Arzneimittel und Medizinprodukte in Bonn. Die Berater der Behörde wollen den Start-ups und Forschern helfen, die eine gute Geschäftsidee haben, aber wenig Erfahrung mit den gesetzlichen Vorgaben.
„Es geht darum, den Entwicklern schon in einer frühen Phase ihres Produkts eine Orientierungshilfe zu geben und so Fehlentscheidungen zu vermeiden“, sagt Maik Pommer, Sprecher des Instituts. Geklärt werden sollen etwa Fragen wie: Wie werden Diagnose und Therapiepläne umgesetzt? Welchen Zusatznutzen hat der Patient? Wie steht es um den Datenschutz? Kommt eine Anerkennung als Medizinprodukt überhaupt infrage? Die Berater wollen den Entwicklern darauf Antworten geben – und zwar bevor sie viel Geld verbrannt haben. Im Zentrum steht aber immer der Schutz der Patienten.

Derzeit gibt es rund 130.000 gesundheitsbezogene Apps auf dem deutschen Markt. Foto: dpa
Schließen
Zertifizierung ist schwierig
Zertifizierung ist schwierig

Patchie ist eine App, die an Mukoviszidose erkrankten Kindern im Alltag, zum Beispiel bei der Physiotherapie, hilft. Foto: Archiv
Vollbild
Marc Kamps weiß genau, wie schwer es ist, eine Medizin-App auf den Markt zu bringen. Kamps ist Gründer der IT-Firma Birds and Trees. Das Hamburger Unternehmen entwickelt Software, die Therapie und Reha-Maßnahmen digital unterstützen sollen. Seine Idee: Eine App, die an Mukoviszidose erkrankten Kindern im Alltag hilft. Physiotherapie, die Einnahme von Medikamenten, Arztbesuche: Die Therapie der genetisch bedingten Stoffwechselerkrankung ist enorm zeitaufwendig und für Kinder nicht immer verständlich. Mit der App „Patchie“ wird der junge Patient kindgerecht durch die Therapie geleitet.
Kamps will die Krankenkassen davon überzeugen, sein Produkt für die Versicherten zu übernehmen. Damit dies funktioniert braucht Kamps eine Zertifizierung als Medizinprodukt für die App und eine Anerkennung über eine Studie. „Das ist eine Komplexität, die wir vorher nicht einzuschätzen vermochten“, sagt Kamps. Allein die Dokumentation der Software fordert Kamps Team heraus, das zurzeit eine klinische Studie durchführt.
Die Idee zu „Patchie“ kam dem Unternehmer, als bei seinem Sohn die Krankheit diagnostiziert wurde. Selbsthilfegruppen oder auch Ärzte unterstützten schnell die App-Idee. Aber Probleme mit den Regularien und der Finanzierung machen eine schnelle Markteinführung unmöglich. Kamps wünscht sich mehr Unterstützung seitens der Politik, um Medizinprodukte zum Wohle der Patienten schneller zugänglich zu machen.
Kamps will die Krankenkassen davon überzeugen, sein Produkt für die Versicherten zu übernehmen. Damit dies funktioniert braucht Kamps eine Zertifizierung als Medizinprodukt für die App und eine Anerkennung über eine Studie. „Das ist eine Komplexität, die wir vorher nicht einzuschätzen vermochten“, sagt Kamps. Allein die Dokumentation der Software fordert Kamps Team heraus, das zurzeit eine klinische Studie durchführt.
Die Idee zu „Patchie“ kam dem Unternehmer, als bei seinem Sohn die Krankheit diagnostiziert wurde. Selbsthilfegruppen oder auch Ärzte unterstützten schnell die App-Idee. Aber Probleme mit den Regularien und der Finanzierung machen eine schnelle Markteinführung unmöglich. Kamps wünscht sich mehr Unterstützung seitens der Politik, um Medizinprodukte zum Wohle der Patienten schneller zugänglich zu machen.

Patchie ist eine App, die an Mukoviszidose erkrankten Kindern im Alltag, zum Beispiel bei der Physiotherapie, hilft. Foto: Archiv
Schließen
Hart umkämpfter Markt
Hart umkämpfter Markt

Erfolg hat der, der mit einem überzeugenden Konzept die Krankenkassen gewinnen kann. Foto: dpa
Vollbild
Etwa 8000 Menschen sind in Deutschland an Mukoviszidose erkrankt. „Wir müssen einen gesundheitsökonomischen Nachweis liefern, dass die App auch einen Sinn hat“, sagt Kamps. Neun Leute arbeiten derzeit an dem Produkt, hinzu kommen viele Unterstützer. Viel Enthusiasmus und zusätzliche Einsatzbereitschaft bringen seine Mitarbeiter mit, um die App weiterzuentwickeln. Wenn alles klappt, könnte Patchie Ende des Jahres von erkrankten Kindern, ihren Eltern und Ärzten genutzt werden.
Dass es im Gesundheitsmarkt „hart zur Sache geht“, bestätigt auch Jörg Land, der Macher der Tinnitus-App. „Die Zertifizierung allein reicht nicht aus, um ins System reinzukommen“, sagt er. Erfolg hat der, der mit einem überzeugenden Konzept die Krankenkassen gewinnen kann, da diese für ihre Versicherten die Kosten übernehmen können. Genauso wichtig sind die Ärzte. „Wer Medizinprodukte entwickelt, braucht das Vertrauen der Ärzte“, so Land. Schließlich müssen sie ihre Patienten in der Therapie begleiten. Beides hat Land mit seinem Produkt geschafft. Er ist einer von wenigen.
Dass es im Gesundheitsmarkt „hart zur Sache geht“, bestätigt auch Jörg Land, der Macher der Tinnitus-App. „Die Zertifizierung allein reicht nicht aus, um ins System reinzukommen“, sagt er. Erfolg hat der, der mit einem überzeugenden Konzept die Krankenkassen gewinnen kann, da diese für ihre Versicherten die Kosten übernehmen können. Genauso wichtig sind die Ärzte. „Wer Medizinprodukte entwickelt, braucht das Vertrauen der Ärzte“, so Land. Schließlich müssen sie ihre Patienten in der Therapie begleiten. Beides hat Land mit seinem Produkt geschafft. Er ist einer von wenigen.

Erfolg hat der, der mit einem überzeugenden Konzept die Krankenkassen gewinnen kann. Foto: dpa
Schließen
Nachgefragt: „Die Herausforderung ist die lokale und überregionale Gesetzgebung“
Nachgefragt: „Die Herausforderung ist die lokale und überregionale Gesetzgebung“

Urs-Vito Albrecht. Foto: privat
Vollbild
Vielen Start-ups fällt es wegen der komplizierten Gesetzeslage schwer, ihre Apps als Medizinprodukt zertifizieren zu lassen. Das neue Innovationszentrum des Bundes- gesundheitsminis- teriums soll Hemmschwellen abbauen und verhindern, dass Entwickler an vermeintlichen Hürden scheitern. Der Arzt Urs-Vito Albrecht von der Medizinischen Hochschule Hannover setzt sich mit ethisch-rechtlichen Bedingungen für medizinische Apps auseinander und hat Mark Hänsgen erklärt, warum er die Beratungsstelle begrüßt.
Krankenkassen unterstützen nur wenige Gesundheits-Apps. Vor welchen Herausforderungen stehen die Entwickler?
Die größte Herausforderung ist nicht die Entwicklung selbst oder das Beschaffen des notwendigen Kapitals. Es ist die Auseinandersetzung mit der lokalen und überregionalen Gesetzgebung, bedingt durch den grenzüberschreitenden Charakter der Anwendungen und Vertriebskanäle. Die Start-ups müssen nicht nur ihre Anwendung durch und durch kennen, sondern auch noch die gesetzlichen Vorschriften. Verpassen sie das oder scheuen die Auseinandersetzung, laufen sie Gefahr, dass ihre Investitionen aufgrund von Kollisionen mit dem geltenden Recht verpuffen.
Wie können diese ihre Idee am besten zu Geld machen?
Der zweite Gesundheitsmarkt (privat finanzierte Produkte und Dienstleistungen, Anm. d. Red.) wird für den Löwenanteil von Gesundheits-Apps weiterhin der primäre Anlaufpunkt sein. Nachhaltig und finanziell attraktiv ist der Zugang zum ersten Gesundheitsmarkt, etwa die Versorgung durch die gesetzliche und private Krankenversicherung. Hier sind die Hürden allerdings sehr hoch und für viele auch in Zukunft unüberwindlich, wenn die Zugangswege nicht der Technologie angepasst werden.
Was halten Sie vom neuen Innovationszentrum, das solche Start-ups berät?
Ich halte das Angebot des Innovationsbüros vom Konzept für sinnvoll, solange die regulatorische Landschaft derart kompliziert ist. Eine niedrigschwellige Information und Bahnung der Beratung von Gründern und Entwicklern ist immens wichtig, um frühzeitig Hürden zu identifizieren und die Weichen richtig zu stellen helfen. Gründern werden Risiken bewusst und sie können ihre Aufwände besser kalkulieren. Die Beratung kann Abbrüche von Entwicklungen aufgrund regulatorischer Überraschungen vermeiden helfen. Der Erfolg des Innovationsbüros wird davon abhängen, ob die Beratung in der „Sprache“ der Gründer erfolgt: bedürfnis- und zielgruppengerecht.
Krankenkassen unterstützen nur wenige Gesundheits-Apps. Vor welchen Herausforderungen stehen die Entwickler?
Die größte Herausforderung ist nicht die Entwicklung selbst oder das Beschaffen des notwendigen Kapitals. Es ist die Auseinandersetzung mit der lokalen und überregionalen Gesetzgebung, bedingt durch den grenzüberschreitenden Charakter der Anwendungen und Vertriebskanäle. Die Start-ups müssen nicht nur ihre Anwendung durch und durch kennen, sondern auch noch die gesetzlichen Vorschriften. Verpassen sie das oder scheuen die Auseinandersetzung, laufen sie Gefahr, dass ihre Investitionen aufgrund von Kollisionen mit dem geltenden Recht verpuffen.
Wie können diese ihre Idee am besten zu Geld machen?
Der zweite Gesundheitsmarkt (privat finanzierte Produkte und Dienstleistungen, Anm. d. Red.) wird für den Löwenanteil von Gesundheits-Apps weiterhin der primäre Anlaufpunkt sein. Nachhaltig und finanziell attraktiv ist der Zugang zum ersten Gesundheitsmarkt, etwa die Versorgung durch die gesetzliche und private Krankenversicherung. Hier sind die Hürden allerdings sehr hoch und für viele auch in Zukunft unüberwindlich, wenn die Zugangswege nicht der Technologie angepasst werden.
Was halten Sie vom neuen Innovationszentrum, das solche Start-ups berät?
Ich halte das Angebot des Innovationsbüros vom Konzept für sinnvoll, solange die regulatorische Landschaft derart kompliziert ist. Eine niedrigschwellige Information und Bahnung der Beratung von Gründern und Entwicklern ist immens wichtig, um frühzeitig Hürden zu identifizieren und die Weichen richtig zu stellen helfen. Gründern werden Risiken bewusst und sie können ihre Aufwände besser kalkulieren. Die Beratung kann Abbrüche von Entwicklungen aufgrund regulatorischer Überraschungen vermeiden helfen. Der Erfolg des Innovationsbüros wird davon abhängen, ob die Beratung in der „Sprache“ der Gründer erfolgt: bedürfnis- und zielgruppengerecht.

Urs-Vito Albrecht. Foto: privat
Schließen
Warten auf den Notarzt
Notärzte brauchen oft länger als vorgeschrieben
Jeder zehnte Notarzt im Rettungsdienstbezirk Bodensee-Oberschwaben erreicht den Einsatzort nicht in den vorgeschriebenen 15 Minuten. Die sogenannte Hilfsfrist zeichnet auf, in wie viel Prozent der Einsätze dieses Ziel erreicht wird.
Unsere Karte zeigt, wo es derzeit noch offensichtliche Versorgungslücken gibt.
Von Michael Hescheler und Simon Haas
Unsere Karte zeigt, wo es derzeit noch offensichtliche Versorgungslücken gibt.
Von Michael Hescheler und Simon Haas
Hilfsfrist verbessert sich leicht
Hilfsfrist verbessert sich leicht

So schnell können Notärzte vor Ort sein. Karte: Simon Haas
Vollbild
Momentan erreichen die Notärzte einen Wert von 89,1 Prozent (Vorjahr 88,8 Prozent). Im Rettungsdienst wird das vorgegebene Ziel von 95 Prozent fast erreicht. Die Rettungsdienste erzielen eine Quote von 94,3 Prozent (Vorjahr: 94,2 Prozent). Die Zahlen beziehen sich auf die drei Landkreise Bodenseekreis (-> zum Artikel), Ravensburg (-> zum Artikel) und Sigmaringen. Separate Zahlen für den Landkreis Sigmaringen liegen nicht vor.
Der Chef der Rettungsleitstelle Oberschwaben ist mit der Entwicklung zufrieden. „Es ist uns gelungen, die Frist in beiden Bereichen leicht zu verbessern“, teilt Volker Geier per Mail mit. Der Kreisverband Sigmaringen des Deutschen Roten Kreuzes wünscht sich eine Verbesserung für den Rettungsdienst in der Stadt Sigmaringen. Dort sind aktuell zwei Rettungstransportwagen (RTW) installiert, einer von beiden allerdings nur tagsüber. „Der Standort Sigmaringen sollte gestärkt werden“, sagt der Geschäftsführer des DRK-Kreisverbands, Gerd Will. In der nächsten Sitzung des Bereichsausschusses, der über Verbesserungen im Rettungsdienst entscheidet, soll darüber gesprochen werden.
Um den Rettungsdienst zu entlasten, wurden außerdem zwei Fahrzeuge in Betrieb genommen, die Verlegungen in Krankenhäuser übernehmen. Sowohl in Bad Saulgau als auch in Sigmaringen sind diese Fahrzeuge im Einsatz, die vom Personal und der Technik her ausgestattet sind wie ein Rettungstransportwagen. Diese Leistungen werden jedoch nicht über die Hilfsfrist erfasst, obwohl die Dienste indirekt zusammenhängen.
Der DRK-Kreisverband plant außerdem den Umbau von zwei Rettungswachen im Kreis. Dies könnte sich ebenfalls positiv auf die Versorgung auswirken. So wird in Meßkirch die Wache für 400 000 Euro ertüchtigt. Die Garage soll für ein größeres Fahrzeug umgebaut werden, die Umkleiden der Mitarbeiter und die Sanitärbereiche sollen ebenfalls modernisiert werden. „In Ostrach planen wir Ähnliches“, sagt der DRK-Geschäftsführer. Momentan befindet sich die Wache in den Räumlichkeiten des DRK-Ortsvereins. Dieses Provisorium soll eventuell durch einen Neubau ersetzt werden. Sollte es die Möglichkeit einer Förderung geben, könnte 2018 gebaut werden. Allerdings ist noch keine Entscheidung gefallen. Ein Umbau könnte sich positiv auf die Ausrückzeit auswirken, da sich die Mitarbeiterräume in Ostrach im ersten Obergeschoss befinden. Sollte hier die räumliche Situation verbessert werden, könnten die Mitarbeiter schneller im Fahrzeug sitzen. Außerdem werde nach einem Standort gesucht, der das Einzugsgebiet optimal abbilde.
Der Chef der Rettungsleitstelle Oberschwaben ist mit der Entwicklung zufrieden. „Es ist uns gelungen, die Frist in beiden Bereichen leicht zu verbessern“, teilt Volker Geier per Mail mit. Der Kreisverband Sigmaringen des Deutschen Roten Kreuzes wünscht sich eine Verbesserung für den Rettungsdienst in der Stadt Sigmaringen. Dort sind aktuell zwei Rettungstransportwagen (RTW) installiert, einer von beiden allerdings nur tagsüber. „Der Standort Sigmaringen sollte gestärkt werden“, sagt der Geschäftsführer des DRK-Kreisverbands, Gerd Will. In der nächsten Sitzung des Bereichsausschusses, der über Verbesserungen im Rettungsdienst entscheidet, soll darüber gesprochen werden.
Um den Rettungsdienst zu entlasten, wurden außerdem zwei Fahrzeuge in Betrieb genommen, die Verlegungen in Krankenhäuser übernehmen. Sowohl in Bad Saulgau als auch in Sigmaringen sind diese Fahrzeuge im Einsatz, die vom Personal und der Technik her ausgestattet sind wie ein Rettungstransportwagen. Diese Leistungen werden jedoch nicht über die Hilfsfrist erfasst, obwohl die Dienste indirekt zusammenhängen.
Der DRK-Kreisverband plant außerdem den Umbau von zwei Rettungswachen im Kreis. Dies könnte sich ebenfalls positiv auf die Versorgung auswirken. So wird in Meßkirch die Wache für 400 000 Euro ertüchtigt. Die Garage soll für ein größeres Fahrzeug umgebaut werden, die Umkleiden der Mitarbeiter und die Sanitärbereiche sollen ebenfalls modernisiert werden. „In Ostrach planen wir Ähnliches“, sagt der DRK-Geschäftsführer. Momentan befindet sich die Wache in den Räumlichkeiten des DRK-Ortsvereins. Dieses Provisorium soll eventuell durch einen Neubau ersetzt werden. Sollte es die Möglichkeit einer Förderung geben, könnte 2018 gebaut werden. Allerdings ist noch keine Entscheidung gefallen. Ein Umbau könnte sich positiv auf die Ausrückzeit auswirken, da sich die Mitarbeiterräume in Ostrach im ersten Obergeschoss befinden. Sollte hier die räumliche Situation verbessert werden, könnten die Mitarbeiter schneller im Fahrzeug sitzen. Außerdem werde nach einem Standort gesucht, der das Einzugsgebiet optimal abbilde.

So schnell können Notärzte vor Ort sein. Karte: Simon Haas
Schließen
Keine ausgefallenen Fahrzeuge
Keine ausgefallenen Fahrzeuge

Der DRK-Kreisverband plant außerdem den Umbau von zwei Rettungswachen im Kreis Sigmaringen. Foto: dpa
Vollbild
Insgesamt macht der Personalmangel dem Rettungsdienst im Landkreis Sigmaringen weniger zu schaffen als anderswo. „Bislang sind noch keine Fahrzeuge ausgefallen“, sagt der DRK-Geschäftsführer, „wir kriegen den Rettungsdienst gestemmt“.
Beim Malteser Hilfsdienst werden die Hilfsfristen mit dem Rettungsdienst im Kreis Sigmaringen in 94 bis 95 Prozent der Fälle eingehalten. Beim Notarzt ist dies bei über 90 Prozent der Einsätze der Fall. Das sagt Roland Beierl, AOK-Geschäftsführer und Vorsitzender des Bereichsausschusses des Rettungsdiensts Bodensee-Oberschwaben.
Derzeit werden strukturelle Änderungen geplant, die die Ergebnisse weiter verbessern sollen.
Weitere Berichte zu dem Thema:
- Anfahrtszeiten von Rettungswagen variieren in Lindau
- Notfallversorgung in Argenbühl ist gewährleistet
Beim Malteser Hilfsdienst werden die Hilfsfristen mit dem Rettungsdienst im Kreis Sigmaringen in 94 bis 95 Prozent der Fälle eingehalten. Beim Notarzt ist dies bei über 90 Prozent der Einsätze der Fall. Das sagt Roland Beierl, AOK-Geschäftsführer und Vorsitzender des Bereichsausschusses des Rettungsdiensts Bodensee-Oberschwaben.
Derzeit werden strukturelle Änderungen geplant, die die Ergebnisse weiter verbessern sollen.
Weitere Berichte zu dem Thema:
- Anfahrtszeiten von Rettungswagen variieren in Lindau
- Notfallversorgung in Argenbühl ist gewährleistet

Der DRK-Kreisverband plant außerdem den Umbau von zwei Rettungswachen im Kreis Sigmaringen. Foto: dpa
Schließen
Ernährungsratgeber ohne Ende
„Essen ist längst angstbesetzt“
Der Lebensmittelchemiker Udo Pollmer hält fleischlose Ernährung für Unsinn. Er appelliert an Instinkt und Appetit des Menschen.
Von Dirk Grupe
Von Dirk Grupe
Immer für eine Provokation gut
Immer für eine Provokation gut

Udo Pollmer auf der Terrasse seiner Schlossetage. Foto: Dirk Grupe
Vollbild
Udo Pollmer ist eine barocke Erscheinung, die in einem spätmittelalterlichen Schloss wohnt. Es ist zwar nur das kleine „Unterschloss Gemmingen“ bei Heilbronn, das aber sehr idyllisch erscheint mit seinem Renaissanceportal aus Sandstein, den Kreuzrippengewölben und den breiten Holzdielen, die großzügige Räume schmücken. Es gibt auch einen Hungerturm, den der Hausherr aber nur selten besuchen dürfte. Der 62-Jährige hat einen für sein Alter angemessenen Bauchumfang, er lacht und er speist gerne. Die Schlossetage, die er mit seiner Frau bewohnt, ist mit Büchern vollgepackt, Pollmer gehört zu den gefragtesten Lebensmittelchemikern im deutschsprachigen Raum. Er ist Dozent, Referent, Fachbuchautor („Lexikon der populären Ernährungsirrtümer“, „Don't go Veggie“), wissenschaftlicher Leiter des Europäischen Instituts für Lebensmittel- und Ernährungswissenschaften und leitet die Sendung Mahlzeit im Deutschlandradio.
Pollmer kann provozieren, er lobt tierisches Fett, Wurstsalat sei reicher an Vitamin C als Kopfsalat, Pommes für Kinder besser als Pellkartoffel (wegen der Giftstoffe in der Schale) und nicht Zucker, sondern Süßstoff mache dick. Der Wissenschaftler hat mal den Unmut der Lebensmittelindustrie auf sich gezogen, mal von Ernährungsberatern, dann von Vegetariern und Veganern. Nach „Dont't go Veggie“ soll er Morddrohungen erhalten haben. Dabei sei sein Anliegen doch nur der Kampf gegen die Dummheit. Vor allem fleischlose Ernährung hält er für ein Lifestyleverhalten, für ein modernes Ernährungsmärchen, das viel verspreche, nichts halte, schlimmstenfalls krank mache und keiner wissenschaftlichen Überprüfung stand halte. Pollmer möchte, dass die Menschen wieder ihrem Instinkt trauen, dass sie essen, worauf sie Lust, worauf sie Appetit haben. Zum Interview bei strahlendem Sonnenschein auf dem Burgbalkon bringt seine Frau Kaffee und Butterkekse, deren dünner Schokoladenguss schnell schmilzt. Womit wir beim Thema wären.
Pollmer kann provozieren, er lobt tierisches Fett, Wurstsalat sei reicher an Vitamin C als Kopfsalat, Pommes für Kinder besser als Pellkartoffel (wegen der Giftstoffe in der Schale) und nicht Zucker, sondern Süßstoff mache dick. Der Wissenschaftler hat mal den Unmut der Lebensmittelindustrie auf sich gezogen, mal von Ernährungsberatern, dann von Vegetariern und Veganern. Nach „Dont't go Veggie“ soll er Morddrohungen erhalten haben. Dabei sei sein Anliegen doch nur der Kampf gegen die Dummheit. Vor allem fleischlose Ernährung hält er für ein Lifestyleverhalten, für ein modernes Ernährungsmärchen, das viel verspreche, nichts halte, schlimmstenfalls krank mache und keiner wissenschaftlichen Überprüfung stand halte. Pollmer möchte, dass die Menschen wieder ihrem Instinkt trauen, dass sie essen, worauf sie Lust, worauf sie Appetit haben. Zum Interview bei strahlendem Sonnenschein auf dem Burgbalkon bringt seine Frau Kaffee und Butterkekse, deren dünner Schokoladenguss schnell schmilzt. Womit wir beim Thema wären.

Udo Pollmer auf der Terrasse seiner Schlossetage. Foto: Dirk Grupe
Schließen
Macht über andere Menschen
Macht über andere Menschen

Kaffee wurde jahrzehntelang als Wasserräuber verteufelt. Foto: dpa
Vollbild
Herr Pollmer, mein Opa war ein Wiener Konditor, meine Mutter kam aus Böhmen und konnte entsprechend deftig kochen. Schaue ich allerdings in mein Innerstes, muss ich feststellen, dass Fett, Zucker und Kohlenhydrate auch bei mir negativ besetzt sind. Wie kommt das?
Wenn es an allen Ecken und Enden gepfiffen und geschrieben wird, bleibt auch was hängen. Überall werden gertenschlanke – oft unterernährte – Mädels gezeigt, was dazu führt, dass viele Frauen einem Schönheitsideal hinterherlaufen, das für sie völlig unrealistisch ist, vor allem in reiferem Alter.
Das klingt etwas freudlos …
Essen ist längst angstbesetzt. Es wird gedroht, wenn du dich nicht vorschriftsmäßig ernährst, dann wirst du erst fett, dann krank und schließlich stirbst du daran. Das Dauerfeuer mit Gesundheitsdrohungen bei „ungesunder Ernährung“ hat Folgen. Mit den Angstparolen und dem Versprechen ewiger Jugend gewinnt man leicht Macht über andere Menschen.
Das Schönheitsideal ist die eine Sache, eine sinnvolle Ernährungsberatung aber doch die andere, oder?
Die Ermahnungen der Beraterinnen zielen doch darauf ab, all das schlechtzureden, was der Mensch gerne isst. Nehmen wir nur den Kaffee, der wurde jahrzehntelang verteufelt als Wasserräuber. Einer polnischen Putzfrau können sie das nicht erzählen, die weiß, dass sie Wasser braucht, wenn sie Kaffee aufsetzt. Allein dass sich eine Gesellschaft auf die Idee einlässt, dass das Trinken von Kaffeewasser das Wasser raubt, lässt auf eine bedenkliche Lage schließen.
Die Sache mit dem Kaffee ist inzwischen geklärt …
… aber nicht durch die Ernährungsberatung. Dafür erfindet sie immer was Neues. Der Kaffee war ungesund, weil er ein klein wenig harntreibend ist, nun sollen wir Kürbis essen, denn der „spült die Niere“. Der Kürbis ist gesund, weil er nach nix schmeckt. Der wird dann raffiniert mit Ingwer und Zitronengras gewürzt, damit man ihn runterkriegt. Sollen sie doch alte Socken verkochen: kalorienarm, fettarm, zuckerfrei, dafür aber echt ballaststoffreich. Nur etwas Ingwer und Zimt dazu …
Wenn es an allen Ecken und Enden gepfiffen und geschrieben wird, bleibt auch was hängen. Überall werden gertenschlanke – oft unterernährte – Mädels gezeigt, was dazu führt, dass viele Frauen einem Schönheitsideal hinterherlaufen, das für sie völlig unrealistisch ist, vor allem in reiferem Alter.
Das klingt etwas freudlos …
Essen ist längst angstbesetzt. Es wird gedroht, wenn du dich nicht vorschriftsmäßig ernährst, dann wirst du erst fett, dann krank und schließlich stirbst du daran. Das Dauerfeuer mit Gesundheitsdrohungen bei „ungesunder Ernährung“ hat Folgen. Mit den Angstparolen und dem Versprechen ewiger Jugend gewinnt man leicht Macht über andere Menschen.
Das Schönheitsideal ist die eine Sache, eine sinnvolle Ernährungsberatung aber doch die andere, oder?
Die Ermahnungen der Beraterinnen zielen doch darauf ab, all das schlechtzureden, was der Mensch gerne isst. Nehmen wir nur den Kaffee, der wurde jahrzehntelang verteufelt als Wasserräuber. Einer polnischen Putzfrau können sie das nicht erzählen, die weiß, dass sie Wasser braucht, wenn sie Kaffee aufsetzt. Allein dass sich eine Gesellschaft auf die Idee einlässt, dass das Trinken von Kaffeewasser das Wasser raubt, lässt auf eine bedenkliche Lage schließen.
Die Sache mit dem Kaffee ist inzwischen geklärt …
… aber nicht durch die Ernährungsberatung. Dafür erfindet sie immer was Neues. Der Kaffee war ungesund, weil er ein klein wenig harntreibend ist, nun sollen wir Kürbis essen, denn der „spült die Niere“. Der Kürbis ist gesund, weil er nach nix schmeckt. Der wird dann raffiniert mit Ingwer und Zitronengras gewürzt, damit man ihn runterkriegt. Sollen sie doch alte Socken verkochen: kalorienarm, fettarm, zuckerfrei, dafür aber echt ballaststoffreich. Nur etwas Ingwer und Zimt dazu …

Kaffee wurde jahrzehntelang als Wasserräuber verteufelt. Foto: dpa
Schließen
Pauschale Ernährungsempfehlungen sind ein Zeichen von Inkompetenz
Pauschale Ernährungsempfehlungen sind ein Zeichen von Inkompetenz

Zucker dagegen ist ein pflanzliches Naturprodukt, das in der Regel unproblematisch ist, meint Pollmer. Foto: dpa
Vollbild
Aber es gibt Studien, etwa über Zucker oder Fettleibigkeit, die lügen doch nicht, oder?
Man muss sich die Studien halt genau ansehen. Etwa über Fettleibigkeit, da wird dann von den Autoren behauptet, dass Zucker dafür verantwortlich sei. Schaut man genauer hin, dann sieht man, dass der Effekt auf die Süßstoffe zurückzuführen ist. Süßstoffe werden nicht umsonst seit vielen Jahren als Mastmittel in der Tierhaltung verwendet. Die Tiere nehmen bei gleicher kalorischer Zufuhr schneller zu. Beim Menschen machen Süßstoffe nicht nur fettleibig, sondern begünstigen Herzkreislauferkrankungen und schädigen die Darmflora. Insgesamt sinkt die Lebenserwartung. Zucker dagegen ist ein pflanzliches Naturprodukt, das in der Regel unproblematisch ist.
In der Regel?
Weil die Menschen unterschiedlich sind. Jeder ist anders, hat ein anderes Immunsystem und einen anderen Stoffwechsel. Was dem einen nützt, kann dem nächsten schaden, weil er es nicht verträgt – egal ob Milchzucker, Äpfel oder Alkohol. Da in der Arktis keine Pflanzen verfügbar sind, die Zucker enthalten, vertragen einige Inuit-Kinder keinen Haushaltszucker. Pauschale Ernährungsempfehlungen sind ein Zeichen von Inkompetenz. Wer versucht, bei der Ernährung alles auf die gleiche Linie zu trimmen, könnte genauso gut hergehen und sagen, Schuhgröße 32 macht die Füße gesund, also müssen alle Schuhe der Größe 32 tragen. Natürlich kann man das durch eine Studie beweisen: Heranwachsende haben kleinere Schuhgrößen und ihre Füße sind noch nicht so abgelatscht, wie bei einem älteren Semester. Dann kommen Schuhgesundheitsberaterinnen, die Tipps und Tricks ablaichen, wie man seine Füße in zu kleine Schühchen kriegt. Nichts anderes ist diese Ernährungsberaterei.
In dem Fall wäre Ernährungsberatung sogar ungesund …
… sicher, nehmen Sie nur die selbstgemachten grünen Smoothies. Da wird doch ernsthaft geraten, Laub von den Bäumen zu nehmen, dazu alles Grüne für die Biotonne samt Schalen, schließlich kommen noch „Heilkräuter“ dazu. Das schmeckt bitter und scheußlich, also wird mit Süßstoff nachgeholfen. Das ganze reicht nicht selten für einen Leberschaden. Wenn die Plörre den Tag über in einer Karaffe auf dem Schreibtisch steht, gärt das außerdem prima, da fühlen sich die Keime wie im siebten Himmel und vermehren sich rasend schnell.
Aber braucht es bei so viel Unsicherheit in Sachen Ernährung nicht auch fachliche Beratung?
Ohne die Flut an Ernährungstipps – egal ob aus dem Internet, aus Magazinen oder durch Beratung – wäre der Unsinn doch gar nicht verbreitet worden.
Man muss sich die Studien halt genau ansehen. Etwa über Fettleibigkeit, da wird dann von den Autoren behauptet, dass Zucker dafür verantwortlich sei. Schaut man genauer hin, dann sieht man, dass der Effekt auf die Süßstoffe zurückzuführen ist. Süßstoffe werden nicht umsonst seit vielen Jahren als Mastmittel in der Tierhaltung verwendet. Die Tiere nehmen bei gleicher kalorischer Zufuhr schneller zu. Beim Menschen machen Süßstoffe nicht nur fettleibig, sondern begünstigen Herzkreislauferkrankungen und schädigen die Darmflora. Insgesamt sinkt die Lebenserwartung. Zucker dagegen ist ein pflanzliches Naturprodukt, das in der Regel unproblematisch ist.
In der Regel?
Weil die Menschen unterschiedlich sind. Jeder ist anders, hat ein anderes Immunsystem und einen anderen Stoffwechsel. Was dem einen nützt, kann dem nächsten schaden, weil er es nicht verträgt – egal ob Milchzucker, Äpfel oder Alkohol. Da in der Arktis keine Pflanzen verfügbar sind, die Zucker enthalten, vertragen einige Inuit-Kinder keinen Haushaltszucker. Pauschale Ernährungsempfehlungen sind ein Zeichen von Inkompetenz. Wer versucht, bei der Ernährung alles auf die gleiche Linie zu trimmen, könnte genauso gut hergehen und sagen, Schuhgröße 32 macht die Füße gesund, also müssen alle Schuhe der Größe 32 tragen. Natürlich kann man das durch eine Studie beweisen: Heranwachsende haben kleinere Schuhgrößen und ihre Füße sind noch nicht so abgelatscht, wie bei einem älteren Semester. Dann kommen Schuhgesundheitsberaterinnen, die Tipps und Tricks ablaichen, wie man seine Füße in zu kleine Schühchen kriegt. Nichts anderes ist diese Ernährungsberaterei.
In dem Fall wäre Ernährungsberatung sogar ungesund …
… sicher, nehmen Sie nur die selbstgemachten grünen Smoothies. Da wird doch ernsthaft geraten, Laub von den Bäumen zu nehmen, dazu alles Grüne für die Biotonne samt Schalen, schließlich kommen noch „Heilkräuter“ dazu. Das schmeckt bitter und scheußlich, also wird mit Süßstoff nachgeholfen. Das ganze reicht nicht selten für einen Leberschaden. Wenn die Plörre den Tag über in einer Karaffe auf dem Schreibtisch steht, gärt das außerdem prima, da fühlen sich die Keime wie im siebten Himmel und vermehren sich rasend schnell.
Aber braucht es bei so viel Unsicherheit in Sachen Ernährung nicht auch fachliche Beratung?
Ohne die Flut an Ernährungstipps – egal ob aus dem Internet, aus Magazinen oder durch Beratung – wäre der Unsinn doch gar nicht verbreitet worden.

Zucker dagegen ist ein pflanzliches Naturprodukt, das in der Regel unproblematisch ist, meint Pollmer. Foto: dpa
Schließen
Veganismus tritt wie eine religiöse Bewegung auf
Veganismus tritt wie eine religiöse Bewegung auf

Pollmer: "Heute werden Nutztiere in aller Regel so geschlachtet, dass sie davon nichts mitbekommen." Foto: dpa
Vollbild
Manche Veganer und Vegetarier sagen, eigentlich mag ich Fleisch, ich möchte aber nicht, dass Tiere wegen mir leiden müssen. Das klingt doch plausibel?
Diese Vorstellung unterstellt, dass Tiere leiden, wenn sie vom Menschen gehalten werden. Außerdem sprechen diese Personen den Tieren die Freude am Leben ab. Werfen Sie doch einfach mal einen Blick in einen Stall! Bitte in einen realen Stall und nicht nur in die Propagandavideos im Internet. Heute werden Nutztiere in aller Regel so geschlachtet, dass sie davon nichts mitbekommen. Der „natürliche Tod“ in freier Wildbahn ist oft genug ein elender. Unsachgemäßen Umgang mit Tieren oder auch Menschen gibt es immer wieder. Aber weil in Krankenhäusern üble Kunstfehler mit Todesfolge passieren, wird doch niemand fordern „zur Vermeidung von Leid“ die Behandlung von Kranken einzustellen.
Aber bei der Tierhaltung und auch bei Veganimus geht es doch um mehr als Ernährung, es geht um Ideologie, um Lebenseinstellung, oder?
Veganismus tritt wie eine religiöse Bewegung auf. Wäre es nur eine Ernährungsform, dann wäre sie so spannend wie eine neue Brigitte-Diät. Die Religion ist oftmals nur Fassade. Die veganen Webseiten versprechen selbstredend „ein normales Körpergewicht“, was nichts anderes heißt als Schlankheit. Wenn ich Veganerin bin, muss ich nirgends mitessen. Ich habe immer eine Ausrede, ich kann immer Diät machen – aus reiner Tierliebe.
Eine Diät, die immerhin eingehalten wird …
… es mangelt nicht an veganen Maulhelden. Sie betonen ihre „Heiligkeit“ und essen, wenn es keiner sieht, tierische Produkte. Die wenigsten halten es wirklich durch, viele geben auf, nicht selten, weil sie krank werden.
Diese Vorstellung unterstellt, dass Tiere leiden, wenn sie vom Menschen gehalten werden. Außerdem sprechen diese Personen den Tieren die Freude am Leben ab. Werfen Sie doch einfach mal einen Blick in einen Stall! Bitte in einen realen Stall und nicht nur in die Propagandavideos im Internet. Heute werden Nutztiere in aller Regel so geschlachtet, dass sie davon nichts mitbekommen. Der „natürliche Tod“ in freier Wildbahn ist oft genug ein elender. Unsachgemäßen Umgang mit Tieren oder auch Menschen gibt es immer wieder. Aber weil in Krankenhäusern üble Kunstfehler mit Todesfolge passieren, wird doch niemand fordern „zur Vermeidung von Leid“ die Behandlung von Kranken einzustellen.
Aber bei der Tierhaltung und auch bei Veganimus geht es doch um mehr als Ernährung, es geht um Ideologie, um Lebenseinstellung, oder?
Veganismus tritt wie eine religiöse Bewegung auf. Wäre es nur eine Ernährungsform, dann wäre sie so spannend wie eine neue Brigitte-Diät. Die Religion ist oftmals nur Fassade. Die veganen Webseiten versprechen selbstredend „ein normales Körpergewicht“, was nichts anderes heißt als Schlankheit. Wenn ich Veganerin bin, muss ich nirgends mitessen. Ich habe immer eine Ausrede, ich kann immer Diät machen – aus reiner Tierliebe.
Eine Diät, die immerhin eingehalten wird …
… es mangelt nicht an veganen Maulhelden. Sie betonen ihre „Heiligkeit“ und essen, wenn es keiner sieht, tierische Produkte. Die wenigsten halten es wirklich durch, viele geben auf, nicht selten, weil sie krank werden.

Pollmer: "Heute werden Nutztiere in aller Regel so geschlachtet, dass sie davon nichts mitbekommen." Foto: dpa
Schließen
Formel für ein gesundes Leben
Formel für ein gesundes Leben

Der Landwirt baut wann immer möglich Nahrung für den Menschen an, erklärt Pollmer. Foto: dpa
Vollbild
Auf dem Buchdeckel von „Don’t go Veggie“ steht, es sei eine „Kampfschrift“, sie provozieren auch gerne. Braucht es das denn heute wirklich?
Veganer sind die aggressivste Gruppe unter den „Besseressern“. Zudem haben sie die windigsten Argumente, mit denen sie versuchen, vor allem junge Menschen zu einer unethischen Ernährungsweise zu verleiten. Ein Beispiel: Es wird behauptet, dass man die Flächen für den Anbau von Futtermitteln auch nutzen könnte, um Nahrung für den Menschen zu produzieren. Nach Angaben der Welternährungsorganisation FAO sind zwei Drittel der gesamten Agrarfläche des Globus nur zur Tierhaltung geeignet. In Deutschland sind stolze 30 Prozent Grünland. Der Landwirt baut wann immer möglich Nahrung für den Menschen an - weil er dafür wesentlich mehr Geld bekommt als für Futter.
Eine Frage zum Schluss: Neulich titelte ein Nachrichtenmagazin: „Die Formel für ein gesundes Leben“. Was wäre Ihre Formel für ein gesundes Leben?
Da halte ich mich an Albert Einstein: Wenn a für Erfolg steht gilt: a=x+y+z; x bedeutet Arbeit, y ist Muße und z heißt Mundhalten
Veganer sind die aggressivste Gruppe unter den „Besseressern“. Zudem haben sie die windigsten Argumente, mit denen sie versuchen, vor allem junge Menschen zu einer unethischen Ernährungsweise zu verleiten. Ein Beispiel: Es wird behauptet, dass man die Flächen für den Anbau von Futtermitteln auch nutzen könnte, um Nahrung für den Menschen zu produzieren. Nach Angaben der Welternährungsorganisation FAO sind zwei Drittel der gesamten Agrarfläche des Globus nur zur Tierhaltung geeignet. In Deutschland sind stolze 30 Prozent Grünland. Der Landwirt baut wann immer möglich Nahrung für den Menschen an - weil er dafür wesentlich mehr Geld bekommt als für Futter.
Eine Frage zum Schluss: Neulich titelte ein Nachrichtenmagazin: „Die Formel für ein gesundes Leben“. Was wäre Ihre Formel für ein gesundes Leben?
Da halte ich mich an Albert Einstein: Wenn a für Erfolg steht gilt: a=x+y+z; x bedeutet Arbeit, y ist Muße und z heißt Mundhalten

Der Landwirt baut wann immer möglich Nahrung für den Menschen an, erklärt Pollmer. Foto: dpa
Schließen
Therapie mit Glauben und Globul
Therapie mit Glauben und Globuli
Globuli, Akupunktur, Misteltherapie: Es gibt mehr als 150 Verfahren, die nicht zur klassischen Schulmedizin zählen. Ihre Wirksamkeit ist oft umstritten, doch viele Patienten schwören darauf. Mittlerweile widmen sich einige Universitäten der Frage, wie alternative Verfahren und klassische Medizin gemeinsam Menschen helfen können.
Von Katja Korf
Von Katja Korf
Ergänzen, nicht ersetzen
Ergänzen, nicht ersetzen

60 Prozent der Deutschen haben schon einmal homöopathische Mittel genommen. Foto: dpa
Vollbild
60 Prozent der Deutschen haben schon einmal homöopathische Mittel genommen. Doch nach heutigem Forschungsstand wirken Globuli nicht besser als Placebos, also Tabletten ohne jeden Wirkstoff. Andererseits gibt es viele Verfahren außerhalb der Schulmedizin, die durchaus helfen.
„Es gibt ein riesiges Feld von Anwendungen, die oft auch noch abhängig davon variieren, wer sie durchführt“, sagt Professor Dieter Melchart. Er forscht an der TU München zur Komplementärmedizin. Schon im Wort steckt ein Bekenntnis. „Komplementärmedizin heißt: Methoden, welche die klassische Medizin ergänzen – aber eben nicht ersetzen“, sagt der Mediziner.
Im Gegensatz zu vielen alternativen Verfahren müssen schulmedizinische Therapien zunächst erwiesenermaßen beim Patienten wirken, bevor sie flächendeckend angewandt werden dürfen. Deshalb spricht man von evidenzbasierter Medizin – also von Therapien, die aufgrund zahlreicher Studien bei Patienten mit einem bestimmten Krankheitsbild einen erwiesenen Nutzen haben. „Für viele Verfahren der Komplementärmedizin gibt es zwar klinische Studien, häufig aber mit geringen Fallzahlen und unzureichend kontrolliert“, erläutert Professorin Yvonne Samstag vom Akademischen Zentrum für komplementäre und integrative Medizin (Akzim), einem neuen Forschungsverbund in Baden-Württemberg. Der Vorwurf der Schulmedizin an viele Therapeuten: Sie seien oft gar nicht daran interessiert, ihre Methoden zu überprüfen. Stattdessen verteufelten sie Schulmedizin und rieten Patienten, lebenswichtige Medikamente abzusetzen.
„Es gibt ein riesiges Feld von Anwendungen, die oft auch noch abhängig davon variieren, wer sie durchführt“, sagt Professor Dieter Melchart. Er forscht an der TU München zur Komplementärmedizin. Schon im Wort steckt ein Bekenntnis. „Komplementärmedizin heißt: Methoden, welche die klassische Medizin ergänzen – aber eben nicht ersetzen“, sagt der Mediziner.
Im Gegensatz zu vielen alternativen Verfahren müssen schulmedizinische Therapien zunächst erwiesenermaßen beim Patienten wirken, bevor sie flächendeckend angewandt werden dürfen. Deshalb spricht man von evidenzbasierter Medizin – also von Therapien, die aufgrund zahlreicher Studien bei Patienten mit einem bestimmten Krankheitsbild einen erwiesenen Nutzen haben. „Für viele Verfahren der Komplementärmedizin gibt es zwar klinische Studien, häufig aber mit geringen Fallzahlen und unzureichend kontrolliert“, erläutert Professorin Yvonne Samstag vom Akademischen Zentrum für komplementäre und integrative Medizin (Akzim), einem neuen Forschungsverbund in Baden-Württemberg. Der Vorwurf der Schulmedizin an viele Therapeuten: Sie seien oft gar nicht daran interessiert, ihre Methoden zu überprüfen. Stattdessen verteufelten sie Schulmedizin und rieten Patienten, lebenswichtige Medikamente abzusetzen.

60 Prozent der Deutschen haben schon einmal homöopathische Mittel genommen. Foto: dpa
Schließen
Vorsicht vor Scharlatanen
Vorsicht vor Scharlatanen

Oft wird Schwerstkranken weisgemacht, mit Globuli ließen sich ihre Krankheiten heilen. Foto:dpa
Vollbild
Davor warnen Experten ausdrücklich. Es gebe zu viele Therapeuten ohne medizinische Ausbildung, die Heilung versprächen. „Am Leiden besonders Schwerkranker, die an Krebs, HIV oder Multipler Sklerose leiden, bereichern sich unseriöse Therapeuten“, sagt die Medizinjournalistin Christa Federspiel.
Sie empfiehlt, auch bei Heilpraktikern Vorsicht walten zu lassen. Für diese ist in Deutschland kein einheitlicher Ausbildungsgang vorgeschrieben. Sie müssen eine Prüfung ablegen – die sie aber beliebig oft wiederholen können. „Sie haben auch nie gelernt, Diagnosen zu stellen“, warnt Federspiel. Wer behaupte, mithilfe von Pendeln, Kinesiologie oder Irisdiagnostik Krankheiten erkennen zu können, „ist ein Scharlatan, dafür gibt es keinen belastbaren Nachweis“.
Heilpraktiker wenden einen Großteil der komplementären Verfahren an, auch wenn es viele Ärzte gibt, die eine Weiterbildung in Naturheilkunde haben. „Man muss darauf achten, ob Therapeuten ihre Verfahren als Ersatz zu schulmedizinischen Behandlungen anpreisen“, sagt Melchart. Zu oft würde selbst Schwerstkranken weisgemacht, mit Pflanzenheilkunde oder Globuli ließen sich ihre Krankheiten heilen. Das sei aber nie der Fall. Außerdem sollten sich Patienten einen Therapieplan zeigen lassen, der Ziel, Dauer und Kosten der Behandlung klar benennt. Eine Begleitung durch einen Arzt macht Sinn.
Sie empfiehlt, auch bei Heilpraktikern Vorsicht walten zu lassen. Für diese ist in Deutschland kein einheitlicher Ausbildungsgang vorgeschrieben. Sie müssen eine Prüfung ablegen – die sie aber beliebig oft wiederholen können. „Sie haben auch nie gelernt, Diagnosen zu stellen“, warnt Federspiel. Wer behaupte, mithilfe von Pendeln, Kinesiologie oder Irisdiagnostik Krankheiten erkennen zu können, „ist ein Scharlatan, dafür gibt es keinen belastbaren Nachweis“.
Heilpraktiker wenden einen Großteil der komplementären Verfahren an, auch wenn es viele Ärzte gibt, die eine Weiterbildung in Naturheilkunde haben. „Man muss darauf achten, ob Therapeuten ihre Verfahren als Ersatz zu schulmedizinischen Behandlungen anpreisen“, sagt Melchart. Zu oft würde selbst Schwerstkranken weisgemacht, mit Pflanzenheilkunde oder Globuli ließen sich ihre Krankheiten heilen. Das sei aber nie der Fall. Außerdem sollten sich Patienten einen Therapieplan zeigen lassen, der Ziel, Dauer und Kosten der Behandlung klar benennt. Eine Begleitung durch einen Arzt macht Sinn.

Oft wird Schwerstkranken weisgemacht, mit Globuli ließen sich ihre Krankheiten heilen. Foto:dpa
Schließen
Forschungsdefizit beheben
Forschungsdefizit beheben

Im Land wurde deshalb in diesem Jahr das Akademische Zentrum für komplementäre und integrative Medizin gegründet. Foto: dpa
Vollbild
„Dennoch ist es ja durchaus berechtigt, wenn Patienten auf Mittel setzen, die ihnen subjektiv helfen und Nebenwirkungen vermeiden, die durch möglicherweise gar nicht indizierte schulmedizinische Medikamente ausgelöst werden“, sagt Melchart. Außerdem gibt es zahlreiche Beispiele dafür, dass nicht nur die Schulmedizin Leiden lindern oder die Genesung unterstützen kann. Pflanzliche Mittel verstärken die Wirkung von Chemotherapien. Patienten mit chronischen Rückenschmerzen profitieren mehr von Akupunktur als von herkömmlichen Therapien, Johanniskraut kann Depressionen mildern.
Ein Problem: „In Deutschland basiert Forschung dazu bisher weitestgehend auf Einzelinitiativen und wird fast ausschließlich über Stiftungsgelder finanziert“, so Professorin Samstag. Im Land wurde deshalb in diesem Jahr das Akademische Zentrum für komplementäre und integrative Medizin gegründet. Darin erforschen Wissenschaftler der Unikliniken in Tübingen, Ulm, Heidelberg und Freiburg komplementäre Verfahren – und legen dazu Kriterien an, die für schulmedizinische Therapien gelten.
Sie wollen ihre Erkenntnisse in die Aus- und Weiterbildung junger Ärzte einfließen lassen. Denn, so Wissenschaftsministerin Theresia Bauer (Grüne): „Im Zusammenwirken von konventioneller und Komplementärmedizin liegt gewaltiges Potential – für die Medizin und die Behandlung kranker Menschen.“
Wer Fragen zu alternativen Therapien hat, findet hier Rat:
- Universität Freiburg, Zentrum für Naturheilkunde, Telefon 0761 - 270 82010, www.uni-zentrum-naturheilkunde.de
- Krebsinformationsdienst, Telefon 08004203040; www.krebsinformationsdienst.de
- Ob ein erfahren bereits anerkannter Bestandteil der medizinischen Praxis ist, steht hier www.awmf.org/leitlinien/aktuelle-leitlinien.html
Ein Problem: „In Deutschland basiert Forschung dazu bisher weitestgehend auf Einzelinitiativen und wird fast ausschließlich über Stiftungsgelder finanziert“, so Professorin Samstag. Im Land wurde deshalb in diesem Jahr das Akademische Zentrum für komplementäre und integrative Medizin gegründet. Darin erforschen Wissenschaftler der Unikliniken in Tübingen, Ulm, Heidelberg und Freiburg komplementäre Verfahren – und legen dazu Kriterien an, die für schulmedizinische Therapien gelten.
Sie wollen ihre Erkenntnisse in die Aus- und Weiterbildung junger Ärzte einfließen lassen. Denn, so Wissenschaftsministerin Theresia Bauer (Grüne): „Im Zusammenwirken von konventioneller und Komplementärmedizin liegt gewaltiges Potential – für die Medizin und die Behandlung kranker Menschen.“
Wer Fragen zu alternativen Therapien hat, findet hier Rat:
- Universität Freiburg, Zentrum für Naturheilkunde, Telefon 0761 - 270 82010, www.uni-zentrum-naturheilkunde.de
- Krebsinformationsdienst, Telefon 08004203040; www.krebsinformationsdienst.de
- Ob ein erfahren bereits anerkannter Bestandteil der medizinischen Praxis ist, steht hier www.awmf.org/leitlinien/aktuelle-leitlinien.html

Im Land wurde deshalb in diesem Jahr das Akademische Zentrum für komplementäre und integrative Medizin gegründet. Foto: dpa
Schließen
Depressionen
Wenn junge Seelen leiden
Kinder- und Jugendliche werden immer häufiger depressiv. Frühzeitige Hilfe ist wichtig.
Von Dirk Grupe
Von Dirk Grupe
„Depression kann einen in jedem Alter ereilen“
„Depression kann einen in jedem Alter ereilen“

Isabel Böge, Chefärztin der Abteilung für Psychiatrie und Psychotherapie des Kindes- und Jugendalters des ZfP Südwürttemberg. Foto: privat
Vollbild
Als sich die Eltern scheiden ließen, sagte die Mutter über ihren zwölfjährigen Sohn: „Die Trennung ist nicht einfach für ihn, aber der Jan, der packt das.“ Und der Jan packte es, so sah es zumindest anfangs aus. Er tröstete die Mutter, wenn diese weinte, manchmal machte er das Frühstück. Er blieb aber auch immer öfter zu Hause. Vergrub sich in seinem Zimmer. Meldete sich nicht mehr bei seinen Freunden und seine Freunde meldeten sich nicht bei ihm. Mal war er traurig, mal gereizt. Und als Jan immer öfter der Schule fernbleiben wollte, dachte die Mutter: „Da stimmt was nicht.“ Jan hat es eben nicht geschafft, er bekam eine Depression. Mit zwölf Jahren.
Jan ist ein fiktiver Fall, doch solche oder ähnliche Krankheitsverläufe erlebt Isabel Böge immer wieder. Die Chefärztin der Abteilung für Psychiatrie und Psychotherapie des Kindes- und Jugendalters des ZfP Südwürttemberg in Ravensburg sagt: „Depression kann einen in jedem Alter ereilen.“ Zeigen sich nach Angaben des Robert-Koch-Instituts im Kleinkindalter bei drei Prozent Symptome wie Weinen, Überanhänglichkeit oder vermehrtes Weinen, nimmt die Zahl der Betroffenen mit steigendem Alter zu. In der Grundschule gelten schon zwei Prozent der Kinder als erkrankt, bei den 12 bis 17-Jährigen leiden bis zu zehn Prozent unter Depression. Die Krankheit aber ist selbst für Experten nicht leicht erkennbar: „Depression ist etwas sehr verstecktes“, sagt Isabel Böge.
Jan ist ein fiktiver Fall, doch solche oder ähnliche Krankheitsverläufe erlebt Isabel Böge immer wieder. Die Chefärztin der Abteilung für Psychiatrie und Psychotherapie des Kindes- und Jugendalters des ZfP Südwürttemberg in Ravensburg sagt: „Depression kann einen in jedem Alter ereilen.“ Zeigen sich nach Angaben des Robert-Koch-Instituts im Kleinkindalter bei drei Prozent Symptome wie Weinen, Überanhänglichkeit oder vermehrtes Weinen, nimmt die Zahl der Betroffenen mit steigendem Alter zu. In der Grundschule gelten schon zwei Prozent der Kinder als erkrankt, bei den 12 bis 17-Jährigen leiden bis zu zehn Prozent unter Depression. Die Krankheit aber ist selbst für Experten nicht leicht erkennbar: „Depression ist etwas sehr verstecktes“, sagt Isabel Böge.

Isabel Böge, Chefärztin der Abteilung für Psychiatrie und Psychotherapie des Kindes- und Jugendalters des ZfP Südwürttemberg. Foto: privat
Schließen
Trennung der Eltern ist häufigster Auslöser
Trennung der Eltern ist häufigster Auslöser

Allein in Baden-Württemberg hat sich bei den 10- bis 19-Jährigen die Diagnose Depression in den Jahren von 2000 bis 2012 versechsfacht. Foto: Colourbox
Vollbild
Der Kinder- und Jugendtherapeut Martin Baierl meint, nur die Hälfte aller Fälle werden erkannt, weil Eltern bei Auffälligkeiten eher zum Kinder- oder Hausarzt gingen, aber nicht zum Spezialisten. Außerdem fällt bei Kindern und Jugendlichen die Diagnose schwer, da ihr Verhalten gerne dem Alter, der Pubertät oder einer Phase zugeschrieben werden. Es macht aber einen Unterschied, ob ein Mädchen aus der Laune raus sagt: „Ich bin heute depri drauf“ oder ob es sich innerlich zurückzieht, ob sich Mimik und Gestik reduzieren, ob Ängstlichkeit und Traurigkeit auftreten oder Schlaf- oder Essstörungen hinzukommen. So unterschiedlich Kinder und Jugendliche in ihren Charakteren sind, so vielfältig sind die Symptome. Depression kennt viele Gesichter. Und sie nimmt unter Kinder- und Jugendlichen zu.
Allein in Baden-Württemberg hat sich bei den 10- bis 19-Jährigen die Diagnose Depression in den Jahren von 2000 bis 2012 versechsfacht von 216 auf 1375. Auch in jüngster Zeit nehmen die Fallzahlen weiter zu, das bestätigt Isabel Böge aus ihre Arbeit beim ZfP. Zwar würde heute eine Depression besser erkannt als früher, was sich in der Statistik niederschlage, der eigentliche Grund für die Zunahme liege aber woanders: „Die Familiensysteme werden immer instabiler.“
Kann schon die Arbeitslosigkeit des Vaters dem Nachwuchs aufs Gemüt schlagen, gilt die Trennung der Eltern als häufigster Auslöser einer Depression bei den Kindern. Die gute Nachricht: Einmal, und am besten frühzeitig erkannt, ist sie gut heilbar, wenn auch nur selten über Medikamente. „Bei jungen Menschen sind die Neurorezeptoren noch nicht ausgebildet, an denen die Wirkstoffe für gewöhnlich andocken“, sagt Böge. Alternativ wird gerne Johanniskraut verabreicht, vor allem aber soll eine ambulante Psychotherapie greifen. „Hier wollen wir die falsche Wahrnehmung der Betroffenen korrigieren und ihr Selbstwertgefühl stärken“, sagt die Expertin.
Parallel dazu werde versucht, das Familiensystem zu stabilisieren und Sicherheit über Gleichaltrige zu schaffen, etwa über eine Vereinsmitgliedschaft.
Allein in Baden-Württemberg hat sich bei den 10- bis 19-Jährigen die Diagnose Depression in den Jahren von 2000 bis 2012 versechsfacht von 216 auf 1375. Auch in jüngster Zeit nehmen die Fallzahlen weiter zu, das bestätigt Isabel Böge aus ihre Arbeit beim ZfP. Zwar würde heute eine Depression besser erkannt als früher, was sich in der Statistik niederschlage, der eigentliche Grund für die Zunahme liege aber woanders: „Die Familiensysteme werden immer instabiler.“
Kann schon die Arbeitslosigkeit des Vaters dem Nachwuchs aufs Gemüt schlagen, gilt die Trennung der Eltern als häufigster Auslöser einer Depression bei den Kindern. Die gute Nachricht: Einmal, und am besten frühzeitig erkannt, ist sie gut heilbar, wenn auch nur selten über Medikamente. „Bei jungen Menschen sind die Neurorezeptoren noch nicht ausgebildet, an denen die Wirkstoffe für gewöhnlich andocken“, sagt Böge. Alternativ wird gerne Johanniskraut verabreicht, vor allem aber soll eine ambulante Psychotherapie greifen. „Hier wollen wir die falsche Wahrnehmung der Betroffenen korrigieren und ihr Selbstwertgefühl stärken“, sagt die Expertin.
Parallel dazu werde versucht, das Familiensystem zu stabilisieren und Sicherheit über Gleichaltrige zu schaffen, etwa über eine Vereinsmitgliedschaft.

Allein in Baden-Württemberg hat sich bei den 10- bis 19-Jährigen die Diagnose Depression in den Jahren von 2000 bis 2012 versechsfacht. Foto: Colourbox
Schließen
Anzeichen ernst nehmen
Anzeichen ernst nehmen

Vollbild
Eine stationäre Unterbringung ist eher die Ausnahme, so Böge, auch wenn bei 50 Prozent der Patienten eine Suizidalität vorliegt. Zumal Selbsttötung zu den häufigsten Todesursachen bei Jugendlichen gehört. Allerdings relativiere sich das Bild beim Blick auf die absoluten Zahlen. „In meinen elf Jahren beim ZfP gab es zwei vollzogene Suicide.“ Bei Kindern und Jugendlichen handele es sich eben oft um Momentaufnahmen. „Dann heißt es: ,Jetzt, sofort bringe ich mich um.’ Und eine halbe Stunde später ist alles wieder deutlich besser.“
Ernst nehmen müsse man die Gefahr natürlich trotzdem, das gilt aber auch schon bei Stimmungsschwankungen des Kindes, bei Niedergeschlagenheit oder Gereiztheit – bei Anzeichen einer Depression. „Eltern sollten diese Dinge wahrnehmen, ansprechen und im Zweifel immer einen Experten aufsuchen.“ Und dies lieber einmal zu viel, als einmal zu spät.
Ernst nehmen müsse man die Gefahr natürlich trotzdem, das gilt aber auch schon bei Stimmungsschwankungen des Kindes, bei Niedergeschlagenheit oder Gereiztheit – bei Anzeichen einer Depression. „Eltern sollten diese Dinge wahrnehmen, ansprechen und im Zweifel immer einen Experten aufsuchen.“ Und dies lieber einmal zu viel, als einmal zu spät.

Schließen
Scrollen, um weiterzulesen
Wischen, um weiterzulesen
Wischen, um Text einzublenden

Von Leib und Seele
Von Leib und Seele
 Impressum
Impressum
 „Man muss dem Gehirn immer wieder etwas Neues vorsetzen“
„Man muss dem Gehirn immer wieder etwas Neues vorsetzen“
 Gesundheit ist eine Mischung zwischen Gnade und Wissen
Gesundheit ist eine Mischung zwischen Gnade und Wissen
 Ein Marathonlauf mit 85 muss es sicherlich nicht sein.
Ein Marathonlauf mit 85 muss es sicherlich nicht sein.
 Es geht darum, Bewegung in den Alltag einzubauen
Es geht darum, Bewegung in den Alltag einzubauen
 Diäten machen dick, alle
Diäten machen dick, alle
 Viele Menschen scheuen sich zu kochen.
Viele Menschen scheuen sich zu kochen.
 Den Blick nach vorne und gleichzeitig zurück richten
Den Blick nach vorne und gleichzeitig zurück richten
 Nach der Filmkarriere als Ärztin erfolgreich
Nach der Filmkarriere als Ärztin erfolgreich
 Kampf gegen Adipositas
Kampf gegen Adipositas
 Meist genetisch veranlagt
Meist genetisch veranlagt
 Gesund und lecker
Gesund und lecker
 Hohes Gewicht, wenig Verdienst
Hohes Gewicht, wenig Verdienst
 Adipositas
Adipositas
 Alzheimer: Die Krankheit des Vergessens
Alzheimer: Die Krankheit des Vergessens
 Doch an Lieder von früher erinnert sie sich
Doch an Lieder von früher erinnert sie sich
 Kreuzworträtsel ja, Zaun reparieren nein
Kreuzworträtsel ja, Zaun reparieren nein
 Gestörte Kommunikation
Gestörte Kommunikation
 Fähigkeiten gehen verloren
Fähigkeiten gehen verloren
 Schwierige Suche nach Heilmittel
Schwierige Suche nach Heilmittel
 So werden die älteren und pflegebedürftigen Menschen in unserer Region versorgt
So werden die älteren und pflegebedürftigen Menschen in unserer Region versorgt
 Diabetes trifft immer öfter junge Menschen
Diabetes trifft immer öfter junge Menschen
 Langer Weg bis zur Diagnose
Langer Weg bis zur Diagnose
 Das Krankheitsbild ist oft sehr verschleiert
Das Krankheitsbild ist oft sehr verschleiert
 Spontanität ausgeschlossen
Spontanität ausgeschlossen
 Disziplin ist wichtig
Disziplin ist wichtig
 Forscher arbeiten an einer Insulin-Impfung
Forscher arbeiten an einer Insulin-Impfung
 Glutenfrei ernähren – Notwendigkeit oder Trend?
Glutenfrei ernähren – Notwendigkeit oder Trend?
 Einer von 100 leidet an der Autoimmunerkrankung leidet
Einer von 100 leidet an der Autoimmunerkrankung leidet
 Nachweis über Haut- und Bluttests
Nachweis über Haut- und Bluttests
 Völliger Verzicht nicht notwendig
Völliger Verzicht nicht notwendig
 Professor Thomas Mertens: „Impfpflicht ist politisch nicht durchsetzbar“
Professor Thomas Mertens: „Impfpflicht ist politisch nicht durchsetzbar“
 Globalisierung verändert Ausbreitung und Häufigkeit von Viren
Globalisierung verändert Ausbreitung und Häufigkeit von Viren
 Die meisten Viren leben in Koexistenz mit uns
Die meisten Viren leben in Koexistenz mit uns
 Impfpflicht ist politisch nicht durchsetzbar
Impfpflicht ist politisch nicht durchsetzbar
 Risikoeinschätzung der Menschen ist meist völlig irrational
Risikoeinschätzung der Menschen ist meist völlig irrational
 Impfungen: Sinnvoll oder schädlich?
Impfungen: Sinnvoll oder schädlich?
 Heike von Baum: „Wir alle tragen häufiger solche Keime im Körper als früher“
Heike von Baum: „Wir alle tragen häufiger solche Keime im Körper als früher“
 Keime lassen sich nicht mit herkömmlichen Antibiotika behandeln
Keime lassen sich nicht mit herkömmlichen Antibiotika behandeln
 Handdesinfektion ist ganz wichtig
Handdesinfektion ist ganz wichtig
 Luft nach oben beim Screening der Patienten
Luft nach oben beim Screening der Patienten
 Krankenhäuser in der Region
Krankenhäuser in der Region
 Küssen verboten
Küssen verboten
 Gefährliches Kuscheln
Gefährliches Kuscheln
 Artgerechter Umgang mit den Tieren
Artgerechter Umgang mit den Tieren
 Bei einer Blutvergiftung zählt jede Minute
Bei einer Blutvergiftung zählt jede Minute
 Blutvergiftung ist eine Untergruppe der Sepsis
Blutvergiftung ist eine Untergruppe der Sepsis
 Infektion steht am Anfang
Infektion steht am Anfang
 Ein Drittel der Patienten stirbt
Ein Drittel der Patienten stirbt
 Wenn Wasser krank macht
Wenn Wasser krank macht
 Zehntausende Erkrankte pro Jahr
Zehntausende Erkrankte pro Jahr
 Durch Zufall Krankheitserreger
Durch Zufall Krankheitserreger
 Das Prinzip entschlüsseln
Das Prinzip entschlüsseln
 Mikroben – die fleißigen Untermieter im Darm
Mikroben – die fleißigen Untermieter im Darm
 Jeder Mensch hat sein eigenes Mikrobiom
Jeder Mensch hat sein eigenes Mikrobiom
 Wissenschaft entdeckt den Darm
Wissenschaft entdeckt den Darm
 Immunsystem im Großangriff
Immunsystem im Großangriff
 Impfungen können Krebserkankungen verhindern
Impfungen können Krebserkankungen verhindern
 Jede sechste Krebserkrankung durch eine chronische Infektion ausgelöst
Jede sechste Krebserkrankung durch eine chronische Infektion ausgelöst
 Zahlreiche Erreger bekannt als Krebsrisiko
Zahlreiche Erreger bekannt als Krebsrisiko
 Hepatitis B zuerst als Risikofaktor erkannt
Hepatitis B zuerst als Risikofaktor erkannt
 Bakterien schädigen DNA des Wirtes
Bakterien schädigen DNA des Wirtes
 Auch Jungen sollten gegen HPV geimpft werden
Auch Jungen sollten gegen HPV geimpft werden
 Daten, Zahlen und Fakten zum Krebsgeschehen in Deutschland
Daten, Zahlen und Fakten zum Krebsgeschehen in Deutschland
 Asiatische Tigermücke: Gefahr im Anflug
Asiatische Tigermücke: Gefahr im Anflug
 Gut behandelbar
Gut behandelbar
 Bereits eine ausgewachsene Plage
Bereits eine ausgewachsene Plage
 Infizierte Reiserückkehrer
Infizierte Reiserückkehrer
 Unerklärliche Fieberschübe
Unerklärliche Fieberschübe
 Tigermücke: Ausbreitung seit 1979
Tigermücke: Ausbreitung seit 1979
 Haus- und Facharztversorgung vor Ort
Haus- und Facharztversorgung vor Ort
 Wenn Partner zu Feinden werden
Wenn Partner zu Feinden werden
 Körpereigene Abwehr außer Kontrolle
Körpereigene Abwehr außer Kontrolle
 Bislang 60 Autoimmunerkrankungen bekannt
Bislang 60 Autoimmunerkrankungen bekannt
 Vorbeugung ist schwer
Vorbeugung ist schwer
 Das Verständnis fehlt
Das Verständnis fehlt
 Antibiotika-Forschung lohnt sich nicht
Antibiotika-Forschung lohnt sich nicht
Kein funktionierendes Geschäftsmodell
Kein funktionierendes Geschäftsmodell
 Tödlicher Irrtum
Tödlicher Irrtum
 Neue Anreizsysteme
Neue Anreizsysteme
 Pharmazeut:„Bakterien sind sehr erfinderisch“
Pharmazeut:„Bakterien sind sehr erfinderisch“
 Droht uns wirklich ein „postantibiotisches Zeitalter“?
Droht uns wirklich ein „postantibiotisches Zeitalter“?
 Riesiges Problem: Antibiotika in der Massentierhaltung
Riesiges Problem: Antibiotika in der Massentierhaltung
 Kennen nur einen Bruchteil der Bakterien auf der Erde
Kennen nur einen Bruchteil der Bakterien auf der Erde
 Der lange Weg zur masernfreien Zone
Der lange Weg zur masernfreien Zone
 Keine Entwarnung
Keine Entwarnung
 Furcht vor Impfschäden
Furcht vor Impfschäden
 Deutschland ist Schlusslicht
Deutschland ist Schlusslicht
 Impfpflicht wäre kontraproduktiv
Impfpflicht wäre kontraproduktiv
 Brustkrebs ist die häufigste Krebsart bei Frauen
Brustkrebs ist die häufigste Krebsart bei Frauen
 Überlebenschancen deutlich gestiegen
Überlebenschancen deutlich gestiegen
 Interdiziplinäre Planung
Interdiziplinäre Planung
 Mit dem Alter steigt das Risiko
Mit dem Alter steigt das Risiko
 Zehn Prozent genetisch bedingt
Zehn Prozent genetisch bedingt
 Von der Idee zur App auf Rezept
Von der Idee zur App auf Rezept
 Gesetzliche Regularien
Gesetzliche Regularien
 Krankenkassen fördern kaum
Krankenkassen fördern kaum
 Zertifizierung ist schwierig
Zertifizierung ist schwierig
 Hart umkämpfter Markt
Hart umkämpfter Markt
 Nachgefragt: „Die Herausforderung ist die lokale und überregionale Gesetzgebung“
Nachgefragt: „Die Herausforderung ist die lokale und überregionale Gesetzgebung“
 Notärzte brauchen oft länger als vorgeschrieben
Notärzte brauchen oft länger als vorgeschrieben
 Hilfsfrist verbessert sich leicht
Hilfsfrist verbessert sich leicht
 Keine ausgefallenen Fahrzeuge
Keine ausgefallenen Fahrzeuge
 „Essen ist längst angstbesetzt“
„Essen ist längst angstbesetzt“
 Immer für eine Provokation gut
Immer für eine Provokation gut
 Macht über andere Menschen
Macht über andere Menschen
 Pauschale Ernährungsempfehlungen sind ein Zeichen von Inkompetenz
Pauschale Ernährungsempfehlungen sind ein Zeichen von Inkompetenz
 Veganismus tritt wie eine religiöse Bewegung auf
Veganismus tritt wie eine religiöse Bewegung auf
 Formel für ein gesundes Leben
Formel für ein gesundes Leben
 Therapie mit Glauben und Globuli
Therapie mit Glauben und Globuli
 Ergänzen, nicht ersetzen
Ergänzen, nicht ersetzen
 Vorsicht vor Scharlatanen
Vorsicht vor Scharlatanen
 Forschungsdefizit beheben
Forschungsdefizit beheben
 Wenn junge Seelen leiden
Wenn junge Seelen leiden
 Trennung der Eltern ist häufigster Auslöser
Trennung der Eltern ist häufigster Auslöser
 Anzeichen ernst nehmen
Anzeichen ernst nehmen